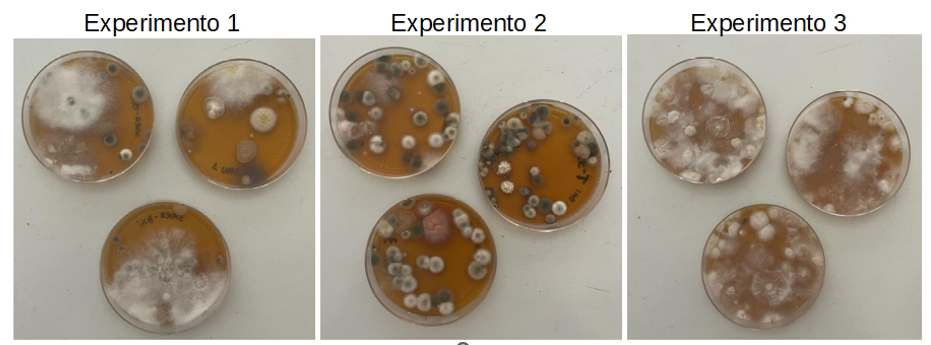
Figura_1_1C.png
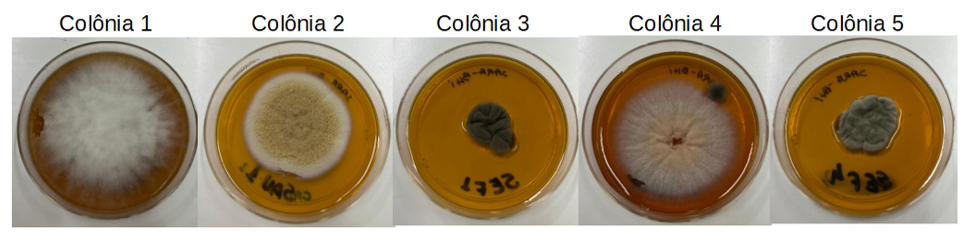
Figura_2_1C.png

O SABER 2024: revista técnico-científica / Colégio Militarde Brasília – Ano 15, nº 15 (dez. 2024). Brasília: Colégio
Militar de Brasília, 2023/2024 – 144 p.; 18x25 cm.
ISSN 1983-7658
I. Colégio Militar de Brasília.
 |
 |
|
Capa:
1Foto gentilmente cedida por Fátima Serrado. |
Expediente
Revista Técnico-Científica
Dezembro 2024
Cel QEMA Thales Mota de Alencar
Comandante e Diretor de Ensino
Cel Inf Nelson Ferreira Campos
Subdiretor de Ensino
Comissão editorial
Cel QFE Educação Leonardo Pereira Fraga
Cel R1 Fernanda Pomperek Camilo
2° Ten OTT Jéssica Carrijo de Souza
Prof. Daniel Alves de Azevedo
Arthur Almeida Oliveira
Edição e revisão
Prof. Daniel Alves de Azevedo
Cel QFE Educação Leonardo Pereira Fraga
Diagramação e projeto gráfico
Isaac Guimarães
Os autores são responsáveis pela escolha e pela apresentação das pesquisas e assuntos contidos nesta publicação, bem como por opiniões nela expressas.
Os trabalhos autorais incluídos na revista não representam posicionamento oficial por parte dos Editores ou do Colégio Militar de Brasília.
Editorial
Chegamos à XV edição da Revista Técnico-Científica O SABER do Colégio Militar de Brasília (CMB). Para nós, atuais membros da Comissão Editorial e responsáveis pela política da revista, constitui um prêmio manter o legado da pesquisa, do registro e do debate de ideias promovidos por profissionais do colégio. Profissionais que, além de todas as rotinas escolares, destinaram fração preciosa de seu tempo para eternizar – nas páginas d’O Saber – assuntos tão caros ao CMB.
Nesta coletânea de trabalhos autorais elaborados por docentes e discentes do colégio, nos anos de 2023 e 2024, apresentamos 3 artigos científicos e 7 artigos de opinião/revisão. Os trabalhos de opinião/revisão apresentam reflexões quanto às vivências escolares, em tempos de intensificação da chamada “Era Digital”, debatem iniciativas pedagógicas inovadoras, além de assuntos específicos de interesse dos autores. Os trabalhos científicos possibilitam uma imersão em áreas da Microbiologia e da biodiversidade presente na área patrimonial do colégio.
A presente edição também comemora outra data significativa para o CMB. Em janeiro de 2023, a “Jovem casa de velhas tradições” completou 45 anos desde a sua criação. Para participar dessa celebração, inserimos nas páginas da revista imagens dessas mais de quatro décadas. Essa “aventura visual” é uma oportunidade para o leitor(a) conhecer melhor e se inspirar com o colégio.
Assim, convidamos você leitor(a) para realizar um mergulho nesse mundo fascinante da educação.
Comissão Editorial


Avaliação do papel ecológico de formigas na dispersão de microrganismos ambientais
Clara Bahia Gouvêa1, Mariana Damasio Ayres Lopes1, Taila Silva de Carvalho1,
Letícia Quadros dos Santos1, Beatriz Takazaki Schneider1, Marilen Queiroz de
Souza Pereira Gomes2, Gustavo Figueiredo Marques Leite3, Lorena da Silveira
Derengowski4
RESUMO
Formigas são insetos pertencentes à ordem Hymenoptera que exercem inúmeras atividades aos ecossistemas, seja pela decomposição de substratos orgânicos, pela ciclagem de nutrientes, ou mesmo pela atividade de aeração do solo. Além disso, podem atuar como dispersores de sementes e de patógenos de plantas e animais, influenciando significativamente no equilíbrio e na saúde das populações. Nesse contexto, o objetivo deste trabalho foi verificar o papel de formigas na dispersão de microrganismos ambientais. Para tanto, fungos isolados de formigas foram cultivados in vitro e analisados quanto ao aspecto macroscópico das colônias e quanto ao tipo de hifa. Posteriormente, o DNA extraído dos fungos foi utilizado como molde para amplificação de um fragmento da região ITS do rDNA, o qual foi submetido ao sequenciamento para identificação molecular dos microrganismos. Três espécies prováveis de fungos associados a formigas foram identificadas a partir de análises de bioinformática: Fusarium oxysporum, Aspergillus westerdijkiae e Cladosporium cladosporioides. Esses fungos desempenham papel na decomposição de matéria orgânica, podendo também atuar como fitopatógenos e entomopatógenos, além de produzirem micotoxinas de relevância médica. Paralelamente, procedeu-se ao reconhecimento das formigas potencialmente dispersoras de microrganismos coletadas neste trabalho, identificando-se cinco gêneros: Atta, Pheidole, Dorymyrmex, Monomorium e Camponotus. Os resultados do presente trabalho sugerem que formigas atuam ativamente como vetores mecânicos de dispersão de diversas espécies de fungos, os quais podem interferir positiva ou negativamente nos ecossistemas.
Palavras-chave: Phoresia. Microorganismos. Formigas.
ABSTRACT
Ants are insects belonging to the order Hymenoptera performing several activities for the ecosystems, including the decomposition of organic matter, nutrients cycling and soil aeration. Furthermore, they can act as dispersers of seeds and pathogenic microorganisms, significantly influencing the balance and the health of plants and animals populations. In this context, this paper aims at verifying the role of ants in the dispersion of environmental microorganisms. To this end, fungi isolated from ants were cultivated in vitro and analyzed for the macroscopic morphology of the colonies and the type of hyphae. Subsequently, the DNA extracted from the fungi was used as a template for amplification of a fragment of the ITS (Internal Transcribed Spacer) region of rDNA, which was submitted to sequencing in order to identify the microorganisms. Three probable species of ant-associated fungi were identified by bioinformatics analysis: Fusarium oxysporum, Aspergillus westerdijkiae and Cladosporium cladosporioides. These fungi play a role in the decomposition of organic matter and can also act as phytopathogens and entomopathogens, as well as producing mycotoxins of medical relevance. At the same time, five genera of ants associated with microorganisms were identified in this work: Atta, Pheidole, Dorymyrmex, Monomorium and Camponotus. Our results suggest that ants actively act as mechanical vectors for the dispersal of several species of fungi, which can interfere positively or negatively in ecosystem interactions, as well as in agriculture and public health.
Keywords: Phoresy. Microorganisms. Ants.
INTRODUÇÃO
Com uma estimativa que supera as 1.500 espécies registradas, a riqueza de formigas no Brasil destaca a sua adaptação a uma ampla gama de ambientes, desde florestas tropicais até áreas urbanas (Santos, 2016; Feitosa et al., 2022). No Brasil, os estudos da mirmecologia iniciaram-se ainda na década de 1980 e, atualmente, o país possui o segundo maior número de publicações sobre o assunto no mundo (Santos, 2016).
As formigas, por sua diversidade e papel ecológico, desempenham funções essenciais para os ecossistemas, seja atuando como polinizadores e dispersores de sementes, ou pela decomposição de substratos orgânicos e ciclagem de nutrientes. Seu papel na decomposição de matéria orgânica, processo fundamental para a saúde e equilíbrio dos ecossistemas, é notável. Ao carregarem restos vegetais, detritos e outros materiais orgânicos para seus ninhos, elas promovem a fragmentação desses substratos, facilitando a ação de microrganismos decompositores (Dejean et al., 2023). Ainda, ao se movimentarem por diferentes ambientes, transportam consigo microrganismos, como bactérias e fungos, contribuindo para a dispersão desses agentes biológicos por áreas mais extensas e influenciando a biodiversidade microbiana nos ecossistemas (Dejean et al., 2023). Portanto, formigas exercem papel crucial na ciclagem de nutrientes, transformando resíduos orgânicos em nutrientes essenciais, enriquecendo e mantendo a fertilidade do solo e, assim, sustentando a biodiversidade e garantindo a produtividade dos ecossistemas terrestres. Por outro lado, também podem agir como veículos de dispersão de microrganismos patogênicos, podendo causar danos às lavouras e à saúde pública, acarretando prejuízos econômicos.
De modo geral, a interação entre formigas e microrganismos mostra grande complexidade, abrangendo relações mutualísticas, parasitárias ou interações casuais que podem conferir benefícios ou malefícios ao ecossistema. A relação simbiótica mantida entre microrganismos e insetos vêm sendo demonstrada em diversos estudos (Currie, 2001; Farrel et al., 2001; Paludo et al., 2018; Aanen et al., 2022; Dejean et al., 2023). A mais popular relação entre formigas e microrganismos está na fungicultura, relação simbiótica entre fungos e algumas espécies de formigas. Nessa prática, ocorre o cultivo e domesticação de um fungo pelos insetos em sua colônia, por meio do contínuo fornecimento de matéria orgânica ao microrganismo. Em contrapartida, o fungo degrada o material orgânico, produzindo nutrientes assimiláveis para as formigas (Biedermann & Vega, 2020). No Brasil, esta prática vem sendo observada entre “formigas-cortadeiras”, especificamente Atta spp. e Acromyrmex spp., e fungos da família Lepiotaceae, em um processo de coevolução estimado em aproximadamente 30 milhões de anos (Shik et al., 2016). Contudo, as associações entre esses organismos não se limitam a relações de alimentação, e formigas têm mecanismos de defesa contra patógenos, muitas vezes associados a microrganismos.
Uma faceta significativa dessas interações reside na estreita associação de determinadas espécies de formigas a bactérias que produzem substâncias antifúngicas presentes em seu exoesqueleto. Essas substâncias desempenham um papel essencial ao inibir o crescimento de organismos potencialmente prejudiciais às formigas. Essas observações evidenciam de forma clara a natureza imbricada e simbiótica das relações entre formigas e microrganismos, revelando, ao mesmo tempo, os mecanismos complexos de defesa contra patógenos, muitas vezes associados a esses microrganismos (Pagnocca et al., 2008; Dejean et al., 2023). Por outro lado, alguns fungos que parasitam formigas produzem substâncias capazes de alterar o comportamento desses insetos, controlando seus movimentos e utilizando-os como fonte de nutrientes e substrato de sustentação. Portanto, observa-se claramente a complexidade nas relações entre formigas e microrganismos e os variados mecanismos simbiontes. A compreensão desses aspectos ecológicos das formigas no Brasil não apenas destaca a biodiversidade única do país, mas também oferece dados valiosos para estratégias de manejo e conservação em ecossistemas em constante evolução (Feitosa et al., 2022).
No contexto da ecologia urbana, as formigas demonstram uma notável capacidade de se adaptar a ambientes modificados pelo homem (Bueno et al., 2017). Suas interações com o ambiente urbano incluem o forrageamento em resíduos alimentares, a construção de ninhos em espaços urbanizados e a influência na dinâmica de outros organismos (Folgarait, 1998). Além disso, as formigas urbanas podem desempenhar um papel significativo na ciclagem de nutrientes, na predação de pragas e na disseminação de patógenos, influenciando indiretamente a qualidade desses ambientes. Ainda, a presença de formigas pode determinar a disseminação de microrganismos causadores de doenças para o homem e produtores de toxinas de interesse médico. Nesse contexto, existe uma preocupação quanto às possibilidades de agravos à saúde pública que possam ser causados pela veiculação de agentes patogênicos por formigas. Isso porque formigas possuem capacidade de se deslocarem rapidamente por extensas áreas, sugerindo que, em ambientes hospitalares, podem atuar como importantes vias de dispersão de microrganismos resistentes a drogas, bem como apresentarem relação direta com infecções nosocomiais (Pereira & Bueno, 2008). Entretanto, pouco se sabe a respeito da disseminação, mediada por formigas, de fitopatógenos e microrganismos produtores de toxinas de relevância médica.
Assim, o presente estudo, desenvolvido pelo grupo de microbiologia do Clube de Estudos Ambientais do Colégio Militar de Brasília (CEA/CMB) teve como objetivo principal a ampliação do conhecimento sobre a microbiota presente no solo, bem como sobre as formigas e o papel desses animais sinantrópicos na disseminação de microrganismos decompositores e patogênicos. Esse trabalho contribui na elucidação da complexa relação existente entre formigas e microrganismos de sumo interesse para a manutenção e sustentabilidade dos ecossistemas terrestres e para a elaboração de estratégias que visem controlar a disseminação de potenciais patógenos.
MATERIAL E MÉTODOS
Este estudo foi realizado a partir de amostragens realizadas no Colégio Militar de Brasília (CMB), uma instituição de Educação Básica instalada na porção central do Distrito Federal, entre os meses de abril e maio de 2023. As formigas foram capturadas em três diferentes áreas no CMB, de forma a representar a heterogeneidade de ambientes e a diversidade de espécies. Para a captura, as formigas foram atraídas com isca de sardinha, coletadas com o auxílio de um pincel previamente esterilizado e introduzidas em placas de Petri, contendo meio de cultura BHI (Brain Heart Infusion) sólido.
Os indivíduos capturados permaneceram se movimentando em contato com o meio de cultura por cerca de 10 minutos. Posteriormente, foram coletados e armazenados em Álcool 70% para identificação. A identificação das formigas foi realizada utilizando chaves de identificação até o nível de gênero (Baccaro et al., 2015) e, posteriormente, confirmadas por especialistas. Para cada ambiente, a amostragem e inoculação dos microrganismos foi realizada em triplicata. As placas de Petri foram mantidas por 4 dias a temperatura ambiente, documentando-se o crescimento da diversidade de fungos filamentosos.
ungos que cresceram nas amostras coletadas foram isolados em placas com meio BHI (Brain-Heart Infusion). As culturas puras dos fungos estabelecidas nos meios de cultura foram, então, caracterizadas morfologicamente quanto à forma, cor e textura para identificação preliminar. Através de análise microscópica foram examinados os tipos de hifas e estruturas reprodutivas de fungos isolados, permitindo uma caracterização mais detalhada desses microrganismos.
O DNA dos fungos foi extraído, a partir das culturas puras obtidas e cultivadas em meio de cultura líquida por 5 dias sob agitação. Para a extração de DNA, foi utilizado o kit comercial Quick-DNA Fungal/Bacterial Miniprep (Zymo Research), seguindo as recomendações do fabricante. A integridade do DNA extraído foi verificada por eletroforese em gel de agarose 1% e o material foi quantificado por espectrofotometria. O DNA obtido a partir dos fungos isolados foi utilizado como molde para a amplificação da região ITS do rDNA por meio da técnica de PCR (Reação em Cadeia da Polimerase), possibilitando a obtenção de fragmentos específicos que foram posteriormente sequenciados para identificação precisa das espécies de fungos associadas às formigas. As reações de amplificação por PCR foram preparadas em duplicata com um volume final de 50 µL, contendo aproximadamente 30 ng de DNA, 0,5 µM do primer senso, 0,5 µM do primer antisenso, 200 µM dNTPs, 5 µl de 10X Taq Reaction Buffer e 2,5 U de Taq DNA polimerase (Cellco). As condições da reação de PCR foram: desnaturação inicial de 95º C por 1 minuto, seguido de 35 ciclos de 30 segundos a 95° C, 30 segundos a 55° C, 1 minuto a 72° C e uma extensão final de 2 minutos a 72° C. Após o término da reação, os amplicons foram submetidos à eletroforese em gel de agarose a 1,5%. Para o sequenciamento, os amplicons foram purificados utilizando-se o kit GFX (GE Healthcare Life Sciences), conforme as instruções do fabricante. A concentração da amostra purificada foi determinada por espectrofotometria e ajustada para 30 ng/µL. As amostras foram enviadas para a empresa ATCGenes Análises Moleculares, a qual realizou o sequenciamento.
A qualidade das sequências obtidas, a partir do sequenciamento, foi verificada usando o programa BioEdit. Posteriormente, as sequências foram comparadas com sequências previamente depositadas no banco de dados GenBank, através do programa BLASTn disponível no NCBI (www.ncbi.nlm.nih.gov).
RESULTADOS
Foram coletadas nove formigas nos locais avaliados, das quais 44,4% eram do gênero Paratrechina e 22,2% pertenciam ao gênero Atta. As demais formigas encontradas incluíam os gêneros Monomorium, Pheidole e Brachymyrmex (Tabela 1).

Visando avaliar o papel de formigas na veiculação de microrganismos ambientais, em especial fungos presentes no solo, os insetos foram atraídos e permaneceram por 10 minutos locomovendo-se sobre meio de cultura, conforme descrito na metodologia. A Figura 1 mostra a diversidade de microrganismos que cresceram no meio de cultura, após 4 dias a temperatura ambiente. Foram realizados três experimentos independentes em triplicata experimental.
Figura 1. Representação da diversidade microbiana isolada a partir da associação com formigas.
A partir de análise morfológica, cinco colônias diferentes foram escolhidas para caracterização mais precisa do fungo, sendo isoladas e cultivadas in vitro em cultura pura (Figura 2). Posteriormente, foi realizada avaliação macroscópica da colônia quanto à coloração, forma, aspecto e presença ou ausência de sulcos, e a avaliação microscópica do padrão de segmentação de hifas (Tabela 2). A análise microscópica da amostra 2 permitiu a identificação de conidióforos, as estruturas reprodutivas produtoras de esporos assexuais chamados de conídios (Figura 3). A presença de hifas septadas e conidióforos na amostra 2 são características sugestivas de que o fungo em questão pertença ao filo Ascomycota.
Figura 2. Aspecto morfológico das colônias de fungos isolados, a partir da associação com formigas, selecionados para caracterização.


Figura 3. Micrografia da estrutura reprodutiva da amostra 2.
Após a caracterização das colônias, os fungos selecionados foram cultivados em meio de cultura líquido sob agitação para posterior extração de DNA. Entretanto, não foi possível o cultivo e o repique da amostra 4, impedindo sua identificação molecular. As demais amostras tiveram o DNA genômico extraído e analisado quanto à integridade por eletroforese em gel de agarose 1% (Figura 4A). Após quantificação, o DNA genômico dos fungos em estudo foi utilizado como molde para amplificação de um fragmento da região ITS do rDNA (Figura 4B). A partir da utilização dos iniciadores ITS1F X ITS4R, o produto amplificado da região ITS gerou um fragmento de aproximadamente 650 pb para todos os isolados. Os amplicons obtidos foram purificados e quantificados por espectrofotometria, conforme descrito na metodologia. A região ITS do rDNA foi sequenciada para identificação e diferenciação dos isolados em estudo.
Figura 4. (A): Perfil eletroforético do DNA genômico extraído dos fungos isolados a partir da associação com formigas. Uma alíquota do DNA foi analisada por eletroforese em gel de agarose 1%, corado com brometo de etídeo. (B): Perfil eletroforético do produto da PCR amplificado com primers específicos para a região ITS do rDNA. Uma alíquota correspondente a 10 µL do produto da PCR foi analisada por eletroforese em gel de agarose 1,5%, corado com brometo de etídeo. Poço M: Marcador de massa molecular 1 kb Ladder. Poços 1 e 2: amostra 1. Poços 3 e 4: amostra 3. Poço 5: amostra 2. Poço 6: amostra 4.
A qualidade das sequências obtidas, a partir do sequenciamento, foi verificada utilizando-se o programa BioEdit. Posteriormente, as sequências foram submetidas a análises utilizando-se a ferramenta BLASTn. Os resultados da análise BLAST apresentaram uma identidade de 99% com relação às sequências depositadas no GenBank. A tabela 3 mostra os resultados obtidos, a partir da comparação das sequências obtidas para os fungos em estudo com sequências previamente depositadas no GenBank. As análises moleculares sugerem fortemente a identificação das espécies dos fungos isolados, a partir das formigas. As sequências obtidas neste trabalho foram submetidas ao banco de dados público de anotações de sequências de nucleotídeos (GenBank), sendo disponibilizados números de acessos para as referidas sequências (Tabela 3).

DISCUSSÃO
Os gêneros de formigas Pheidole, Brachymyrmex, Monomorium, Atta e Paratrechina desempenham papéis distintos nos ecossistemas em que estão presentes, estando comumente associados a ambientes antropizados. Formigas do gênero Pheidole, conhecidas por sua diversidade, são cosmopolitas e frequentemente observadas nos mais diversos ambientes ao redor do mundo (Bueno & Campos-Farinha, 1999; Bueno et al., 2017). São espécies onívoras e tipicamente oportunistas, beneficiando-se das condições criadas pelas alterações antrópicas (Bueno et al., 2017). Algumas espécies possuem comprovada importância na dispersão de sementes (Martins & Moreau, 2020) e estudos anteriores demonstraram sua relevância na dispersão de microrganismos em ambientes urbanos, como escolas (Carin Guarda et al., 2021) e hospitais (Campos-Farinha et al., 2002; Aquino et al., 2013). Já as formigas pertencentes ao gênero Brachymyrmex, apesar de possuírem colônias tipicamente pequenas, formadas por algumas dezenas de indivíduos, podem estabelecer-se eficientemente em diversos ambientes, sendo comumente encontradas em áreas urbanas (Lutinski et al., 2015). Essa adaptabilidade pode estar associada ao hábito alimentar onívoro da maior parte das espécies do grupo e, consequentemente, por seu sucesso em ambientes antropizados.
Monomorium é um gênero de formigas que compreende uma notável adaptabilidade, sendo classificada como praga invasora. Atualmente, Monomorium está entre os principais gêneros de formigas encontradas em áreas urbanas, estando entre os grupos comumente identificados como vetores de fungos (Lutinski et al., 2015) e de bactérias (Máximo et al., 2014), em ambientes hospitalares. Ressalta-se que, diante de toda diversidade conhecida para Formiciidae, poucas espécies apresentam o “status” de praga, isto é, que ocasionam incômodo, ferroam, causam danos em equipamentos ou veiculam patógenos em áreas como hospitais e comedouros.
As formigas do gênero Atta são conhecidas de ambientes urbanizados por conta de seus hábitos generalistas e características biológicas de pioneiras e colonizadoras (Baccaro et al., 2015; Bueno et al., 2017; Aranda et al., 2022). Juntamente com outras espécies da tribo Attini, são consideradas as principais pragas, dentre os insetos, para a agricultura neotropical. Atta sp também vem sendo registrada em ambientes hospitalares, assim como Pheidole sp. e Paratrechina sp. (Lima et al., 2013). Contudo, por sua capacidade de forragear a grandes distâncias em busca de recursos (mais de 6 km dos ninhos a depender da qualidade dos recursos disponíveis) torna a espécie um efetivo dispersor para microrganismos no ambiente (Cherrett, 1968).
Formigas pertencentes ao gênero Paratrechina, por sua vez, destacam-se pela habilidade em colonizar ambientes urbanos, aproveitando-se das oportunidades oferecidas por áreas urbanizadas. Paratrechina longicornis, por exemplo, vem sendo citada em diversos estudos dentre as espécies de formigas mais comumente identificadas em ambientes hospitalares (Zarzuela et al., 2002; Zarzuela, 2008; Máximo et al., 2014; Bueno et al., 2017), apresentando um considerável potencial como vetores de disseminação de microrganismos patogênicos, tais como clostrídios, salmonelas e micobactérias (Bueno & Campos-Farinha, 1998). Máximo e colaboradores (2014) identificaram diversos microrganismos associadas a Paratrechina sp. em ambientes hospitalares, dentre eles a bactéria Staphylococcus epidermidis, cujas infecções nosocomiais podem ocasionar condições como endocardite, infecção relacionada a cateter intravenoso, peritonite associada a cateter de diálise peritoneal, bacteremia, infecções em feridas, infecções de próteses e infecções das vias aéreas superiores (Costa et al., 2006; Konemam et al., 2008)
A capacidade das formigas em percorrerem longas distâncias é fundamental para processos ecossistêmicos como polinização, ciclagem de nutrientes e controle de pragas, contribuindo para a resiliência ecológica. No entanto, é importante compreender e monitorar essa dispersão, especialmente quando se trata do potencial transporte de microrganismos, incluindo patógenos, que podem ter implicações para a saúde humana e a biodiversidade. Nesse contexto, no presente trabalho foi possível cultivar in vitro, caracterizar morfologicamente e identificar molecularmente quatro isolados fúngicos obtidos a partir da associação com formigas. Análises de bioinformática indicam que esses isolados pertencem aos gêneros Fusarium, Aspergillus e Cladosporium.
As três espécies de fungos prováveis identificadas no presente trabalho compreendem Fusarium oxysporum, Aspergillus westerdijkiae e Cladosporium cladosporioides. Apesar de apresentarem características morfológicas distintas, tais espécies são capazes de se adaptarem a uma variedade de ambientes, incluindo solo e matéria orgânica em decomposição, e possuem importância na microbiologia ambiental e no agronegócio, podendo atuar como fitopatógenos. Nesse sentido, embora possa estar associado ao processo de decomposição da matéria orgânica e ciclagem de nutrientes, F. oxysporum também é conhecido por causar doenças vasculares em plantas, como a murcha vascular, responsável por comprometer a produção em diversas culturas economicamente relevantes, como tomates, batatas e bananas. Além disso, esse fungo é um patógeno emergente em humanos, podendo causar infecções invasivas em pacientes imunocomprometidos (Dean et al., 2012). Em contrapartida, quando associados a raízes de plantas, F. oxysporum pode atuar na proteção do hospedeiro a fitopatógenos. O mecanismo de ação de fungos endofíticos, como F. oxysporum, no biocontrole de fitopatógenos pode ocorrer de forma direta, via micoparasitismo, por antibiose ou pela competição por nutrientes, ou de forma indireta, pela indução de mecanismos de resistência na planta hospedeira (De Lamo & Takken, 2020).
Aspergillus westerdijkiae é reconhecido por sua capacidade de produzir micotoxinas, apresentando implicações na segurança alimentar e potencial aplicação em processos industriais. Em especial, essa espécie de fungo está entre as maiores produtoras de ocratoxina A, uma micotoxina comumente encontrada em alimentos e produtos agrícolas. A patogenicidade da ocratoxina A está associada a problemas neurológicos, hepáticos e renais, bem como ao seu potencial papel carcinogênico em humanos (Parussolo et al., 2019). A. westerdijkiae é também considerado um entomopatógeno, com um potencial uso desse microrganismo no controle de populações de baratas (Baggio et al., 2015).
Cladosporium cladosporioides, por sua vez, é um fungo ambiental comum, encontrado em diversos substratos e facilmente disperso pelo ar. Esse fungo pode atuar como saprófita, endofítico ou contaminante, a depender do seu substrato. Além disso, é comumente encontrado associado a frutos de cafeeiros, influenciando positivamente a qualidade do café (Francisco et al., 2022). Assim como A. westerdijkiae, C. cladosporium é um fungo entomopatogênico frequentemente utilizado no controle biológico de diversas espécies de insetos, como Bemisia tabaci (Islam et al., 2019).
Além do papel ambiental desempenhado pelas espécies identificadas nesse trabalho, vale ressaltar a relevância médica desses fungos e suas potenciais implicações para a saúde humana. Como mencionado anteriormente, algumas variantes de F. oxysporum são capazes de causar infecções em pacientes imunocomprometidos, enquanto A. westerdijkiae destaca-se na produção de micotoxinas de relevância clínica. Ademais, esporos de fungos são frequentemente associados a quadros de alergias respiratórias. Nesse contexto, embora a espécie C. cladosporioides seja comumente encontrada no ambiente, algumas cepas podem desencadear reações alérgicas em pessoas sensíveis. Portanto, a compreensão dos mecanismos de dispersão dessas espécies é essencial para monitorar e atenuar possíveis impactos à saúde humana.
CONCLUSÃO
A associação de espécies potencialmente patogênicas, como os fungos observados neste estudo, a artrópodes sinantrópicos como formigas, têm implicações significativas para a saúde ambiental e humana. O entendimento de que formigas são organismos capazes de percorrer longas distâncias carregando consigo propágulos de microrganismos sugere que a interação entre artrópodes e fungos pode não apenas favorecer a sobrevivência e propagação de diversas espécies de grande relevância médica e econômica, mas influenciar a qualidade ambiental em áreas urbanas e rurais. Ainda, por se tratarem de insetos cosmopolitas, a presença de formigas pode aumentar o potencial de exposição humana a esses fungos, com possíveis consequências quanto à saúde respiratória e segurança alimentar.
Portanto, a compreensão dessas interações não apenas é crucial para o entendimento de seus potenciais riscos, como para desenvolver estratégias de controle e prevenção, visando mitigar os efeitos adversos à saúde humana e aos ecossistemas em que esses organismos coexistem, sobretudo em ambientes mais sensíveis como hospitais e centros de armazenamentos de alimentos.
AGRADECIMENTOS
Os autores são gratos à Associação de Pais e Mestres do Colégio Militar de Brasília pelo apoio logístico para a realização deste projeto; à Dra. Patrícia Albuquerque e ao Dr Hugo Paes, da Universidade de Brasília, pela cessão de materiais e pelo uso dos laboratórios para o cultivo dos microrganismos, bem como ao Professor Henrique César Franco Taira pela revisão do abstract.
REFERÊNCIAS
AANEN, D. K.; EGGLETON, P.; ROULAND-LEFEVRE, C.; GULDBERG-FRØSLEV, T.; ROSENDAHL, S.; BOOMSMA, J. J. (2002) The evolution of fungus-growing termites and their mutualistic fungal symbionts. Proceedings of the National Academy of Sciences, v. 99, n. 23, p. 14887-14892.
AQUINO, R. S. S.; SILVEIRA, S. S.; PESSOA, W. F. B.; RODRIGUES, A.; ANDRIOLI, J. L.; DELABIE, J. H. C.; FONTANA, R. (2013) Filamentous fungi vectored by ants (Hymenoptera: Formicidae) in a public hospital in north-eastern Brazil. Journal of Hospital Infection, v. 83, n. 3, p. 200-204.
ARANDA, R.; TIBCHERANI, M.; NACAGAVA, V. A. F.; DE CARVALHO, S. S.; DE SOUZA, P. R. (2022) The role of urban savannah fragments and their characteristics for the conservation of ants (Hymenoptera: Formicidae) in central Brazil. Community Ecology, v. 23, n. 1, p. 115-127.
BACCARO, B. F.; FEITOSA, R. M.; FERNANDEZ, F.; FERNANDES, I. O.; IZZO, T. J.; SOUZA, J. L. P.; SOLAR, R. (2015) Guia para os gêneros de formigas do Brasil. Manaus: Editora INPA, 388p.
BAGGIO, M. V.; FERREIRA, M. D. C.; MONTEIRO, A. C.; MALDONADO JUNIOR, W.; LEMOS, M. V. F. (2015) Pathogenicity of Aspergillus westerdijkiae to females and oothecae of Periplaneta americana. Ciência Rural, v. 46, p. 20-25.
BIEDERMANN, P. H.; VEGA, F. E. (2020) Ecology and evolution of insect–fungus mutualisms. Annual Review of Entomology, v. 65, p. 431-455.
BUENO, O.C.; CAMPOS-FARINHA, A. E. C. (1999) As formigas domésticas. In: MARICONI, F. A. M. (Ed.), Insetos e Outros Invasores de Residências. Piracicaba: FEALQ, p.135-180.
BUENO, O. C.; CAMPOS, A. E. C.; MORIN, M. S. C. (2017) Formigas em ambientes urbanos no Brasil. Bauru: Canal 6, 685p.
BUENO, O. C.; CAMPOS-FARINHA, A. D. C. (1998) Formigas urbanas: comportamento das espécies que invadem as cidades brasileiras. Vetores & Pragas, v. 1, n. 2, p. 602-607.
CAMPOS-FARINHA, A. E. C.; BUENO, O. C.; CAMPOS, M. C. G.; KATO, L. M. (2002) As formigas urbanas no Brasil: retrospecto. Arquivos do Instituto Biológico, v. 64, p. 129-133.
CHERRETT, J. M. (1968) The foraging behaviour of Atta cephalotes: 1. Foraging pattern and plant species attacked in tropical rain forest. Journal of Animal Ecology, v. 37, p. 387-403.
COSTA, S. B.; PELLI, A., CARVALHO, G. P.; OLIVEIRA, A. G.; SILVA, P. R.; TEIXEIRA, M. M.; MARTINS, E.; TERRA, A. P. S.; RESENDE, E. M.; OLIVEIRA, C. C. H. B.; MORAIS, C. A. (2006) Formigas como vetores mecânicos de microrganismos no Hospital Escola da Universidade Federal do Triângulo Mineiro. Revista da Sociedade Brasileira de Medicina Tropical, v. 39, p. 527-529.
CURRIE, C. R. (2001) A community of ants, fungi, and bacteria: A multilateral approach to studying symbiosis. Annual Review of Microbiology, v. 55, p. 357-80.
DE LAMO, F. J.; TAKKEN, F. L. (2020) Biocontrol by Fusarium oxysporum using endophyte-mediated resistance. Frontiers in Plant Science, v. 11, p. 37.
DEAN, R.; VAN KAN, J. A.; PRETORIUS, Z. A.; HAMMOND‐KOSACK, K. E.; DI PIETRO, A., SPANU, P. D.; ... FOSTER, G. D. (2012) The Top 10 fungal pathogens in molecular plant pathology. Molecular plant pathology, v. 13, n. 4, p. 414-430.
DEJEAN, A.; AZÉMAR, F.; NASKRECKI, P.; TINDO, M.; ROSSI, V.; FAUCHER, C.; GRYTA, H. (2023) Mutualistic interactions between ants and fungi: A review. Ecology and Evolution, v. 13, n. 8, e10386.
FARRELL, B. D.; SEQUEIRA, A. S.; O'MEARA, B. C.; NORMARK, B. B.; CHUNG, J. H., JORDAL, B. H. (2001) The evolution of agriculture in beetles (Curculionidae: Scolytinae and Platypodinae). Evolution, v. 55, n. 10, p. 2011-2027.
FEITOSA, R. M.; CAMACHO, G. P.; SILVA, T. S.; ULYSSÉA, M. A.; LADINO, N.; OLIVEIRA, A. M.; ... DAROCHA, W. (2022) Ants of Brazil: an overview based on 50 years of diversity studies. Systematics and Biodiversity, v. 20, n. 1, p. 1-27.
FOLGARAIT, P. J. (1998) Ant biodiversity and its relationship to ecosystem functioning: a review. Biodiversity & Conservation, v. 7, p. 1221-1244.
FRANCISCO, K. C. P.; DE MELO, B. M. R.; FERREIRA, S.; DOS SANTOS, T. M.; SOUZA, V. M., LEME, R. L. S. (2022) Coffee quality at different maturation stages, due to the application of Cladosporium cladosporioides. Nativa, v. 10, n. 3, p. 351-355.
GUARDA, C.; LUTINSKI, J. A.; TEO, C. R.; BUSATO, M. A. (2021) Ants (Hymenoptera: Formicine) as Carriers of Microorganisms Indicating Hygienic and Sanitary Conditions in Urban Schools. Anais da Academia Brasileira de Ciências, v. 93.
ISLAM, T.; GUPTA, D. R.; SUROVY, M. Z.; MAHMUD, N. U.; MAZLAN, N.; ISLAM, T. (2019) Identification and application of a fungal biocontrol agent Cladosporium cladosporioides against Bemisia tabaci. Biotechnology & Biotechnological Equipment, v. 33, n. 1, p. 1698-1705.
KONEMAM, E. W.; ALLEN, S. D.; JANDA, W. M.; PROCOP, G. W.; SCHRECKENBERGER, P. C.; WOODS, G. L. (2008) Diagnóstico Microbiológico. 6ª ed. - Rio de Janeiro: Guanabara Koogan.
LIMA, W. R. D. S.; MARQUES, S. G.; RODRIGUES, F. S.; REBÊLO, J. M. M. (2013) Ants in a hospital environment and their potential as mechanical bacterial vectors. Revista da Sociedade Brasileira de Medicina Tropical, v. 46, p. 637-640.
LUTINSKI, J. A.; AHLERT, C. C.; DE FREITAS, B. R.; TRAUTMANN, M. M.; TANCREDO, S. P.; MELLO GARCIA, F. R. (2015) Ants (Hymenoptera: Formicidae) in hospitals of southern Brazil. Revista Colombiana de Entomología, v. 41, n. 2, p. 235-240.
MARTINS, C.; MOREAU, C. S. (2020) Influence of host phylogeny, geographical location and seed harvesting diet on the bacterial community of globally distributed Pheidole ants. PeerJ, v. 8, e8492.
MATTOS, M.L.T. (2015) Microbiologia do Solo. Editora Cubo, p. 250-272.
MÁXIMO, H. J.; FELIZATTI, H. L.; CECCATO, M.; CINTRA-SOCOLOWSKI, P.; ZENI BERETTA, A. L. R. (2014) Ants as vectors of pathogenic microorganisms in a hospital in São Paulo county, Brazil. BMC Research Notes, v. 7, p. 1-5.
PAGNOCCA, F. C.; RODRIGUES, A.; NAGAMOTO, N. S.; BACCI, M. (2008) Yeasts and filamentous fungi carried by the gynes of leaf-cutting ants. Antonie van Leeuwenhoek, v. 94, p. 517-526.
PALUDO, C. R.; MENEZES, C.; SILVA-JUNIOR, E. A.; VOLLET-NETO, A.; ANDRADE-DOMINGUEZ, A.; PISHCHANY, G.; ... PUPO, M. T. (2018) Stingless bee larvae require fungal steroid to pupate. Scientific reports, v. 8, n. 1, p. 1122.
PARUSSOLO, G.; OLIVEIRA, M. S.; GARCIA, M. V.; BERNARDI, A. O.; LEMOS, J. G.; STEFANELLO, A.; ... COPETTI, M. V. (2019) Ochratoxin A production by Aspergillus westerdijkiae in Italian-type salami. Food microbiology, v. 83, p. 134-140.
PEREIRA, R. D. S.; UENO, M. (2008) Formigas como veiculadoras de microrganismos em ambiente hospitalar. Revista da Sociedade Brasileira de Medicina Tropical, v. 41, p. 492-495.
SANTOS, M. N. (2016). Research on urban ants: approaches and gaps. Insectes Sociaux, v. 63, n. 3, p. 359-371.
SHIK, J. Z.; GOMEZ, E. B.; KOOIJ, P. W.; SANTOS, J. C.; WCISLO, W. T.; BOOMSMA, J. J. (2016) Nutrition mediates the expression of cultivar-farmer conflict in a fungus-growing ant. Proceedings of the National Academy of Sciences, v. 113, n. 36, p. 10121-10126.
ZARZUELA, M. F. M.; RIBEIRO, M. C. C.; CAMPOS-FARINHA, A. E. C. (2002) Distribuição de formigas urbanas em um hospital da região sudeste do Brasil. Arquivos do Instituto Biológico, v. 69, n. 1, p. 85-87.
ZARZUELA, M. F. M. (2008) Formigas em hospital. Vetores e Pragas, v. 11, n. 20, p. 20-23.
_______________________________________________
1 Aluno(a) do Colégio Militar de Brasília (CMB).
2 Professora de Ciências Naturais (CMB), Doutora em Ciências Médicas (UnB).
3 Professor de Biologia (CMB), Orientador do Clube de Estudos Ambientais (CEA), Doutor em Ecologia (UnB).
4 Professora de Biologia (CMB), Orientadora do Clube de Estudos Ambientais (CEA), Doutora em Biologia Molecular (UnB). Email:

Diversidade arbórea no Colégio Militar de Brasília
Pedro Souza Berbert1
RESUMO
O Cerrado é um tipo de vegetação que ocorre no Brasil Central, o segundo maior bioma brasileiro, contudo, são poucos os registros disponíveis sobre a distribuição da vegetação nativa que recobria esta região, a qual vem sofrendo alterações e perdendo suas características naturais. O presente estudo teve por objetivo realizar o levantamento florístico da vegetação lenhosa, no Colégio Militar de Brasília. Para tanto foi feito um levantamento florístico das espécies arbóreas por meio do método de censo. Foram identificadas, durante o levantamento, 32 espécies divididas em 15 famílias. As famílias com maior riqueza foram Fabaceae e Anacardiaceae. Destas, 67% das espécies registradas foram árvores nativas brasileiras, sendo a maior parte típicas do bioma Cerrado. Conclui-se que, embora isolado e sofrendo efeitos da ação antrópica, o fragmento do colégio possui uma boa cobertura vegetal composta de um mosaico de espécies exóticas e nativas.
Palavra-chaves: Cerrado. Brasília. Levantamento florístico. Educação Ambiental.
ABSTRACT
The Cerrado is a type of vegetation that occurs in Central Brazil, the second largest Brazilian biome. However, there are few records available on the distribution of the native vegetation that used to cover this region, which has been undergoing changes and losing its natural characteristics. The present study aimed to carry out a floristic survey of the woody vegetation in the Military School of Brasília. For this purpose, a floristic survey of tree species was carried out using the census method. 32 species were identified during the survey, divided into 15 families. The richest families were Fabaceae and Anacardiaceae. From these, 67% of the recorded species were native Brazilian trees, with the majority being typical of the Cerrado biome. It can be concluded that, although isolated and suffering the effects of human action, the fragment has a good vegetation cover composed of a mosaic of exotic and native species.
Keywords: Cerrado. Brasília. Floristic description. Environmental education.
INTRODUÇÃO
O Cerrado é o segundo maior bioma brasileiro, ocupando 22% do território nacional (Sano et al., 2008). No Brasil estende-se por 10 estados e pelo Distrito Federal, ocupando uma área de aproximadamente dois milhões de km², o que corresponde a quase um quarto da superfície do país. Segundo Bizerril (2004), o Cerrado é uma extensa planície de savana tropical, localizado na porção central da América do Sul, com árvores intercaladas por uma vegetação arbórea, podendo ser também descrito como um complexo vegetacional, com os estratos o herbáceo, arbustivo e arbóreo facilmente distinguíveis (Eiten, 2001).
Apesar da relevância territorial, Mitermeier e colaboradores (1999) estimaram que apenas 33% da área do Cerrado encontra-se em seu estado original. Ainda assim, mesmo as áreas ainda cobertas de paisagem natural sofrem os efeitos da degradação antrópica (Reatto et al., 2008). Diante disso, a necessidade de se conhecer mais sobre o bioma torna-se cada vez mais essencial. Na região central do país, a ocupação do Cerrado foi incentivada pela construção da Capital Federal, pela malha rodoviária do Centro-Oeste, por incentivos fiscais e pela criação de modelos de desenvolvimento agrário que proporcionaram o avanço da fronteira agrícola (Duarte, 2002; Mourão & Da Silva Lino, 2021).
Extensa literatura refere-se à modificação do Cerrado e, por consequência, à sua fragmentação e redução da biodiversidade. Nesse sentido, qualquer área minimamente preservada do bioma merece atenção especial, pois, além de serem mais vulneráveis aos eventos naturais, também estão mais susceptíveis à ação antrópica. Dessa forma, torna-se urgente a necessidade de se avaliar sua diversidade biológica, bem como compreender a organização espacial da comunidade de plantas no seu interior, permitindo traçar práticas de manejo com vistas à conservação de sua diversidade biológica (Sciamarelli, 2005).
Estudos recentes vêm indicando que mesmo fragmentos urbanos são relevantes pontos a serem estudados quanto à diversidade. Segundo Collins e colaboradores (2021), dada a redução de áreas preservadas e influência das ações humanas sobre a composição das espécies locais, os ecossistemas urbanos vêm se convertendo em redutos ecológicos relevantes e com expressiva biodiversidade. Para a diversidade florística, esta não é uma realidade diferente, uma vez que a construção das cidades, por vezes, considera a manutenção de parte da vegetação original das áreas, o que cria ambientes complexos devido à heterogeneidade de espécies e habitats. Dessa forma, muitos centros urbanos acabam abrigando relevante diversidade florística.
A construção de Brasília, a capital do Brasil, foi idealizada pelo presidente Juscelino Kubitschek, com autoria do arquiteto Lúcio Costa responsável pelo plano urbanístico. Em sua essência tinha como objetivo transferir a capital do país para o interior e em seu projeto a intenção de construir uma cidade ricamente arborizada (Pinto, 2018). Apesar de ser reconhecida pelos seus espaços verdes, em diversos pontos da capital, e ter grande parte de seu território em unidades de conservação, a concepção de Brasília não considerou a conservação da vegetação nativa durante sua construção. Nesse sentido, coube à Companhia Urbanizadora da Nova Capital do Brasil (Novacap) revegetar as áreas verdes, plantando árvores e arbustos por toda sua extensão (Pinto, 2018). O resultado está na dominância de espécies exóticas, na atual composição de espécies vegetais por toda a capital, apesar de existirem fragmentos remanescentes de Cerrado e, ainda, uma grande diversidade de espécies nativas distribuídas na matriz urbana.
Com a construção de Brasília e a transferência de militares para a Capital da República, tornou-se necessária a instalação do primeiro colégio militar da capital, o Colégio Militar de Brasília (CMB) (Moreira, 2020). Desta forma, em 1º de setembro de 1978, foi criado o CMB que abriga, em suas instalações, um efetivo aproximado de 3.100 alunos, distribuídos em cerca de 100 salas de aula. Refletindo a construção de Brasília, a instalação do CMB, também, decorreu da supressão da vegetação da área, a qual, ao longo dos anos, tentou-se reinserir na paisagem do colégio, por meio sobretudo de projetos voltados à Educação Ambiental dos alunos. Dessa forma, a própria área de convivência dos alunos torna-se ponto de Educação Ambiental das crianças e adolescentes que percorrem os ambientes do colégio, permitindo uma aprendizagem ativa de diversos conteúdos abordados durante o ensino formal e não-formal (Fraga et al., 2019). Nesse sentido, o presente trabalho visou realizar o levantamento florístico da vegetação lenhosa do CMB, a fim de criar subsídios para incentivar a Educação Ambiental e planejar estratégias para o reflorestamento utilizando espécies nativas do Cerrado.
MATERIAL E MÉTODOS
O CMB está situado no centro de Brasília entre as latitudes -15.78310, -47.89136 Sul e longitude -15.77634, -47.89453 Oeste. Ocupa uma área de 24 ha, o equivalente a três superquadras do Plano Piloto de Brasília (Magalhães, 2009; Figura 1). Da sua área total, 60.000 m2 são estruturas físicas (Felix, 2011) e uma grande porção, retirando-se os estacionamentos e pátios de formatura, é arborizada. O clima na região pode ser classificado como Aw (Tropical de savana) segundo Köppen, com a precipitação média anual excedendo os 1500 mm e 1.108 m acima do nível do mar.

Figura 1. Localização do Colégio Militar de Brasília (CMB), Brasília-DF.
Para o levantamento botânico, foram delimitados módulos dentro do colégio, de modo a facilitar a identificação de cada área específica. Em cada região foram nomeadas e catalogadas as árvores que possuíam o diâmetro acima do peito (DAP) ≥ 20 cm a 30 cm do solo. Para avaliar a composição florística da vegetação, foram realizados levantamentos por meio do método de Censo comum e, para nomenclatura botânica, utilizaram-se como referências os sistemas APG II (2009) e APG III (2016). O censo florístico é adotado em pequenas áreas ou onde há a necessidade de se conhecer cada indivíduo. Usualmente é utilizado quando se quer calcular e realizar manejos que não podem conter erro amostral.
A coleta de dados foi realizada por estudantes do Ensino Médio do CMB, especificamente participantes do projeto de pesquisa em Botânica, do Clube de Estudos Ambientais, durante o ano de 2023. O Clube de Estudos Ambientais do CMB foi organizado em 2015, desenvolvendo atividades de caráter teórico-prático, sempre visando à iniciação científica, à produção e à divulgação de conteúdos e informações pelos estudantes (Silva & Fraga, 2018). Desde a sua criação, suas atividades pedagógicas são voltadas para a Educação Ambiental (não-formal), em consonância com a Portaria nº 001-DECEx, de 31 de janeiro de 2019.
RESULTADOS E DISCUSSÃO
Ao total foram identificadas 32 espécies no CMB, pertencentes a 15 famílias (Tabela I). A família mais rica foi Fabaceae, com nove espécies representando 28% seguida por Anacardiaceae (N=4) representando 12,5%, Arecaceae (N=3) e Bignoniaceae (N=3) com 9,37% cada. Estudos realizados em áreas urbanas vêm corroborando a dominância de Fabaceae, com maior representatividade na composição dentre as espécies lenhosas registradas (Zea et al., 2016; Rodrigues & Copatti, 2009; Brum, 2023; Lara et al., 2014). Esse padrão pode estar relacionado à maior diversidade de Fabaceae em relação às demais famílias botânicas identificadas. Fabaceae é considerada a terceira maior família dentre angiospermas, com cerca de 2100 espécies e 188 gêneros amplamente distribuídos no território brasileiro (Lima, 2000; Souza & Lorenzi, 2005).
Tabela I: Lista das espécies arbóreas, em ordem alfabética para nome popular, amostradas no Colégio Militar de Brasília.

A área estudada apresentou baixa riqueza de espécies quando comparada com outros levantamentos florísticos para fragmentos florestais do bioma Cerrado (Passos et al., 2008; Kurihara et al., 2005). Por outro lado, apresentou elevada diversidade se comparada a regiões urbanizadas e de área amostral equivalente, tanto para o bioma Cerrado (Brum, 2023) quanto para outros biomas, como Caatinga (Zea et al., 2016), Mata Atlântica e Pampa (Rodrigues & Copatti, 2009). Entretanto, estudos censitários em áreas urbanas tendem a apresentar maior diversidade do que a observada no CMB quando áreas maiores são inventariadas. Por exemplo, Lara e colaboradores (2014) realizaram censo de espécies arbóreas em vias públicas da cidade de Israelândia-GO, bioma Cerrado, e identificaram 58 espécies, das quais 19 são exóticas e 39 são nativas. Ainda, Pinheiro e colaboradores (2020) registraram 200 espécies arbóreas, pertencentes a 47 famílias botânicas em levantamento realizado nas quadras urbanizadas em Palmas - TO. Isso demonstra que, apesar da baixa representatividade de espécies em áreas urbanizadas, maior diversidade pode ser revelada com o incremento da área amostral em censos botânicos, sugerindo que centros urbanos podem ainda apresentar potencial de manutenção de espécies arbóreas.

Figura 2. Riqueza de espécies arbóreas, por família botânica, registrada no Colégio Militar de Brasília, Brasília-DF, no ano de 2023.
De forma contrária ao observado em estudos anteriores, a maior parte das espécies registradas no CMB foram de espécies nativas do bioma Cerrado. Apenas 37% das espécies identificadas na área amostrada são exóticas, sendo a mangueira (Mangifera indica) a espécie dominante neste grupo e, ainda, da família Fabaceae o maior número de representantes. Composição contrária foi observada no estudo de Brum (2023) na cidade de Serra Dourada - BA, bioma Cerrado, com 67% de espécies exóticas e apenas 33% de espécies nativas. Segundo Costa-Lima & Silva-Júnior (2010), grande parte das árvores nativas em Brasília foram substituídas por espécies exóticas ainda nos primeiros plantios, durante a construção da cidade. A perda de cobertura vegetal nativa e da estrutura e composição florísticas, devido à urbanização, acarretou diversas mudanças para a fitofisionomia original e, consequentemente, para a biodiversidade existente (Cerqueira et al., 2022). Mesmo dentre as espécies nativas registradas no CMB, a vegetação amostrada é composta, na maior parte, por espécies utilizadas em projetos de arborização e ornamentação (como os ipês e o mogno-brasileiro).
Apesar da reduzida área amostral e da interferência antrópica na composição das espécies arbóreas, o CMB apresenta-se, ainda, como um ambiente com elevada diversidade de espécies nativas. Deste ponto, revela-se como um importante fragmento de vegetação a ser preservado, uma vez que pode atuar como significativo refúgio para fauna silvestre. Mousinho et al. (2022) registraram cerca de 50 espécies de aves que utilizam as áreas do CMB como refúgio ou para forrageio. Segundo os autores, a elevada diversidade de aves se deve, sobretudo, à presença de espécies arbóreas nativas e à baixa interferência humana, tornando o colégio uma área de elevada qualidade ambiental, inclusive para espécies sensíveis, como o Chibum (Elaenia chiriquensis) e como sítio reprodutivo para espécies migratórias, como a Tesourinha (Tyrannus savana).
Neste estudo não foi possível o reconhecimento de duas espécies arbóreas durante o levantamento. Estas espécies foram coletadas e levadas ao Herbário do Jardim Botânico de Brasília para identificação. Ainda, placas com a identificação das espécies serão produzidas e instaladas para serem utilizadas como ferramenta de Educação Ambiental.
CONCLUSÃO
A escassa diversidade de espécies é característica típica do processo de reflorestamento realizado em ambientes urbanos e indica a ausência de um planejamento adequado no processo de arborização. Por outro lado, apesar da clara interferência na composição, as espécies, a gestão e plantio de espécies arbóreas no CMB vem mostrando ter sido capaz de manter uma elevada diversidade botânica na área do colégio, tornando-o um ambiente de maior qualidade ambiental quando comparado a outros fragmentos de vegetação, em centros urbanos brasileiros. A elevada frequência de espécies nativas sinaliza uma valorização da flora, o que, por sua vez, pode refletir nas atitudes em relação à preservação ou à devastação da vegetação do Cerrado pelos estudantes que transitam nas áreas do CMB.
Não obstante, aulas tradicionais expositivas são de longe as mais utilizadas pelos professores dentro do ensino de Ciências Naturais e Biologia, entretanto existe um esforço em diversificar as metodologias de ensino e melhorar o aprendizado sobre assuntos relacionados ao meio ambiente. Os alunos do CMB têm disponível como atividades extracurriculares o Clube de Estudo Ambientais onde ocorrem aulas práticas de laboratório, atividades e oficinas. O trabalho de identificação das espécies arbóreas favorece condições para outros projetos de Educação Ambiental e ainda poderá nortear um futuro processo de restauração utilizando espécies nativas
REFERÊNCIAS
BIZERRIL, M. (2004) Vivendo no cerrado e aprendendo com ele. Brasília: Saraiva, 77p.
BRUM, D. L. O. (2003) Diversidade e quantitativo de espécies arbóreas na cidade de Serra Dourado-BA. Trabalho de Conclusão de Curso (Especialização em Arborização Urbana) - Universidade Federal Rural do Rio de Janeiro. Seropédica, 27p.
CERQUEIRA, L. H. A.; OLIVEIRA, L. V. C.; SOUSA, R. N. (2022) A urbanização de Brasília e seus impactos sobre a fitofisionomia original: uma análise temporal da fragmentação de três áreas localizadas na porção norte do plano piloto. Trabalho de Conclusão de Curso (Bacharelado em Ciências Ambientais) - Universidade de Brasília. Brasília, 49p.
COLLINS, M. K.; MAGLE, S. B.; GALLO, T. (2021) Global trends in urban wildlife ecology and conservation. Biological Conservation, v. 261, 109236.
COSTA E LIMA, R. M.; SILVA JÚNIOR, M. C. (2010) Inventário da arborização urbana implantada na década de 60 no Plano Piloto, Brasília, DF. Revista da Sociedade Brasileira de Arborização Urbana, v. 5, n. 4, p.110-127.
DUARTE, L. M. G. (2002) O desenvolvimento sustentável: um olhar sobre os cerrados brasileiros. In: DUARTE, L. M. G.; THEODORO, S. H. (Orgs). Dilemas do cerrado: entre o ecologicamente (in)correto e o socialmente (in)justo. Rio de Janeiro: GARAMOND, 239p.
EITEN, G. (2001) Vegetação Natural do Distrito Federal. Brasília: SEBRAE/DF, 162p.
FRAGA, L. P.; DEMO, C.; GONÇALVES, R. L. R.; FREITAS, T. A. S.; SÁ, M. F. (2019) Trilha do Cerrado: local de aprendizado prático no ambiente escolar. O Saber, v. 12, p. 108-119.
KURIHARA, D. L.; IMAÑA-ENCINAS, J.; PAULA, J. E. (2005) Levantamento da arborização do campus da Universidade de Brasília. CERNE, v. 11, n. 2, p. 127-136.
LARA, J. S.; CARNEIRO, F. M. (2014) Diagnóstico da composição arbórea da cidade de Israelândia-GO, Brasil. Revista da Sociedade Brasileira de Arborização Urbana, v. 9, n. 2, p. 134-147.
LIMA, H. C. (2000) Leguminosas arbóreas da Mata Atlântica - uma análise da riqueza, padrões de distribuição geográfica e similaridades florísticas em remanescentes florestais do estado do Rio de Janeiro. Tese (Doutorado em Ecologia) - Universidade Federal do Rio de Janeiro. Rio de Janeiro, 122p.
MAGALHÃES C. H. (2009) Os blocos de superquadra: um tipo da modernidade. MDC. Revista de arquitetura e urbanismo. Disponível em:<https://mdc.arq.br/2009/06/02/os blocos de superquadra um tipo da modernidade> Acesso em: 27 nov. 2023.
MITERMEIER, N.; MYERS, R. A.; MITERMEIER, C. G.; ROBLES GIL, P. (1999) Hotspots: Earth’s biologically richest and most endangered terrestrial ecoregion. Mexico City: CEMEX, 431p.
MOREIRA, A. M. (2020) Acessibilidade arquitetônica no Colégio Militar de Brasília: problemas estruturais e organizacionais. Trabalho de Conclusão de Curso (Especialização em Gestão, Assessoramento e Estado-Maior) - Escola de Saúde e Formação Complementar do Exército, Salvador, 15p.
MOUSINHO, F. L. B.; SILVA, R. A.; JANTSCH, G. S. K.; BARROCAS, M. A.; CORRÊA, L. G; SOUZA, G. F; DE SOUZA, A. A. G.; FRAGA, L. P.; LEITE, G. F. M. (2022) Diversidade de aves do Colégio Militar de Brasília, Distrito Federal. O Saber, v. 14, p. 39-55
MOURÃO, R.; DA SILVA LINO, E. N. (2021) Expansão agrícola no cerrado: o desenvolvimento do agronegócio no estado de Goiás entre 2000 a 2019. Caminhos de Geografia, v. 22, n. 79, p. 1-17.
PASSOS, F. B.; CORREIA, C. A. S.; PROENÇA, C. E. B. (2008) Levantamento florístico do parque de uso múltiplo das sucupiras, Brasília, DF, Brasil, Revista Heringeriana, v. 2, n. 1, p. 61-79.
PINHEIRO, R. T.; MARCELINO, D. G.; MOURA, D. R. (2020) Composição e diversidade arbórea nas quadras urbanizadas de Palmas, Tocantins. Ciência Florestal, v. 30, p. 565-582.
PINTO, M. S. (2018) O desafio da floresta urbana: história do processo de arborização de Brasília (1960-1970). Dissertação (Mestrado em História) - Universidade de Brasília. Brasília, 127f.
REATTO, A.; CORREIA, J. R.; SPERA, S.T. MARTINS, E. S. (2008) Solos do bioma Cerrado: aspectos pedológicos. In: SANO, S. M; ALMEIDA, S. P.; RIBEIRO, J. F. (Org). Cerrado Ecologia e Flora. Planaltina: Embrapa-CPAC, p.107-134.
RODRIGUES, L. S.; COPATTI, C. E. (2009) Diversidade arbórea das escolas da área urbana de São Vicente do Sul-RS. Biodiversidade Pampeana, v. 7, n. 1, p. 7-12.
SANO, S. M.; ALMEIDA, S. P.; RIBEIRO, J. F. (2008) Cerrado: ecologia e flora (Vol. 1). Embrapa Cerrados. Brasília-DF: Embrapa Informação Tecnológica.
SCIAMARELLI, A. (2005) Estudo florístico e fitossociológico da “Mata de Dourado” fazenda Paradouro, Dourados, Mato Grosso do Sul, Brasil. Tese (Doutorado em Biologia Vegetal) - Universidade Estadual de Campinas. Campinas.
SILVA, A. S.; FRAGA, L. P. (2018) A Educação Ambiental no Colégio Militar de Brasília: referenciais e práxis pedagógicos do Clube de Estudos Ambientais. O Saber, v. 11, p. 161-175.
SOUZA, V. C.; LORENZI, H. (2005) Botânica sistemática: guia ilustrado para identificação das famílias de angiospermas da flora brasileira, baseado em APG II. Nova Odessa: Instituto Plantarum, 640p.
ZEA, J. D.; ZEA C.; BARROSO, R. F.; SOUTO, P. C.; SOUTO, J. S. (2016) Levantamento e diversidade da arborização urbana de Santa Helena, no semiárido da Paraíba. Agropecuária Científica no Semiárido, v. 11, n. 4, p. 53-62.
_______________________________________________
1Professor de Biologia (CMB), Doutor em Biologia Molecular (UnB). Email:

Desenvolvimento de marcadores microssatélites para análises de diversidade genética em espécies de Philodendron (Araceae)
Rômulo da Fonsêca dos Santos1
RESUMO
Philodendron é um dos gêneros neotropicais mais importantes da família Araceae, tanto pela sua representatividade em número de espécies quanto pelo seu destaque na floricultura. Considerando que o êxito na conservação das espécies vegetais de importância ecológica e econômica depende da manutenção de sua diversidade genética e que esta informação não se encontra disponível para a maioria das espécies da família Araceae, o presente estudo teve como objetivo desenvolver marcadores moleculares microssatélites (SSR) para P. solimoesense e determinar o potencial de transferibilidade em P. goeldii, P. leal-costae e P. venezuelense. Para tal, foi construída uma biblioteca de SSR nucleares, obtida por meio de sequenciamento shotgun do DNA genômico de P. solimoesense em um sequenciador Roche 454 GSFLX. A ocorrência e as frequências dos SSRs foram determinadas utilizando-se o software SciRoKo. Um total de 2.299 loci de SSR foram encontrados, dos quais 1.168 contêm motivos SSR aptos para serem utilizados no desenho de primers, constituindo mais de 50% de todas as regiões observadas. Destas, as 28 regiões contendo os maiores números de repetições foram selecionadas para o desenvolvimento dos marcadores a partir da ferramenta WebSat. Os testes de amplificação dos 28 marcadores via PCR de gradiente usando diferentes temperaturas de anelamento, e a análise por eletroforese em gel de agarose 1,8% foram bem-sucedidos. Para análise de polimorfismo e transferibilidade, foram selecionados 8 marcadores que amplificaram na temperatura de 58 ºC (Psol-0197, Psol-1036, Psol-0781, Psol-0313, Psol-0909, Psol-0116, Psol-0101, Psol-0398). Todos os primers desenvolvidos para P. solimoesense amplificaram fragmentos em P. goeldii, demonstrando um percentual de 100% de transferibilidade. Observou-se um percentual de amplificação cruzada de 75% em P. venezuelense e 50% em P. leal-costae. Os resultados mostraram que os primers desenvolvidos para identificar locos de SSR polimórficos em populações de P. solimoesense apresentaram porcentagem considerável de amplificação cruzada.
Palavras-chave: SSR. Floresta Amazônica. Mata Atlântica. Diversidade genética.
ABSTRACT
Philodendron is one of the most important neotropical genera of the Araceae family, both for its representativeness in number of species and for its prominence in floriculture. Considering that the success in the conservation of plant species of ecological and economical importance depends on the maintenance of their genetic diversity and that this information is not available for most species in the Araceae family, the present study aimed to develop microsatellite molecular markers (SSR ) for P. solimoesense and determine the transferability potential in P. goeldii, P. leal-costae and P. venezuelense. To do so, a nuclear SSR library was produced, obtained through shotgun sequencing of P. solimoesense genomic DNA on a Roche 454 GSFLX sequencer. The occurrence and frequencies of SSRs were determined using the SciRoKo software. A total of 2,299 SSR loci were found, of which 1,168 contain SSR patterns suitable to be used in primer design, constituting more than 50% of all regions observed. From this number, the 28 regions containing the highest number of repetitions were selected for the development of markers using the WebSat tool. Amplification tests of the 28 markers via gradient PCR using different annealing temperatures, and analysis by electrophoresis in 1.8% agarose gel were successful. For polymorphism and transferability analysis, 8 markers that amplified at a temperature of 58 ºC were selected (Psol-0197, Psol-1036, Psol-0781, Psol-0313, Psol-0909, Psol-0116, Psol-0101, Psol-0398 ). All the primers developed for P. solimoesense amplified fragments in P. goeldii, demonstrating 100% transferability. A cross-amplification percentage of 75% was observed in P. venezuelense and 50% in P. leal-costae. The results showed that the primers developed to identify polymorphic SSR loci in P. solimoesense populations presented a considerable percentage of cross-amplification.
Keywords: SSR. Amazon Rainforest. Atlantic Forest. Genetic diversity.
INTRODUÇÃO
A partir da caracterização dos recursos genéticos de suas espécies nativas, o gerenciamento e a manutenção da diversidade de comunidades vegetais de florestas tropicais tornam-se possíveis. Neste âmbito, diversas investigações baseadas em técnicas de Biologia Molecular são indispensáveis para fins de conservação, permitindo a identificação de regiões com maiores níveis de diversidade ou áreas de isolamento (devido a processos de fragmentação), propiciando, por exemplo, o manejo de habitats, com o objetivo de minimizar ou reduzir a extinção de espécies (Pennington & Dick, 2010). Além disso, a caracterização da diversidade genética de espécies vegetais de centros de biodiversidade relevantes, como a bacia amazônica e a Floresta Atlântica, pode contribuir para o entendimento da ecologia, como também da evolução desses sensíveis ecossistemas, fornecendo informações valiosas para estudos populacionais e biogeográficos das regiões de interesse (Miyaki & ALves, 2006).
As florestas Amazônica e Atlântica são consideradas as florestas tropicais mais abundantes em elementos da fauna e da flora e compreendem duas das principais fontes de biodiversidade do planeta (Costa, 2003). Atualmente, estes dois biomas basicamente úmidos e sombreados encontram-se separados por uma extensa faixa de campos abertos de clima mais seco (Cerrado e Caatinga), porém há vários indícios de que, no passado, haviam conexões entre a Amazônia e a Floresta Atlântica, as quais se mostram em um padrão muito mais complexo do que se pensava anteriormente (Turchetto-Zolet et al., 2012; Batalha-Filho et al., 2013). Os padrões evolutivos entre as populações existentes nos dois biomas ainda não estão muito claros, especialmente no que diz respeito à ocupação e estruturação dos ambientes pelas comunidades vegetais.
Diversas técnicas de Biologia Molecular podem ser utilizadas na caracterização da distribuição espacial da variabilidade e conectividade genética entre populações vegetais (naturais ou cultivadas), quer sejam contínuas ou claramente fragmentadas (Weising et al., 2005). Dentre os marcadores mais utilizados nas análises populacionais, encontram-se os SSRs, ou microssatélites, que se destacam por serem facilmente acessados através de metodologias muito bem estabelecidas, além de serem extremamente informativos devido ao alto nível de polimorfismo acessado e por seu caráter codominante (Weising et al., 2005; Victoria et al., 2011). Contudo, o desenvolvimento e a aplicação de marcadores informativos para a imensa maioria das plantas nativas ainda são bastante limitados.
O gênero Philodendron apresenta uma grande diversidade ecológica (Mayo et al., 1997) e é o segundo maior da família Araceae, com aproximadamente 500 espécies conhecidas (The Plant List, 2013), sendo um dos principais componentes da flora da América tropical. As espécies que compõem o gênero possuem um potencial econômico significativo, levando em consideração sua utilização tradicional na alimentação, fibras para artesanato e, principalmente, no âmbito ornamental, por conta das folhas conspícuas e morfologia variada (Oliveira, 2011; Castelar et al., 2013).
Embora estejam sendo desenvolvidas algumas análises de sistemática molecular na tentativa de entender as complexas relações filogenéticas entre as espécies de Philodendron e os grupos irmãos (e.g. Gauthier et al., 2008), dados relacionados à análise da diversidade genética entre populações nativas das espécies do grupo são escassos, havendo uma completa carência da descrição de marcadores moleculares informativos para tais abordagens.
MATERIAL E MÉTODOS
Foram utilizados espécimes (uma folha jovem por indivíduo) de diferentes populações de espécies de Philodendron provenientes da Amazônia e da Floresta Atlântica. O procedimento de extração de DNA utilizado foi de acordo com o protocolo CTAB I descrito por Weising et al. (2005), com modificações. Aproximadamente 2g de folhas jovens foram lavadas e pulverizadas em um almofariz com nitrogênio líquido, utilizando um pistilo. Após a transferência do material para tubos de polipropileno de 50 ml, foram adicionados 10 ml de tampão de extração [CTAB 2%, Tris-HCl 0,1 mM (pH 8,0), EDTA 20 mM (pH 8,0), NaCl 1,4 M NaCl e β-mercaptoetanol 2%], a 60 °C, por pelo menos 40 min, sob leve agitação periódica. Após o resfriamento do extrato, foram adicionados 10 ml de solução de clorofórmio e álcool isoamílico (24:1) aos tubos, efetuando-se uma homogeneização seguida de centrifugação por 20 min a 4000 rpm. Parte do sobrenadante resultante (~8 ml) foi transferida para um novo tubo, adicionando-se 60% do volume de isopropanol, misturando-se cuidadosamente por inversão. Posteriormente, os tubos foram centrifugados a 4000 rpm por 20 min, ocorrendo, assim, a precipitação do DNA, e, então, o pellet foi lavado com etanol 70%.
A precipitação seletiva de polissacarídeos contaminantes foi realizada conforme descrito por Michaels e colaboradores (1994), com algumas modificações: (1) ao pellet de DNA foram adicionados 500 uL da solução de precipitação [Tris-HCl 10 mM (pH 8,0) e NaCl 250 mM]; (2) ao DNA diluído foram adicionados 180 uL de etanol absoluto gelado sob agitação e, então, submetidos a −20 °C por 18 h; (3) o material foi centrifugado a 14000 rpm por 20 min a 4 °C e a fase líquida (sobrenadante) foi transferida para um novo tubo; (4) foram adicionados 700 uL de isopropanol os tubos contendo o DNA diluído, os quais foram invertidos por 50 vezes e, então, deixados por 15 min a temperatura ambiente; (5) o material foi centrifugado a 14000 rpm por 15 min a 24 °C, e, então, o sobrenadante foi descartado para possibilitar a secagem do pellet a temperatura ambiente. O DNA obtido foi ressuspendido em 400 uL de solução TE [Tris-HCl 10 mM (pH 8,0) e EDTA 0,1 mM], e, então, foi adicionado 1 uL de RNase 10 ug/ml para a digestão do RNA contaminante a 37 °C por 1 h.
A biblioteca de microssatélites nucleares, obtida por meio de sequenciamento shotgun do DNA genômico de P. solimoesense em um sequenciador Roche 454 GSFLX (Roche Diagnostics) como descrito por Wörmann et al. (2012), foi utilizada para a mineração e a caracterização das regiões de SSR no presente estudo. A ocorrência e as frequências dos SSRs foram determinadas utilizando-se o software SciRoKo (Kofler et al., 2007) e os primers para a amplificação de tais marcadores foram desenhados a partir da ferramenta WebSat (Martins et al., 2009). Adicionalmente, as características termodinâmicas e de interação entre os pares de primers obtidos foram testados no software PerlPrimer (Marshall, 2004).
RESULTADOS E DISCUSSÃO
Nesta primeira etapa do projeto, foram utilizados espécimes de diferentes populações de Philodendron oriundas da Amazônia e da Floresta Atlântica. As folhas jovens destes indivíduos estavam devidamente armazenadas nas dependências do Laboratório de Genética e Biotecnologia Vegetal (LGBV) do Departamento de Genética da Universidade Federal de Pernanbuco (UFPE). O número de espécimes utilizados, até o momento, e outras informações dessa etapa podem ser visualizadas na Tabela 1.

No presente momento, está sendo realizada a extração de DNA de espécimes de populações adicionais das espécies já amostradas, bem com todo o processo de purificação do DNA.
A partir dos dados obtidos por meio do sequenciamento shotgun do DNA genômico de P. solimoesense foram sequenciados 46.321 fragmentos, dos quais 1.168 contêm motivos SSR aptos a serem utilizados no desenho e posterior síntese dos 20 pares de primers a serem empregados nas análises deste trabalho. Em relação à composição de microssatélites, um total de 2.299 loci de SSR foram encontrados (Tabela 2). Repetições de dinucleotídeos foram mais frequentes do que os outros tipos de repetições, apresentando 953 SSRs (41,5%), das quais 631 (66,2%) foram motivos AG/CT. Em contrapartida, foram contadas apenas 115 repetições de mononucleotídeos (5%), das quais a grande maioria (88,7%) consistiu em SSRs poli-A. Com base nesses dados, observa-se que aproximadamente 20% das regiões aptas para serem utilizadas no desenho de primers continham repetições SSRs, com no mínimo 20 pb, que podem ser devidamente testadas para a amplificação de loci polimórficos e utilizadas em mais análises de diversidade populacional em espécies de P. solimoesense, como também para análises de amplificação cruzada em outras espécies do gênero (ver Vasconcelos et al., 2013).

Um total de 1.168 regiões foram apropriadas para o desenho de marcadores SSR, constituindo mais de 50% de todas as regiões observadas. Destas, as 28 regiões contendo os maiores números de repetições foram selecionadas para a confecção dos respectivos primers (Tabela 3), os quais já se encontram no LGBV - UFPE.

CONCLUSÃO
Os pares de primers SSR avaliados possuem grande potencial para estudos genéticos no gênero Philodendron, tais como estudos de variabilidade intraespecíficos e interespecíficos. Dessa forma, os fragmentos amplificados serão separados em gel de poliacrilamida (6%), pois o poder de resolução é maior para análises de polimorfismos. Além disso, novos ensaios envolvendo espécimes de diferentes populações de Philodendron, oriundas de quatro regiões da Amazônia e de duas regiões da Floresta Atlântica estão sendo utilizados, totalizando 68 indivíduos. Considerando-se o alto custo no desenvolvimento de marcadores SSR, a análise de transferibilidade mostrou-se relevante e fundamental para a identificação da diversidade genética em populações de Philodendron.
REFERÊNCIAS
BATALHA-FILHO, H., FJELDSÅ, J., FABRE, P. H., & MIYAKI, C. Y. (2013) Connections between the Atlantic and the Amazonian forest avifaunas represent distinct historical events. Journal of Ornithology, v. 54, p. 41-50.
CASTELLAR, A.; OLIVEIRA, D. R.; LEITÃO, S. G.; BIZZO, H. R.; SOARES, M. D. L. C.; KINUPP, V. F.; VEIGA-JUNIOR, V. F. (2013) Essential oil from Philodendron fragrantissimum, an aromatic Araceae from Amazonia, Brazil. Journal of Essential Oil Research, v. 25, p. 194-197.
COSTA, L. P. (2003) The historical bridge between the Amazon and the Atlantic Forest of Brazil: a study of molecular phylogeography with small mammals. Journal of Biogeography, v. 30, p. 71-86.
CROAT, T. (1997) A revision of Philodendron subgenus Philodendron (Araceae) for Mexico and Central America. Annals of the Missouri Botanical Garden, v. 84, p. 311-704, 1997.
GAUTHIER, M. P. L.; BARABE, D.; BRUNEAU, A. (2008) Molecular phylogeny of the genus Philodendron (Araceae): delimitation and infrageneric classification. Botanical Journal of the Linnean Society, v. 156, p. 13-27.
GRAYMUM, M. H. (1996) Revision of Philodendron subgenus Pteromischum (Araceae) for Pacific and Caribbean Tropical America. Systematic Botany Monographs, v. 47, p, 1-233.
KOFLER, R.; SCHLOTTERER, C.; LELLEY, T. (2007) SciRoKo: a new tool for whole genome microsatellite search and investigation. Bioinformatics, v. 23, p. 1683-1685.
MARSHALL, O. J. (2004) PerlPrimer: cross-platform, graphical primer design for standard, bisulphite and real-time PCR. Bioinformatics, v. 20, p. 2471-2472.
MARTINS, W. S.; LUCAS, D. C. S.; DE SOUZA NEVES, K. F.; BERTIOLI, D. J. (2009) WebSat - a web software for microsatellite marker development. Bioinformation, v. 3, n. 6, p. 282-283.
MAYO, S. J. (1991) A revision of Philodendron subgenus Meconostigma (Araceae). Kew Bulletin, v. 46, p. 601-681, 1991.
MAYO, S. J.; BOGNER, J.; BOYCE, P. C. (1997) The genera of Araceae. Royal Botanic Gardens, Kew, Richmond, Surrey, UK. 346p.
MIYAKI, C. Y.; ALVES, M. A. S. (2006) Técnicas genéticas aplicadas à conservação, In: ROCHA, C. F. D. et al. (Orgs). Biologia da Conservação: essências. São Carlos: RiMa. p. 437-458.
OLIVEIRA, R. F. M. (2011) Aspectos etnobotânicos e taxonômicos de Araceae Juss. na comunidade Santa Maria, Baixo Rio Negro - AM. Dissertação (Mestrado em Ciências Biológicas - Botânica) - Instituto Nacional de Pesquisas da Amazônia, Manaus.
PARK, S. D. E. (2001) Trypanotolerance in West African cattle and the population genetic effects of selection. Tese (Ph. D.) - Universidade de Dublin, Dublin, Irlanda.
PENNINGTON, R. T.; DICK, C. W. (2010) Diversification of the Amazonian flora and its relation to key geological and environmental events: a molecular perspective, In: HOORN, C.; WESSELINGH, F. P. (Orgs). Amazonia, landscape and species evolution: a look into the past. Hoboken: Wiley-Blackwell Publishing Ltd. p. 373-385.
THE PLANT LIST. Disponível em: <http://www.theplantlist.org/>. Acesso em: 10 jan. 2023.
TURCHETTO-ZOLET, A. C.; CRUZ, F.; VENDRAMIN, G. G.; SIMON, M. F.; SALGUEIRO, F.; MARGIS-PINHEIRO, M.; MARGIS, R. (2012) Large-scale phylogeography of the disjunct Neotropical tree species Schizolobium parahyba (Fabaceae - Caesalpinioideae). Molecular and Phylogenetics and Evolution, v. 65, p. 174-182.
VASCONCELOS, S. et al. (2013) Characterization of microsatellites and gene content from genome shotgun sequences of Philodendron solimoesense (Araceae), a thermogenic arum lily from the Amazon basin. Anais do IV Simpósio Brasileiro de Genética Molecular de Plantas.
VICTORIA, F. C.; DA MAIA, L. C.; DE OLIVEIRA, A. C. (2011) In silico comparative analysis of SSR markers in plants. BMC Plant Biology, v. 11, p. 15.
WEISING, K.; NYBOM, H.; PFENNINGER, M.; WOLFF, K.; KAHL, G. (2005) DNA fingerprinting in plants: principles, methods, and applications. 2ª ed. - CRC Press: Boca Raton.
WÖHRMANN, T.; WAGNER, N.; KRAPP, F.; HUETTEL, B.; WEISING, K. (2012) Development of microsatellite markers in Fosterella rusbyi (Bromeliaceae) using 454 pyrosequencing. American Journal of Botany, v. 94, n. 4
_______________________________________________
1Professor de Ciências Naturais (CMR), Doutor Biotecnologia (UFPE). Email:

Descortinando sentido(s): a compreensão textual
Ana Carolina Almeida de Barros1
|
“O melhor é pensar em termos de sujeito-objeto-sujeito: duas subjetividades criando uma realidade intercomunicável. Sentidos são bens humanos e não fenômenos naturais” (Marcuschi, 2002, p. 60) |
RESUMO: Voltamo-nos, no presente artigo, a considerações acerca do processo de compreensão leitora, entendendo o humano, ser de linguagem, como aquele capaz de negociar saberes, a partir de uma infinidade de conhecimentos, inclusive, no que configura aspectos sociais, culturais, valorativos e ideológicos. Entendemos, esse sujeito, antes de tudo, como um ser situado. É na troca e no trânsito entre autor-texto-leitor que as emersões de sentido se fazem, é quando as significações emergem, pois no empreendimento das intersubjetividades o potencial de (re)construção atua. Na e para compreensão, estratégias linguístico-cognitivo-discursivas são lançadas mão no acesso ao(s) sentido(s), em ações comunicativas dinâmicas estabelecidas comunitariamente. Para as reflexões empreendidas, acerca da elaboração, processamentos, estratégias, mas também compreensão leitora, fez-se importante revisitarmos Marcuschi (2002, 2008, 2011), Koch (2009), Solé (2009), Leffa (1996), Coscarelli & Novais (2010) e Kleiman (2002). Em todo, a compreensão, quando do aspecto macro, reflete o olhar compartilhado, em horizontes possíveis, para e no auxílio à construção de existências e verdades, sendo, sempre, a linguagem o lócus e a via por onde toda a ação coordenada entre os interlocutores acontece na efetivação de sentidos.
Palavras-chave: Língua. Texto. Compreensão. Sentido(s).
ABSTRACT: In this article, we considered the process of reading comprehension, taking the human being like a being of language, who is capable of negotiating knowledge, based on an infinite amount of data, including social, cultural, evaluative and ideological aspects. We understand this individual, first and foremost, as a situated being. It is in the exchange and transit between author-text-reader that the meanings emerge because, in the enterprise of intersubjectivity, the potential for (re)construction acts. In and for understanding, linguistic-cognitive-discursive strategies are used to access meaning(s), in dynamic communicative actions established in a community. For the reflections on elaboration, processing, strategies, but also on reading comprehension, it was important to review Marcuschi (2002, 2008, 2011), Koch (2009), Solé (2009), Leffa (1996), Coscarelli & Novais (2010) and Kleiman (2002). In general, comprehension, from the macro aspect, reflects a shared view, in possible horizons, for and in helping the construction of existences and truths, with language always being the place and the route in which all the coordinated action between the parties involved happens in the creation of meaning
Keywords: Language. Text. Comprehension. Meaning.
INTRODUÇÃO
Compreender como se dá o processo de construção de sentido(s), configura-se como um deslocamento na busca por práticas de linguagem efetivadas e articuladas às dinâmicas interlocutivas, que são negociadas, representadas e produzidas intersubjetivamente, apontando para a construção das mais diversas experiências. Para isso, os interlocutores consideram suas necessidades, objetivos e intenções a cada ponto e momento interativo, a partir do que dispõem como bases e orientadores das práticas linguageiras a serem adotadas e desenvolvidas naquele momento de trocas, em uma relação autor-texto-leitor.
Compreende-se que os sujeitos atuantes configuram e constroem mundos, bem como os objetos discursivos a partir da articulação conjugada entre subjetividade e objetividade, organismo e meio, individual e social, assim como em orientações e alinhamentos que têm como base a própria coletividade e suas práticas interativas.
Admitimos, em nosso percurso, enquanto seres cognitivos situados, comportamentos e convenções compartilhados, negociações, bagagens experienciais e um lastro envolvimento sociocultural, que possibilita, ao mesmo tempo, gerar e indicar os fins sociais sobre os quais se atua; perpassados somos por um “estado de conhecimento, social, emocional, etc” (Koch, 2008, p. 20), que conflui na geração de equilíbrios, arranjos e estabilidades.
Ressaltamos, contudo, que os textos e suas configurações (oral ou escrita) fornecem pistas e deixam rastros; exercemos, enquanto participantes, papel fundamental em uma atividade de profunda complexidade no trato com “realidades discursivas”, pois lemos nas “entrelinhas” e empenhamo-nos, como (re)construtores, na mobilização de saberes e conhecimentos, buscando relacioná-los e articulá-los a esquemas de experiências outras e várias, a partir da socialização e da cultura.
Tem-se, então, a partir daquilo que vai sendo apontado, a construção do que envolve a compreensão textual, considerando, para tanto, que os humanos, seres de linguagem simbolicamente estruturada, organizam-se linguisticamente, a fim de produzir sentido(s) nas práticas comunicativas em que se engajam, podendo, tais práticas sinalizar coletivizações de experiências, bem como atitudes valorativas dos agentes, que atuam em movimentos de integração, em realidades que são sociocognitivamente fundamentadas.
As associações, neste texto propostas, têm por base estudos desenvolvidos por Marcuschi (2002; 2008; 2011), Kleiman (2002), Koch (2009), Carvalho (2014), Solé (2009), Bakhtin ([1979]1997), Löbler & Flôres (2010), Leffa (1996), Gonçalves (2008), Melo (2008), Bentes (2012), Paulino (2001), Leffa (1996), Salomão (1999), Carvalho (2010), Coscarelli & Novais (2010) e Lima (2001), em perspectivas que se somam e abrangem as noções de compreensão, emersão de sentido(s), no e para o estabelecimento de bases para o entendimento da leitura, a partir de construções interpretativas, bem como naquilo que configura conhecimento enquanto gatilho para as (re)significações, em articulação aos processos inferenciais e ao contexto, modelos mentais, para que a(s) compreensão(ões) dos textos seja(m) efetivada(s).
Noções de compreensão - a emersão de sentido(s)
A língua, as produções e as compreensões textuais não devem ser tomadas em enquadres de permanência ou inércia, muito menos o/um sentido que se revela exclusivamente na decodificação, ainda que esta seja uma das etapas do ato de ler e interpretar. Considerando-se a natureza do ato de ler, Kleiman (2002, p. 12) comenta que a leitura deve ser observada como um “processo psicológico em que o leitor utiliza diversas estratégias baseadas em seu conhecimento linguístico, sociocultural e enciclopédico”. Aponta-se para o processo de compreensão, no trato com texto, como múltiplo, elaborado em uma dinâmica de cooperação, em realidade agentiva e que recorre, para sua real efetivação, a uma vasta gama de saberes instanciados na pluralidade.
Assim como a leitura, os arranjos proporcionados pela língua não são dados de maneira fragmentária, mas também a partir do conhecimento do código e das representações que os sujeitos, envolvidos em embates linguisticamente orientados, empenham-se na (re)construção de materialidades e exploram/expõem suas representações, mediante uma organicidade concebida enquanto texto.
Consideramos o texto não através de uma perspectiva estruturalista, como um conjunto de elementos de ordem estritamente gramatical ou, ainda, concebido enquanto um produto logicamente orientado e finalizado, como uma espécie de condutor que, através de um movimento de decodificação realizado pelo sujeito-leitor, traria à tona o reconhecimento ou o acesso direto aos pensamentos/mensagens do autor-produtor. Tomando essa perspectiva como base, não haveria espaço e abertura para o extralinguístico e as construções seriam elaborações sedimentadas nas relações de objetividade; por consequência, a compreensão, em nada, amparar-se-ia em um movimento efetivamente cooperativo e interativo, como assim a consideramos, e os usuários da língua sujeitar-se-iam às mesmas possibilidades interpretativas, infindavelmente repetidas, controláveis e únicas.
A emersão dos sentidos dar-se-ia, nesses moldes, de maneira clara, linear e limitada, com uma língua que denotaria correspondência entre referentes e mundo, apontando para certa passividade dos sujeitos, minimizado, pois, suas atividades a mero reconhecimento e reprodução de uma realidade textual focalizada em estruturas e superfícies. Assim, são considerados, em uma abordagem estrutural sobre a língua, apenas, os fatores de ordem cotextual, não integrados a outros elementos - cultura, história e sociedade - no universo da compreensão, sem que sejam, por exemplo, alcançados os não-ditos, posto que não são explicitados pelo código.
O que há, no entanto, é a repercussão da realidade humana localizada, que articula e interconecta o aspecto histórico, social e cognitivo, enquanto bases constitutivas dos interagentes, e contribui, essencialmente, para os deslocamentos realizados em movimentos interpretativos, a partir de produções textuais, no auxílio das (re)construção de significados intencionados ou não pelo “autor” do texto e, consequentemente, na interpretação da realidade, pois situados estamos e construímos “nossos mundos através da interação com o entorno físico, social e cultural” (Koch, 2009, p. 79), mas também através dos nossos modelos, que operam (socio)cognitivamente na elaboração das situações discursivas que vão se revelando. A língua, então, mostra possibilidades de faces na interação e na atuação dos sujeitos sobre ela, em um mundo de coletividades, onde os agentes adéquam-na às possibilidades e aos efeitos/objetivos, supostamente pretendidos, através de (re)elaborações, a cada nova enunciação, por sujeitos que constroem e são construídos textualmente.
A compreensão pode ser validada, assim, como a construção de sentidos globais, mediante pistas linguisticamente apresentadas nos textos, ganhando contornos em uma atividade de coautoria, pois os sentidos não são de antemão dados e localizáveis, e dependem, como ressalta Carvalho (2014), das posições que os sujeitos ocupam, sejam: sociais, históricas, culturais ou ideológicas, em uma relação dinâmica e ricamente estruturada entre coletivo e individual, social e cognitivo, interno e externo, biológico e grupal, inter-relacionando-se em atuação conjunta. Os movimentos desempenhados para a construção das significações efetivam-se não em caráter isolacionista, mas através de uma rede integrada onde há negociação e operacionalização de recursos e elementos vários, a partir de um trabalho refinado de competência humana.
É importante salientar que não existem compreensões definitivas, singulares, mas sim convergentes, já que um texto mostra-se como “potencialidade” interpretativa entre o explicitado e o parcialmente complementado pelo trabalho dos leitores/ouvintes; ao transcorrer do tempo, há a possibilidade do aparecimento de novas significações, como sinaliza Marcuschi (2011, p. 92), já que “(...) o texto acha-se em permanente elaboração ao longo de sua história e das diversas recepções pelos diversos leitores”, pois as vivências e particularidades dos sujeitos experenciadores ativam uma pluralidade perceptiva, mediante o adquirido, armazenado e ativado para/na compreensão textual.
Para cada texto escrito ou enunciado, circunscrito em um gênero, há também a solicitação de leituras e comportamentos diferenciados, de modo tal que os interlocutores não assumem as mesmas posturas quanto a objetivos e intenções, lançando olhares e apropriando-se de maneiras distintas à leitura que procedem e às interpretações admitidas, em caminhos que possibilitam multiplicidades na (re)criação do sentido(s), em acordo com os interesses e finalidades, como nos aponta Solé (2009), em acessos que se dão sempre de maneira indireta.
Para que leituras e compreensões sejam efetivadas, considerando que ler não é meramente identificação mecanizada de informações, estratégias de alta complexidade são efetivadas, como: a seleção de dados, construção de relações entre eles, atenção a certas informações presentes no texto, pondo-as em maior ou menor grau de relevância, durante a leitura/escuta, etc. Ao utilizar-se de tais mecanismos, os interlocutores buscam a(s) (re)construção(ões) de sentido(s) dentro de margens possíveis, a partir de uma diversidade de perspectivas cabíveis, ativando esquemas e conceitualizações, que são revelados e tornados conhecidos de acordo com os contextos2 sociocognitivos dos interlocutores.
A compreensão, entretanto, não é uma arena onde tudo é válido, apesar das variadas maneiras de proceder com a leitura, como aponta Marcuschi (2008), pois existem “autorizações” ou “horizontes”. Eles requerem, para que haja sucesso interpretativo, de uma certa equidade entre o universo do texto e os conhecimentos dos leitores nas (re)elaborações de realidades textuais, lugar onde os agentes atuam cooperativamente e por negociações no estabelecimento de conexões/elos.
O texto torna-se, então, o lugar, o espaço, para se atuar de maneira reflexiva, sobre o qual, a partir de um processo de coprodução, procede-se a avaliações, verificações e complementações em pontos de preenchimento, em caminhada interpretativa avaliativa, a fim de que, considerando as pistas lançadas, proceda-se a uma ou a outra interpretação, mobilizando memórias e estabelecendo articulações entre cotexto e modelos de contexto, que são ativados pelos interlocutores.
O papel desempenhado pelo autor/produtor demonstra uma atividade também complexa quanto à produção por ele efetivada, pois pressupõe audiência, traça caminhos e lança âncoras consideradas recuperáveis por seus interlocutores, prevendo compartilhamento de enquadres cognitivos similares. A compreensão pode ser vista como uma atividade que requer cumplicidade com o texto, a fim de que implícitos e ideias não reveladas na superfície textual sejam acessados, bem como concepções ideológicas trazidas à consciência do leitor, a partir de uma imersão mais profunda e engajada (Marcuschi, 2011).
Uma atividade leitora realmente interativa e tomada por coerente vale-se das construções de um mundo plural e fluído, mas que ao mesmo tempo costura-se em um continuum, o que possibilita formulações, reformulações, aceitações, recusas, predições, etc., edificando-se enquanto uma atividade responsivo-ativa (Bakhtin, ([1979] 1997), mas também faz-se no entrelaçamento das vivências, quer com outros textos e leituras, quer com as experiências nos campos que compõem as mais diversas esferas da vida. Este somatório colabora e justifica, em alguma medida, as compreensões diversificadas e globalmente convergentes, quando do descortinar das intencionalidades, apontando para o(s) sentido(s) que não estão no texto em si, mas no interativamente constituído.
Entendemos, então, o texto de acordo com a perspectiva e as reflexões delineadas por Koch (2009, p. 9) como “[...] um constructo histórico e social, extremamente complexo e multifacetado, cujos segredos (...) é preciso desvendar para compreender melhor esse ‘milagre’ que se repete a cada nova interlocução”, isto é, elabora-se e torna-se compreensivo à medida que esforços são empregados pelos coenunciadores; aponta-se para interação, interconexão dos sujeitos e dos conhecimentos, o que também revela a heterogenia própria à língua e firma aquele constructo como um elo entre as práticas sociais que são (re)significadas a cada novo contato entre o sujeitos e a palavra, sendo os interagentes (op. cit., p. 20) “contemporâneos ou não, copresentes ou não, do mesmo grupo social ou não, mas em diálogo constante”.
Considera-se, portanto, a emergência da materialidade linguística a partir das articulações realizadas entre os agentes, o objeto (o texto) e o acesso a conhecimentos, que compõem um corpo de saberes relevantes e acionáveis nos movimentos de construção e reconstrução de significações, ligando os conhecimentos pressupostos ao explicitado textualmente, favorecendo um equilíbrio entre as informações dadas e os não-ditos, porém recuperáveis. Para tanto, deve-se contar com uma organização sistematizada, adequada, ajustada e escrita dentro de padrões pertencentes à situação comunicativa, que possibilite traçar e verificar hipóteses e garanta “que o leitor compreenda o texto e que (...) construa uma ideia sobre seu conteúdo, extraindo dele o que lhe interessa, em função dos seus objetivos” (Solé, 2009, p. 31).
Gradualmente, os sentidos vão sendo formatados e reformatados, construídos e reconstruídos, sem que haja uma linearidade sistematicamente pré-definida e configurada; eles completam-se ou complementam-se à medida que se avança no contato com a materialidade linguística, em conexões e articulações que deslizam em direção a significações sustentadas pelas assunções do autor-enunciador e do texto que se está a explorar.
A leitura, portanto, não é uma habilidade natural (inata), mas aprendida, e seu encaixe às configurações humanas - biológico, social e cultural - interferem na forma como a compreensão se realiza. Dependemos também de um sistema visual, mais especificamente quando tratarmos de textos escritos, e de um aparato cognitivamente equilibrado para que sejam efetivadas as interpretações, já que não são realizadas, apenas, através de informações pinçadas, do pontualmente reconhecido, em meio a unidades soltas e desarticuladas, mas ligações amparadas entre diversos conhecimentos disponíveis e utilizáveis, somados a conhecimentos já internalizados e selecionados, pois “quem compreende precisa mostrar que compreendeu e fazer uso do que foi compreendido de forma a modificar sua situação cognitiva inicial” (Löbler & Flôres, 2010, p. 182).
Amparar-se, portanto, em concepções que operem numa perspectiva em que sentidos são estabelecidos a partir de relações unívocas, em mera decodificação ou ainda em arranjos de letras e sílabas, é um recorte que não permite avanços e possibilidades que desemboquem no saber ou articulações para conhecimentos mais elaborados, dado que a compreensão está para além da exploração da significação de um vocábulo, do conjunto de algumas palavras ou da mera disposição destas no texto.
No que diz respeito ao quadro das compreensões e percepções, considera-se e valida-se também o aspecto temporal, como salientado por Leffa (1996), pois as (re)significações são viabilizadas nas interlocuções e afetam as “consciências” quando banham-se nas realidades discursivas, gerando intercâmbios significativos que são (re)construídos, possibilitando que os textos, enquanto instrumentos comunicativos, orientem-se dentro de certas realidades socioculturais e propaguem, como afirma Gonçalves (2008, p.148), “valores, ideologias, conhecimentos sobre o mundo”, requerendo uma agentividade reflexiva e consistente.
O sentido, todavia, como aponta Melo (2008, p. 90), “(...) dá-se por aquilo que o leitor ou produtor de um texto vê em seu mundo particular, que é um mundo também de coletividade”; as angulações são/estão embasadas nas singularidades que constituem os sujeitos e a elas tornam-se ajustáveis, mas são em algum grau compartilháveis, pois pautam-se ou apoiam-se no socialmente representado, e por elas somos afetados, já que as produções humanas orientam e exercem força estruturadora.
Para que essas produções possam ser compreendidas enquanto formações linguístico-textuais que se desdobram em sentidos, há um grande empreendimento por parte do leitor/ouvinte. Este desenvolve uma série de estratégias e parte da premissa direcionadora que o faz crer, ser toda aquela organização não só dotada de uma verdade, mas também articuladora de coerência, ainda que não se considere a coerência como existente no texto em si, mas resultante de uma atividade empreendedora dos interlocutores.
Bentes (2012) traz uma interessante perspectiva quanto aos papéis desempenhados pelos interlocutores nos movimentos que executam para atingir o alvo, o(s) sentido(s), e nos níveis cooperativos por eles a serem lançados mão, considerando, para tanto, as funções preenchidas e os enquadres situacionais, pois “a atitude do leitor ou destinatário ante uma determinada produção textual pode ser mais ou menos cooperativa; isso dependerá uma série de fatores, entre eles, o próprio papel social do leitor ou destinatário” (p. 276).
Os direcionamentos veiculados pela estudiosa levam-nos a entender a impossibilidade de se negar imagens produzidas, perspectivas assumidas, valor atribuído às produções textuais e a importância social com a qual se julga o hábito ou atividade leitora, dada a relevância e a particular importância que tal prática exerce no meio cultural, posta a sua capacidade transformativa, que circunscreve os acordos estabelecidos entre as sociedades e suas tradições: desde a valorização do instrumento leitura e seu status social e econômico, bem como a forma como essas interações são reconhecidas pelos grupos de indivíduos, mas também as práticas adotadas e a significação que podem favorecer a imersão em diferentes territórios do saber.
Considerando o aspecto social, o pertencimento grupal, a não desvinculação das individualidades, os arranjos e acordes das dinâmicas processadas em (inter)textos e os aspectos político-econômicos, como apontado por Paulino (2001), encaminha-se para amplitude daquilo que envolve o quadro do processamento textual, a sua construção apreensiva, a partir de um oceano margeado por possibilidades, em atuações ora conscientes ora inconsciente do ato de ler e do que circunscreve os domínios e investimentos da prática leitora.
No que tange aos processos conscientes e inconscientes, Leffa (1996, p.153), assim como Paulino (op. cit.) concordam quando abordam a existência de um trânsito entre estes níveis e os subprocessos, apontando para uma variação “desde o nível inconsciente do processamento gráfico até o nível altamente consciente de atenção, exigida em tarefas como a monitoração da própria compreensão”, demonstrando, portanto, a realização de trocas ininterruptas entre essas instâncias.
O que isso faz refletir é que, embora tal atividade seja realizada a partir também de subprocessos, a operacionalização entre eles não se dá de forma desconexa. Para que seja possível uma efetiva orientação que reflita potencialmente na significação, todo o trabalho entre essas instâncias, em movimentos de maior ou menor vigilância, desloca-se por caminhos que validem o trajeto da leitura, fazendo com que as unidades trabalhem conjuntamente, a fim de que possam, como uma engrenagem, concorrer para um funcionamento orgânico, em trabalho articulado e harmonioso.
A compreensão desse todo, a partir da materialidade textual, desdobra-se em ocorrências interpretativas similares pelos agentes, posto que “existem inúmeros elementos no texto que nos encaminham em direção semelhante” (Coscarelli & Novais, 2010, p. 38), demonstrando, assim, que para cada situação enunciativa há estratégias, ações, buscas e sinais que concorrem para a existência de uma certa “estabilidade” na construção significativa, procedendo a (re)formulações que possam ser sustentadas pelo próprio texto, sem, contanto, deixar de considerar a dinamicidade que envolve tal processamento, mas sem também facilitar aproximações que levem às extrapolações, atingindo “horizontes indevidos” que, como definiu Marcuschi (2008), compreenderiam uma atividade leitora conduzida a interpretações indevidas, em graus de incompatibilidade e impossibilidades, relacionadas a um determinado texto, gerando sentido(s) equivocado(s) e bastante problemáticos(s)
O leitor, durante a (re)construção das informações e mensagens, vai validando os comportamentos, checando os caminhos que podem ser percorridos, com o intuito de que a atividade sobre a qual se debruça seja efetivada o mais eficazmente possível através das decisões, observações e constatações que o levem às camadas mais profundas em sua experiência de leitura, do explícito ao implícito. Assim, utilizando-se de habilidades e estabelecendo focos de interesse, compreendendo que não se está tratando com um recipiente ou um depósito, onde as informações são despejadas e ganham vida, cede-se, pois, “espaço” às trocas e às complementações efetivadas e (re)atualizadas nos câmbios e nos diálogos executados.
Não há, portanto, passividade leitora, e apesar de ser um movimento realizado de maneira individual, insere-se, pela própria constituição e organização humana, dentro de um conjunto, sugerindo potenciais de significação em atividade dialógica, pois
|
[...] fazer sentido (ou interpretar) é necessariamente uma operação social na medida em que o sujeito nunca constrói o sentido-em-si, mas sempre para alguém (ainda que este alguém seja si mesmo). Construir sentido, como já ilustramos, implica em (sic) assumir uma determinada perspectiva sobre uma cena, perspectiva que é também mutável no próprio curso da cena (Salomão, 1999, p. 71). |
A Linguística aponta para a existência de posturas, inclinações e vieses perceptivos contornados pelas relações estabelecidas entre vivências, experiências, memórias, acúmulo e acomodação, social e cultural, em processos elaborativos através de capacidades e habilidades cognitivas próprias da espécie humana que, no contato com os outros agentes de interlocução, auxiliam e orientam a construção de “mundos” de sentido(s) através da linguagem.
Compreender, torna-se, de certo modo, uma explicitação de universos, daquilo que foi possível acessar e construir, tomando como base as ordens cognitiva, ideológica, social e cultural repertoriados e processados de maneira única, no entanto, compartilháveis com outros seres com os quais se interage em espaços diversos da vida, a partir de conhecimentos que foram/são publicamente organizados e aceitáveis, em discursos e versões socialmente validados, que apontam para a complexidade de uma língua viva, em que convenções negociadas (Marcuschi, 2002; Carvalho, 2010).
voda essa complexa rede de relações, desemanharamentos e articulações só ocorrem no contato real e efetivo com a materialidade enunciada linguisticamente, em que o texto funciona como um “[...] input e é processado pelo leitor, que realiza diversas operações simultâneas e integradas, gerando, a cada momento, sentidos que podem ser mantidos, enriquecidos, reconstruídos ou modificados a cada segundo de leitura” (Coscarelli & Novais, 2010, p. 38).
Não há, partindo dessa perspectiva, como dizer que as palavras ou sequências arranjadas carregam em si e por si mesmas o significado, pois existe um dinamismo próprio a cada nova situação, fazendo emergir estruturas significativas, sem que, no entanto, todas as determinações prévias sejam estabelecidas, mas sem também contarmos com uma vagueza absoluta dos elementos que compõem a língua, pois elas, em algum grau, apontam para uma certa perspectiva em virtude das práticas comunicativas e de um processo de cooperação, na atuação de sujeitos cognitivos situados, que refletem domínios e práticas das comunidades às quais pertencem.
Como aponta Lima (2001, p. 22), “a linguagem desencadeia operações mentais, que terão papel fundamental na produção de sentido”, isto é, os significados são construções de ordem cognitiva que ganham estruturação, reconfiguração e atualização, considerando-se, para tanto, as diferentes vivências intergrupais, os saberes distintos, reunidos e ativados, mas acumulados também ao longo do percurso evolutivo humano, quer tratemos de conhecimentos ou práticas, ativados, certamente, dentro das parcelas que compõem as individualidades desses agentes de linguagem.
O que se precisa ter em vista, portanto, é que há sempre uma orientação do que fazer, como fazer, para quê fazê-lo, em direção a quem, com quais objetivos. Não nos construímos, tampouco elegemos modelos ou os configuramos sem compreendermos, minimamente, que, ao optarmos por determinados constructos e os tornarmos públicos, os fazemos por caminhos recheados de propósitos, intenções e com vistas a algum “alvo”, os nossos interlocutores, e, certamente, neles despertaremos a emergência de ideias, valores, atitudes, a partir da maneira como, no contato com aquela enunciação, eles processarão a situação social na qual estão inseridos; à audiência credita-se que certas significações serão alcançadas, bem como intenções reconhecíveis, partindo do tomado por relevante em um jogo interlocutivo, mas que não o será em outro.
CONSIDERAÇÕES FINAIS
O que, aqui, apontado, não pretende ser o fim das discussões, posto que o aprofundamento em compreensões efetivas, no processualmente constituído, são marcadas por uma diversidade de saberes - linguístico, enciclopédico, interacional - como também indicam as implicações, dessa diversidade, no processo interpretativo e na própria condição sociocognitiva dos sujeitos linguageiros.
Autor e interlocutor exercem atividade em articulação, em prática conjunta, a fim de que sentido(s) seja(m) expandido(s) e significação(ões) construídas no momento próprio à interação, pois “as coisas ditas são discursivamente construídas e a maioria dos nossos referentes são objetos de discurso” (Marcuschi, 2007, p. 89), já que nada é dado a priori e os textos nunca estão prontos e acabados, mas tornam-se realidade e materializam-se; as referências tomam como suporte as esferas sociais, históricas, culturais e cognitivas que possibilitam, dentro de enquadres repertoriados, congruências e incongruências a cada novo acesso, em aproximações ou afastamentos decorrentes das experiências e das relações com universos estabelecidos e reconhecidos.
As percepções e perspectivas assumidas só são tornadas possíveis, porque as configurações e representações, nessas atividades, não estão localizadas em modelos mentais individuais, mas nos repertórios comuns aos interlocutores, no conjunto das relações estabelecidas também com a exterioridade, entre as intersubjetividades, dados os conteúdos/saberes que se organizam histórico, cultural, social e cognitivamente, em conhecimentos que emergem, mais uma vez, no compartilhamento e neles ganham alguma produtividade/relevância em processos interventivos e ações desempenhadas por sujeitos de linguagem.
A exposição aqui feita não teve como papel esgotar as abordagens quer no que concerne a aspectos cognitivos, de linguagem, de compreensão e de gênero textual, mas pontuar algumas questões envolvidas quando tratamos de (re)significação e emersão de sentidos. Apontamos, assim, indícios de como essa atividade pode se configurar, a partir de gatilhos, “refletindo” a existência de uma prática comum entre os interlocutores, em um processo complexo e plural, em ordens e esforços realizados pelo(s) interactante(s) em (re)construções e (re)modelações, dado o entrecruzamento de informações várias, em elos formativos que, para se sustentarem, consideram os conhecimentos prévios e os indivíduos que se edificam em práticas situadas, mas, especialmente, entre implicitudes e explicitudes.
REFERÊNCIAS
BAKHTIN, M. M. (1997) Estética da criação verbal. (Trad. Maria Ermentina Galvão). São Paulo: Martins Fonte.
BENTES, A. C. (2012) Linguística textual. In: MUSSALIM, F.; BENTES, A. C. Introdução à Linguística - Domínios e fronteiras. 9ª ed. - São Paulo: Cortez.
CARVALHO, M. A. F. (2010) Linguagem e mundo: atividades linguísticas como construção de sentidos. Revista de Letras (UNESP), v. 14, p. 40-52.
CARVALHO, R. S. (2014) Os modos de olhar o texto. In: NUNES, A. M. et al. Olhares cruzados - processos interpretativos. Campinas: Pontes Editores, p. 175-183.
COSCARELLI, C. V.; NOVAIS, A. L. (2010) Leitura: um processo cada vez mais complexo. Letras de Hoje, v. 45, n. 3, p. 35-42.
DIJK, T. A. v. (2012) Discurso e Contexto: uma abordagem sociocognitiva (Tradução: Rodolfo Ilari). SP: Editora Contexto.
GONÇALVES, S. (2008) Aprender a ler e compreensão do texto: processos cognitivos e estratégias de ensino. Revista Ibero-Americana de Educação, n. 46, p.135-14.
KLEIMAN, Â. (2002) Oficina de leitura: teoria e prática. Campinas: Pontes.
KOCH, I. G. V. (2009) Desvendando os segredos do texto. 6ª ed. - São Paulo: Cortez.
LEFFA, V. J. (1996) Fatores de compreensão na leitura. Cadernos do IL, Porto Alegre, v. 15, n.15, p. 143-159.
LIMA, C. R. G. M. (2001) Meios linguísticos de distribuição da atenção: um estudo sociocognitivo da dêixis. Dissertação (Mestrado em Letras) - Universidade Federal de Juiz de Fora. Juiz de Fora, 116p.
LÖBLER, D. A. D.; FLÔRES, O. C. (2010) As profundezas da compreensão: as inter-relações entre interpretação, compreensão e significado. Signo, v. 35, n. 59, p. 181-196.
MARCUSCHI, L. A. (2002) Do código para a cognição; o processo referencial como atividade criativa. Revista Veredas, v. 6, n.1, p. 43-62.
MARCUSCHI, L. A. (2008) Produção textual, análise de gêneros e compreensão. São Paulo: Parábola Editorial.
MARCUSCHI, L. A. (2011) Compreensão textual como trabalho criativo. Unesp, Disponível em: <http://acervodigital.unesp.br/ bitstream/123456789/40358/3/0 1d 17t07.pdf>. Acesso em: 10 set. 2023.
MELO, C. T. (2008) A construção da sinonímia por encapsulamento anafórico: uma perspectiva sociocognitiva. Tese (Doutorado em Linguística) - Universidade Federal de Pernambuco. Recife, 131p.
PAULINO, G.; CURY, M. Z.; WALTY, I.; PAULINO, G.; FONSECA, M. N. (2001) Tipos de textos, modos de leitura. Belo Horizonte: Formato Editorial.
SALOMÃO, M. M. M. (1999) A questão da construção do sentido e a revisão da agenda dos estudos da linguagem. Revista Veredas, v. 3, n.1, p. 61-79.
SOLÉ, I. (2009) Estratégias de leitura. Tradução Cláudia Schilling. 6ª ed. - Porto Alegre: Artmed.
_______________________________________________
1Professora de Língua Portuguesa (CMB), Doutora em Letras (UFPE). Email:
2O contexto, na perspectiva adotada, é construído a partir das relações sociointerativas em que os atores sociais, mediante a situação de interlocução, tomam dados elementos como importantes, no intuito de produzir e compreender os discursos (Dijk, 2012).

Analfabetismo visual: desvendando a linguagem visual para a compreensão e análise de imagens e visualidades no mundo contemporâneo
Ramon Carvalho Pereira1
RESUMO
O analfabetismo visual na contemporaneidade foi investigado e ressaltada sua importância diante da sobrecarga de informações visuais. A expressão vai além da simples decodificação de imagens, indicando a dificuldade em compreender efetivamente informações visuais. Foram exploradas a percepção visual e a relevância da alfabetização visual na comunicação eficaz, considerando a cognição visual em narrativas complexas. A influência dos meios de comunicação na interpretação da realidade também foi discutida. O artigo sugere uma análise aprofundada das origens e possíveis estratégias para superar o analfabetismo visual, aplicando-se ao público-alvo de alunos do 7º ano do Ensino Fundamental, visando a uma sociedade onde a linguagem visual seja acessível a todos e melhor compreendida e explicada por esse público.
Palavras-chave: Analfabetismo visual. Percepção visual. Análise de imagens.
ABSTRACT
Visual illiteracy in contemporary times has been investigated, emphasizing its relevance in the face of visual information overload. The term goes beyond the simple decoding of images, indicating the difficulty in effectively understanding visual information. Visual perception and the relevance of visual literacy in effective communication were explored, taking into account visual cognition in complex narratives. The influence of the media on reality interpretation was also discussed. The article suggests an intensive analysis of the origins and possible strategies for overcoming visual illiteracy, applying it to the target audience of 7th-grade middle school students, aiming for a society where visual language is accessible to everyone and better understood and explained by this audience.
Keywords: Visual Illiteracy. Visual perception. Image analysis
INTRODUÇÃO
Na atual tapeçaria da sociedade, onde a informação se desdobra em diversas formas e meios, a habilidade de interpretar elementos visuais tornou-se uma competência crucial. Contudo, para alguns, essa habilidade está longe de ser uma jornada descomplicada. O termo "analfabetismo visual" surge como uma expressão que transcende a simples decodificação de imagens, representando a dificuldade ou incapacidade de compreender ou interpretar informações visuais de maneira eficaz. Nesta exploração, não apenas buscaremos compreender a origem desse termo, mas analisaremos como o analfabetismo visual está intimamente ligado à falta de habilidades em decodificar e entender as mensagens transmitidas por meio de elementos visuais.
Segundo Hernández (2007), relativamente à origem e à finalidade das práticas pedagógicas, torna-se imperativo questionar e revisar aquelas que se estabeleceram como dogmas na educação. Reconstruir a gênese das práticas implica entender que o que existe pode ser revisado e substituído conforme evoluem as necessidades e propósitos da educação. Além disso, é fundamental considerar que a experiência escolar pode ser apaixonante, desafiadora e relevante. A escola não deve ser um ambiente entediante e desvinculado das experiências e questões significativas para os estudantes. Em vez disso, deve ser um espaço prazeroso, onde desafios, confrontos e questionamentos permitam o desenvolvimento da flexibilidade, surpresa e disposição ao risco.
Outro desafio crucial, de acordo com as práticas pedagógicas no ensino de Arte, é romper com a homogeneização imposta na escola (Hernández, 2007). A prática de todos realizarem os mesmos exercícios e repetirem respostas únicas perpetua a conformidade ao sistema educacional. A visão unidimensional de ingressar no sistema produtivo ou alcançar a universidade limita as possibilidades da educação para todos em um mundo incerto, onde as subjetividades estão em constante transformação. Assim, é essencial promover a pluralidade e enxergar as diferenças como uma riqueza e não como um problema. A valorização das diversas vozes e perspectivas na educação é crucial para construir um ambiente que respeite e aproveite a diversidade, preparando os estudantes para um futuro complexo e multifacetado.
Num mundo saturado por uma profusão de informações visuais, que vão de gráficos, mapas, símbolos e outras formas de comunicação visual, a habilidade de decodificar e extrair significado desses elementos tornou-se uma habilidade essencial para uma vivência plena na sociedade. No entanto, para muitas pessoas essa tarefa constitui um verdadeiro desafio que podemos descrever com o termo "analfabetismo visual".
A tradição associa a alfabetização à capacidade de ler e escrever, mas é imperativo ampliar esse conceito. A origem do termo "analfabetismo visual" está na expansão da alfabetização para além das palavras. Reconhecemos que a capacidade de interpretar elementos visuais é tão crucial quanto a habilidade de decifrar palavras. Assim, a expressão surge como uma resposta à realidade de indivíduos que enfrentam desafios na decodificação e compreensão de mensagens apresentadas visualmente (Hernández, 2007).
Ao mergulharmos nas origens do termo, encontramos a contribuição de Rudolf Arnheim, psicólogo e teórico da arte. Arnheim argumenta que a forma como percebemos visualmente o mundo impacta diretamente nossa compreensão das informações (Arnheim, 1954). Portanto, o analfabetismo visual pode ser entendido como uma desconexão entre a percepção visual e nossa capacidade de construir significados. A psicologia da percepção visual emerge como uma lente valiosa para compreender as raízes desse desafio.
Dondis (2007) contribui para a exploração do analfabetismo visual destacando a importância da alfabetização visual. Dondis discute como a disposição e a organização de elementos visuais contribuem para a comunicação eficaz. O termo, assim, não apenas denota a incapacidade de interpretar imagens isoladas, mas, também, aponta para a dificuldade em decifrar a linguagem visual complexa que permeia nossa sociedade.
Scott McCloud (1993) e Neil Cohn (2013) ampliam essa discussão, ao explorar a cognição visual por meio dos quadrinhos. Eles argumentam que a compreensão de uma história visual requer habilidades cognitivas específicas e a falta dessas habilidades pode resultar em dificuldades na interpretação de narrativas visuais complexas. Ao desdobrar as páginas dos quadrinhos, McCloud e Cohn oferecem insights sobre como o analfabetismo visual não é apenas a incapacidade de decodificar elementos visuais isolados, mas, ainda, a dificuldade em seguir narrativas visuais intrincadas.
Marshall McLuhan, teórico da mídia, destaca a influência dos meios de comunicação na percepção e compreensão da realidade. Em uma sociedade onde imagens e vídeos dominam os meios de comunicação, a interpretação rápida e precisa de informações visuais torna-se essencial. Indivíduos que enfrentam analfabetismo visual podem, assim, estar em desvantagem ao navegar por um mundo saturado de imagens, onde a interpretação visual é uma habilidade indispensável (McLuhan, 1994). McLuhan (1994) destaca a influência dos meios de comunicação na percepção e compreensão da realidade, fornecendo uma base conceitual para compreender a importância da interpretação visual em uma sociedade saturada de mídia visual.
Em síntese, este artigo descreve as camadas invisíveis do analfabetismo visual, cuja origem reside na necessidade de ampliar o conceito de alfabetização, para além das palavras e reconhecer a importância da interpretação visual na sociedade contemporânea. Ao examinar as contribuições de Citelli, Arnheim, Bordenave, Munari, Cohn, Dondis, Hernández, Gombrich, McCloud e McLuhan serão compreendidas as complexidades desse desafio. Nos trechos subsequentes, o entendimento do analfabetismo visual será aprofundado, investigando não apenas suas origens, mas os caminhos para superar essas barreiras visuais e promover uma sociedade onde a linguagem visual seja acessível para todos.
DESENVOLVIMENTO
Desafios da compreensão visual na sociedade contemporânea
Vivemos em uma era saturada por uma proliferação incessante de informações visuais, onde gráficos, mapas, símbolos e outras formas de comunicação visual compõem a paisagem do nosso cotidiano. A habilidade de decodificar e extrair significado desses elementos tornou-se uma competência essencial para uma participação plena na sociedade contemporânea. Contudo, para muitos, essa tarefa se transforma em um verdadeiro desafio, delineando o fenômeno que conhecemos como "analfabetismo visual".
Em seu livro "Linguagem e Persuasão", Adilson Citelli (2005) explora, de maneira abrangente e crítica, a interseção entre a linguagem e o processo persuasivo, oferecendo insights profundos sobre como as estratégias comunicativas influenciam a construção de significados e a formação de opiniões na sociedade contemporânea.
Num contexto em que as mensagens são frequentemente transmitidas por meio de representações visuais, desde simples ícones em dispositivos eletrônicos até complexos gráficos estatísticos, a aptidão para interpretar e compreender essas informações torna-se uma habilidade indispensável. No entanto, uma parcela significativa da população enfrenta obstáculos substanciais nesse processo, e o termo "analfabetismo visual" emerge para descrever a dificuldade ou incapacidade de decodificar adequadamente essas mensagens visuais.
Um dos principais desafios reside na sobrecarga de estímulos visuais a que estamos constantemente expostos. A multiplicidade de plataformas digitais, cada uma apresentando informações de maneiras distintas, contribui para a complexidade desse cenário. A rapidez com que somos confrontados por imagens e símbolos, muitas vezes sem o contexto adequado, pode resultar em uma sensação de sobrecarga cognitiva, dificultando a absorção e a interpretação eficaz das mensagens visuais. Citelli (2005), ao explorar as intricadas relações entre linguagem e persuasão, encontra eco nas reflexões de Hernández sobre as visualidades no mundo contemporâneo, destacando a complexa interação entre comunicação verbal e não verbal na construção de significados e na influência sobre as percepções na sociedade atual.
Além disso, a falta de educação formal sobre alfabetização visual acentua os desafios. Enquanto a sociedade contemporânea exige uma habilidade cada vez maior na interpretação de gráficos, infográficos e outros recursos visuais, a ausência de uma instrução adequada deixa muitos indivíduos à deriva nesse mar de símbolos e representações. A alfabetização visual não é apenas uma questão de decodificação, mas também envolve a capacidade de contextualizar, analisar criticamente e extrair significado das informações apresentadas visualmente. Em seu livro “O que é comunicação?”, Juan Bordenave (1982) dialoga de maneira significativa com a atualidade, especialmente quando consideramos os desafios relacionados à alfabetização visual. Em um mundo contemporâneo que exige habilidades crescentes na interpretação de recursos visuais, a falta de educação formal acentua as dificuldades, o que propicia a muitos indivíduos perderem-se entre visualidades. A alfabetização visual, como discutida por Bordenave, transcende a decodificação, envolvendo também a capacidade crucial de contextualizar, analisar criticamente e extrair significado das informações apresentadas visualmente.
Outro desafio crucial é a diversidade cultural que permeia a sociedade. Símbolos e códigos visuais podem ter significados variados em diferentes contextos culturais, levando a interpretações equivocadas ou a uma compreensão distorcida das mensagens. A globalização trouxe consigo uma interconexão visual, mas a compreensão efetiva dessas representações demanda uma sensibilidade cultural que, muitas vezes, é subestimada.
Nesse panorama desafiador, é imperativo promover a alfabetização visual como uma competência fundamental. Iniciativas educacionais que visam desenvolver habilidades de interpretação visual desde as fases iniciais da formação escolar podem ajudar a mitigar os desafios enfrentados pela população. Além disso, a conscientização sobre a importância da alfabetização visual e a promoção de ambientes que incentivem a compreensão crítica das informações visuais são passos essenciais para superar o analfabetismo visual na sociedade contemporânea.
Em última análise, os desafios na compreensão visual na sociedade contemporânea não são apenas obstáculos individuais, mas também questões sociais que exigem uma abordagem holística. Ao reconhecer e abordar esses desafios, podemos aspirar a uma sociedade onde a linguagem visual seja uma ferramenta acessível e compreendida por todos. Conforme expresso por Hernández, a complexidade dos desafios na compreensão visual na sociedade contemporânea vai além de obstáculos individuais, representando questões sociais que requerem uma abordagem holística. Ao reconhecer e enfrentar esses desafios, buscamos uma sociedade onde a linguagem visual seja não apenas acessível, mas também compreendida de maneira universal.
Expansão da alfabetização: para além das palavras escritas
Na tessitura da sociedade contemporânea, onde a comunicação se desdobra em uma multiplicidade de formas, a alfabetização não pode ser confinada apenas ao domínio das palavras escritas. A expansão desse conceito é imperativa, reconhecendo que a habilidade de interpretar e criar significado a partir de elementos visuais é tão essencial quanto a leitura e a escrita tradicionais. A expansão do conceito de alfabetização para abranger a habilidade de interpretar e criar significado a partir de elementos visuais, reconhecendo sua importância equiparada à leitura e à escrita tradicionais, encontra eco nas obras de diversos autores, entre eles Hernández, Bordenave, Dondis e Arnheim. Hernández, em suas contribuições, destaca a necessidade de uma abordagem holística na compreensão visual na sociedade contemporânea, sublinhando que a interpretação de elementos visuais vai além de desafios individuais, abrangendo questões sociais. Bordenave, por sua vez, examina as práticas pedagógicas e a comunicação, evidenciando a importância de questionar e reconstruir concepções educacionais. Dondis (2007) ressalta a relevância da alfabetização visual, enquanto Arnheim (1954), como teórico da arte, enfoca a percepção visual como essencial para a compreensão de informações. A convergência de suas perspectivas contribui para um entendimento mais abrangente da necessidade crítica de ampliar o conceito de alfabetização na era contemporânea.
A origem dessa necessidade de expansão remonta à crescente saturação de informações visuais em nosso cotidiano. Gráficos, mapas, símbolos e outras formas de comunicação visual moldam a maneira como percebemos e interagimos com o mundo ao nosso redor. Ignorar a alfabetização visual significa limitar a compreensão de uma parte significativa da linguagem contemporânea.
Rudolf Arnheim (1954), com suas contribuições para a psicologia da percepção visual, nos alerta sobre a importância de compreender como percebemos e interpretamos o mundo visualmente. A alfabetização visual não é apenas sobre o reconhecimento de imagens, mas também sobre a compreensão das relações entre essas imagens e a formação de significado.
Dondis (1974) ressalta a necessidade de entender a organização e disposição dos elementos visuais. Isso vai além da simples identificação de objetos; trata-se de decifrar como esses elementos interagem para criar uma narrativa visual coerente. A alfabetização visual, portanto, engloba a capacidade de "ler" a sintaxe das imagens, compreendendo a gramática visual que guia a comunicação visual eficaz.
Ao considerar a expansão da alfabetização, não podemos ignorar a contribuição de autores que exploram a cognição visual, como em Cohn (2013) e McCloud (1993). Suas investigações sobre a linguagem visual em quadrinhos destacam que a compreensão de uma narrativa visual requer habilidades cognitivas específicas. Essa perspectiva sublinha a complexidade da alfabetização visual, indo além da simples identificação de elementos visuais para abranger a interpretação de narrativas visuais complexas.
No contexto atual, em que a mídia digital desempenha um papel proeminente, Marshall McLuhan (1994) alertou sobre o impacto dos meios de comunicação na percepção e compreensão da realidade. A alfabetização visual torna-se crucial na era da mídia, onde a interpretação rápida e precisa de informações visuais é essencial para a participação plena na sociedade.
A expansão da alfabetização para além das palavras escritas é um chamado para reconhecer a importância da linguagem visual na comunicação contemporânea. A falta de habilidades em decodificar e interpretar informações visuais representa não apenas uma lacuna na educação, mas também uma limitação na participação efetiva na sociedade moderna.
Em síntese, a alfabetização visual é a ponte para uma compreensão mais profunda e abrangente da linguagem contemporânea. Expandir a alfabetização para além das palavras escritas significa capacitar os indivíduos a navegar eficientemente no oceano de informações visuais, o qual define o nosso mundo, e promover uma sociedade onde a comunicação visual é uma habilidade essencial para todos.
A psicologia da Percepção Visual de Arnheim: desvendando as camadas da compreensão
Rudolf Arnheim, renomado psicólogo e teórico da arte, lançou uma luz única sobre a complexidade da percepção visual e suas implicações para a compreensão do mundo ao nosso redor. Sua obra não apenas desafia as fronteiras tradicionais entre a psicologia e a arte, mas também redefine a maneira como consideramos a relação entre a percepção visual e a interpretação cognitiva.
No cerne da contribuição de Arnheim está a ideia de que a forma como percebemos o mundo visualmente desempenha um papel crucial em como compreendemos e interpretamos as informações. Em outras palavras, a psicologia da percepção visual, conforme delineada por Arnheim, propõe que nossa percepção não é apenas um processo sensorial, mas um ato complexo que influencia diretamente nossa construção de significado.
Arnheim (1954) argumenta que a percepção visual vai além da simples identificação de objetos; ela envolve a compreensão da relação entre esses objetos e sua representação mental. Por exemplo, ao olhar para uma obra de arte, não apenas reconhecemos os elementos visuais, mas também atribuímos significado a partir da maneira como esses elementos interagem e se organizam. Essa abordagem transcende a mera observação superficial e adentra as camadas mais profundas da cognição visual.
Ao explorar a psicologia da percepção visual, Arnheim destaca a importância da “gestalt”, um conceito que enfatiza a tendência natural da mente humana de organizar elementos visuais em padrões significativos e coerentes. Essa organização gestáltica não apenas simplifica a experiência visual, mas também ressalta a importância de entender como percebemos relações e formas em nossa percepção cotidiana.
A aplicação prática dessas ideias vai além do campo artístico. Arnheim sugere que a compreensão da psicologia da percepção visual é vital para diversas áreas, desde o design gráfico até a arquitetura. Reconhecer como as pessoas percebem e interpretam visualmente o ambiente ao seu redor é fundamental para criar experiências significativas e comunicar-se eficazmente por meio de elementos visuais.
A visão de Arnheim também oferece insights valiosos sobre a relação entre a percepção visual e a construção de significado. A forma como vemos o mundo não é apenas uma resposta passiva aos estímulos visuais, mas uma atividade interpretativa ativa que influencia a forma como atribuímos sentido às experiências. Essa perspectiva é fundamental para entender não apenas a arte, mas também como a percepção visual molda nossa compreensão mais ampla da realidade.
Em suma, a psicologia da percepção visual de Arnheim representa um mergulho profundo nas complexidades da mente humana e sua interação com o mundo visual. Sua abordagem vai além das fronteiras disciplinares, conectando a psicologia à arte e à experiência visual cotidiana. Ao desvendar as camadas da compreensão visual, Arnheim nos convida a explorar as nuances da percepção e a apreciar a riqueza da interação entre mente e imagem.
Alfabetização visual e organização da Linguagem Visual por Dondis: uma exploração profunda
Donis A. Dondis (1974), renomada teórica da comunicação visual, deixa um legado duradouro ao desbravar as intrincadas conexões entre a alfabetização visual e a organização da linguagem visual. Suas obras não apenas fundamentam os princípios da comunicação visual, mas também oferecem uma compreensão única de como a disposição e organização de elementos visuais são fundamentais para a transmissão eficaz de mensagens.
No cerne da abordagem de Dondis, está a ideia de que a comunicação visual é uma linguagem por si só, com uma gramática e uma sintaxe específicas, que devem ser compreendidas para uma interpretação precisa. A alfabetização visual, portanto, vai além do simples reconhecimento de imagens; envolve a capacidade de "ler" a organização espacial dessas imagens para extrair significado.
Dondis argumenta que a disposição dos elementos visuais não é arbitrária, mas segue padrões específicos que influenciam a maneira como percebemos e interpretamos as mensagens. Em outras palavras, a organização da linguagem visual é uma parte intrínseca da narrativa visual, afetando como as informações são transmitidas e recebidas. Essa perspectiva reforça a ideia de que a alfabetização visual não se trata apenas de decodificação, mas também da compreensão da "gramática" única que governa a comunicação visual.
A autora enfatiza a importância da gestalt na organização visual. Assim como Arnheim, Dondis reconhece a tendência natural da mente humana em organizar elementos visuais em padrões significativos. A compreensão dessa gestalt visual é vital para a alfabetização, pois ela permite uma leitura mais fluida e uma interpretação mais intuitiva da mensagem visual.
A aplicação prática desses conceitos vai além do design gráfico. Dondis destaca a relevância da sintaxe visual em áreas como publicidade, cinema e design de interfaces. A capacidade de organizar elementos visuais de maneira eficaz não apenas aumenta a estética, mas também melhora a eficácia comunicativa. A alfabetização visual, quando combinada com a compreensão da organização da linguagem visual, capacita os indivíduos a transmitirem mensagens visualmente de maneira impactante e coerente.
Além disso, Dondis destaca a importância do contexto na interpretação visual. A mesma imagem pode ter significados distintos dependendo do contexto em que é apresentada. Essa ênfase na contextualização é fundamental para uma alfabetização visual completa, pois reconhece que a compreensão visual vai além dos elementos individuais, envolvendo a consideração do todo.
Em resumo, a contribuição de Donis A. Dondis para o campo da alfabetização visual e organização da linguagem visual é inspiradora. Sua obra proporciona uma compreensão abrangente de como a disposição de elementos visuais e a compreensão da gramática visual são essenciais para uma comunicação visual eficaz. Ao explorar a interseção entre alfabetização visual e organização visual, Dondis nos convida a decifrar as complexidades da linguagem visual e a apreciar a profunda influência que essa compreensão pode ter na maneira como percebemos e interagimos com o mundo visual ao nosso redor.
Desdobrando as páginas dos quadrinhos: Cohn e McCloud na cognição visual
Neil Cohn e Scott McCloud, figuras proeminentes no estudo da cognição visual, lançam luz sobre o intrincado mundo dos quadrinhos, desdobrando as páginas para revelar as complexidades subjacentes à interpretação e compreensão de narrativas visuais. Suas contribuições não apenas transcendem as fronteiras entre a arte e a cognição, mas também oferecem uma visão profunda sobre como a mente humana processa e assimila informações visuais complexas.
O trabalho de Cohn (2013) destaca-se ao explorar a cognição visual por meio da linguagem dos quadrinhos. Ao analisar como as pessoas percebem e interpretam sequências visuais, Cohn oferece uma visão valiosa sobre as habilidades cognitivas necessárias para compreender narrativas visuais não lineares. Sua pesquisa sugere que a cognição visual é fundamental para desdobrar as camadas de significado em quadrinhos, indo além da mera apreciação estética para adentrar as nuances da interpretação narrativa.
Scott McCloud (1993), por sua vez, expande a discussão ao teorizar sobre a natureza da linguagem dos quadrinhos em "Understanding Comics", que é uma obra desse autor na qual ele explora profundamente a linguagem dos quadrinhos. McCloud argumenta que os quadrinhos não são apenas uma forma de entretenimento, mas uma forma única de comunicação visual, com sua própria gramática e sintaxe. Ele descreve a linguagem dos quadrinhos como uma combinação de imagens e texto, na qual as relações entre os quadros, a escolha de estilo artístico, o uso de espaço, e a interação entre texto e imagem criam significados únicos. Ele diz que a combinação única de imagens e texto cria uma forma de comunicação visual única, com sua própria gramática e sintaxe. Desdobrar as páginas dos quadrinhos, para McCloud, é desvendar um sistema complexo de representação visual que envolve não apenas a interpretação de imagens isoladas, mas também a compreensão da interação dinâmica entre essas imagens ao longo de uma sequência.
Ambos os teóricos convergem para a ideia de que a leitura de quadrinhos é uma experiência cognitiva sofisticada. A compreensão de uma história visual requer não apenas o reconhecimento de imagens, mas também a capacidade de sintetizar informações ao longo do tempo e do espaço. Desdobrar as páginas dos quadrinhos, portanto, é mais do que uma simples observação visual; é uma imersão na linguagem única que combina elementos visuais e narrativos, para criar significado, e que foi utilizada com os alunos do 7º ano do Ensino Fundamental do Colégio Militar de Brasília (CMB), em algumas atividades, cujo escopo foi exercitar a interação entre mente e imagem, como será apresentado em uma atividade mais adiante.
Ao desbravar as páginas dos quadrinhos, Cohn e McCloud revelam a complexidade das operações mentais envolvidas na interpretação visual. A cognição visual, nesse contexto, vai além da percepção superficial e envolve a capacidade de organizar, interpretar e sintetizar informações de maneira dinâmica. Isso destaca não apenas a importância dos quadrinhos como uma forma de arte única, mas também a necessidade de uma alfabetização visual que abranja a complexidade da comunicação visual em diversas mídias.
Em última análise, desdobrar as páginas dos quadrinhos, como proposto por Cohn e McCloud, é adentrar em um domínio onde a mente humana dança entre o visual e o narrativo. Suas teorias oferecem um guia valioso para compreender como a cognição visual é fundamental na apreciação e interpretação de narrativas visuais complexas. Ao desvendar as camadas dessa experiência única, Cohn e McCloud nos convidam a explorar o potencial cognitivo inexplorado presente nas páginas dos quadrinhos.
Desafios contemporâneos: McLuhan e a Era da Mídia Visual
Marshall McLuhan (1994), um visionário no campo da teoria da mídia, antecipou desafios cruciais na era contemporânea, especialmente no que diz respeito à transição para uma sociedade impregnada pela mídia visual. Suas análises penetrantes não apenas prenunciaram o advento da cultura visual, mas também delinearam os desafios que enfrentamos ao mergulhar cada vez mais fundo nesse oceano de imagens.
Em sua obra seminal "Os Meios de Comunicação como Extensões do Homem", McLuhan provocou uma mudança de paradigma ao introduzir o conceito de "aldeia global", preconizando que os meios de comunicação moldam e redefinem não apenas a forma como percebemos o mundo, mas também como nos relacionamos uns com os outros. McLuhan vislumbrou uma sociedade em que as barreiras temporais e espaciais seriam transcendidas pela onipresença da comunicação mediada por imagens.
No contexto contemporâneo, os desafios profetizados por McLuhan se manifestam de maneiras multifacetadas. A ascensão das redes sociais e a proliferação de plataformas digitais intensificaram a saturação de imagens em nossa vida cotidiana. A incessante exposição a imagens, muitas vezes fragmentadas e descontextualizadas, gera um ambiente propício para a chamada "narcose sensorial", onde a absorção constante de estímulos visuais pode resultar em uma compreensão superficial e fragmentada da realidade.
A capacidade de processamento rápido e simultâneo de informações visuais, característica da era da mídia visual, também trouxe consigo desafios cognitivos. A atenção fragmentada, estimulada por fluxos intermináveis de imagens em plataformas digitais, pode comprometer a profundidade da compreensão e análise crítica. McLuhan, ao destacar a influência da forma do meio na percepção, alertou para a necessidade de consciência sobre como os meios visuais moldam não apenas o que vemos, mas também como interpretamos o mundo ao nosso redor.
Outro desafio contemporâneo é a disseminação de notícias falsas e desinformação visual. McLuhan, ao antecipar a globalização da informação, alertou para a facilidade com que as imagens podem ser manipuladas para transmitir narrativas distorcidas. Na era das deepfakes (imagens ou áudios que foram manipulados de forma sofisticada por meio de técnicas de aprendizado profundo, deep learning, e inteligência artificial) e manipulação de imagens, a confiança na veracidade das representações visuais tornou-se uma questão premente, exigindo uma alfabetização visual mais sofisticada.
Além disso, a proliferação da mídia visual trouxe à tona questões de representação e diversidade. O poder das imagens na formação de opiniões e na construção de narrativas culturais destaca a necessidade crítica de considerar quem está representado e como nas diferentes formas de mídia visual. McLuhan, ao salientar a influência da mídia na percepção social, apontou para a responsabilidade de uma representação justa e equitativa na era visual.
Enfrentar os desafios contemporâneos na era da mídia visual, como previsto por McLuhan, exige uma abordagem abrangente que combine a conscientização sobre o impacto da mídia com uma alfabetização visual aprimorada. É imperativo não apenas consumir imagens de maneira crítica, mas também cultivar a capacidade de interpretar, contextualizar e questionar as mensagens visuais que permeiam nossa sociedade. A visão de McLuhan, que transcendeu seu tempo, continua a ressoar como um lembrete urgente da necessidade de navegar habilmente nas águas turbulentas da mídia visual contemporânea.
Parte Experimental
A dificuldade dos alunos do 7º ano do Ensino Fundamental em se expressar
A dificuldade dos alunos do 7º ano do Ensino Fundamental em se expressar e explicar imagens pode ser atribuída a uma variedade de fatores. Essa fase do desenvolvimento educacional é marcada por mudanças significativas na cognição, na linguagem e nas habilidades de comunicação, o que pode influenciar a capacidade dos alunos de interpretar e expressar visualmente.
Os alunos do 7º ano do CMB estão em uma fase de transição cognitiva, e alguns ainda estão desenvolvendo plenamente suas habilidades de pensamento abstrato e crítico. A capacidade de analisar e interpretar visualmente pode demandar um nível de maturidade cognitiva que nem todos atingiram nesse estágio.
A alfabetização visual é uma habilidade que precisa ser cultivada e ensinada. Muitos estudantes podem não ter recebido uma educação formal que os capacite a compreender e expressar informações visualmente. Isso inclui a falta de familiaridade com elementos como composição visual, simbolismo e estratégias de comunicação visual. Assim como há um vocabulário verbal, há um vocabulário visual que permite descrever e interpretar elementos visuais. Alunos podem enfrentar dificuldades em expressar suas ideias sobre imagens devido à falta de termos específicos para descrever elementos visuais, como cores, formas e layout.
A interpretação visual muitas vezes requer uma compreensão do contexto no qual uma imagem está inserida. Ao longo do 2º semestre de 2023, foram realizadas algumas oficinas de análise de obras com os alunos do 7º ano onde uma parte deles teve dificuldade em identificar elementos-chave e entender como esses elementos se relacionam dentro do contexto visual mais amplo.

Figura 1. Imagem de quadrinhos (Ciência Hoje, v. 5, nº 27, dez 1986 - Encarte). Imagem utilizada em uma das atividades onde os alunos deveriam explicar o que acontece no quadrinho, a partir de uma análise pessoal.
Alguns alunos sentiram insegurança ao expressar suas interpretações visualmente, especialmente os que não se sentiram confortáveis em compartilhar suas opiniões e temeram o julgamento dos colegas. A autoexpressão visual pode ser vista como mais desafiadora e intimidadora que a expressão verbal. A prática foi fundamental para desenvolver habilidades de comunicação visual (Figura 2). Alunos que não tiveram oportunidades regulares de praticar a interpretação de imagens e a expressão visual enfrentaram dificuldades em adquirir confiança e competência nessa área.

Figura 2. Atividade proposta pelo professor com base nas teorias de Hernández, Arnheim, Dondis, Cohn e McCloud.
A maneira como os conceitos visuais são apresentados em sala de aula pode influenciar a compreensão dos alunos. Se a abordagem pedagógica não enfatizar a importância da linguagem visual e não proporcionar atividades práticas, os alunos podem não desenvolver as habilidades necessárias. Isso tornou-se cada vez mais evidente no decorrer das aulas e das atividades de análise de obras que foram realizadas (Figura 3). Cada aluno é único, e as diferenças individuais, incluindo estilos de aprendizagem, interesses e experiências prévias, contribuíram para a variação na habilidade de expressar e explicar imagens.

Figura 3. Momento em que o professor explicava sobre visualidades no mundo contemporâneo e explorava os necessários questionamentos para compreender e se posicionar sobre uma imagem (de acordo com sua construção e contexto).
Em resposta a esses desafios, foi crucial adotar abordagens pedagógicas que promoveram a alfabetização visual, incentivando a prática regular da interpretação visual, como se deu no 2º semestre, e criaram um ambiente de aprendizado em que foi possível estimular a confiança e a expressão individual. A integração efetiva de atividades visuais no currículo, o feedback construtivo durante as aulas dialogadas e a promoção de discussões abertas foram estratégias benéficas para superar essas dificuldades.
RESULTADOS E DISCUSSÃO
As dificuldades dos alunos do 7º ano em se expressar e explicar imagens analisadas à luz das teorias de Jean Piaget e Lev Vygotsky
As dificuldades dos alunos do 7º ano em se expressar e explicar imagens podem ser analisadas à luz das teorias de Jean Piaget e Lev Vygotsky, dois influentes psicólogos do desenvolvimento cognitivo.
Piaget propôs que o desenvolvimento cognitivo ocorre em estágios sequenciais. Os alunos do 7º ano estão geralmente na fase das operações formais, quando começam a desenvolver o pensamento abstrato e lógico. A dificuldade que os alunos tiveram em expressar e explicar imagens refletiu desafios associados à consolidação dessas habilidades abstratas.
A perspectiva construtivista de Piaget destaca a importância da construção ativa do conhecimento pelo indivíduo. A dificuldade dos alunos foi relacionada à necessidade de construir um vocabulário visual e uma compreensão conceitual através da interação com o ambiente visual, algo que exigiu a orientação diante das experiências ocorridas.
Vygotsky introduziu o conceito de Zona de Desenvolvimento Proximal, que representa a diferença entre o que um aluno pode fazer independentemente e o que pode fazer com ajuda. A dificuldade em se expressar visualmente pode estar na Zona de Desenvolvimento Proximal (ZDP) sugerindo que os alunos podem se beneficiar de orientação e suporte para desenvolver suas habilidades visuais.
Vygotsky enfatiza a importância da mediação social no desenvolvimento cognitivo. Os desafios em expressar imagens foram abordados por meio de interações sociais durante as oficinas de análise, com discussões em grupo, quando os alunos tiveram a oportunidade de compartilhar perspectivas, aprender com os colegas e receber feedback construtivo. Vygotsky, também, destacou a importância da linguagem no desenvolvimento cognitivo. A dificuldade em expressar-se visualmente dos alunos durante o processo de aprendizagem foi relacionada à necessidade de desenvolver um vocabulário visual, e o uso da linguagem verbal foi fundamental para facilitar a articulação de pensamentos sobre imagens.
Vygotsky considerava a cultura e as ferramentas culturais como componentes cruciais do desenvolvimento. A dificuldade em interpretar e criar imagens refletiu diferenças nas experiências culturais e na familiaridade com ferramentas visuais específicas, como ocorreu durante o uso das projeções de obras de arte e de produções audiovisuais como o vídeo “Donald no país da matemágica”, disponibilizado gratuitamente na plataforma digital do YouTube.
Ambas as teorias de Piaget e Vygotsky enfatizam a importância da interação ativa com o ambiente, seja por meio de experiências práticas (Piaget) ou da mediação social (Vygotsky). Abordar as dificuldades dos alunos requereu um entendimento cuidadoso de seus estágios de desenvolvimento, a aplicação de estratégias pedagógicas que considerem a ZDP e a criação de ambientes que incentivaram a construção ativa do conhecimento visual nas aulas no auditório do CMB.
CONSIDERAÇÕES FINAIS
À medida que navegamos nas correntes da sociedade contemporânea, fica evidente que a necessidade de alfabetização visual é mais premente do que nunca. Este panorama de desafios e perspectivas, delineado por pensadores como Arnheim, Dondis, Cohn, McCloud e McLuhan, convergiu para uma conclusão incontestável: a capacidade de interpretar e comunicar por meio de elementos visuais é uma habilidade essencial para a plena participação na cultura contemporânea.
A alfabetização visual não é um mero complemento à alfabetização tradicional; é um elemento intrínseco à compreensão completa da linguagem e da comunicação na era atual, e isso fica cada vez mais evidente no dia a dia, como, por exemplo, o acesso “precoce” aos meios de comunicação e recursos audiovisuais (tablets, celulares, computadores e outros).
A partir do ano 2000 até os dias atuais, passou a ser cada vez mais comum crianças, às vezes com menos de um ano, interagindo com aparelhos celulares e tablets. Arnheim nos mostrou a importância da psicologia da percepção visual, enquanto Dondis destacou a necessidade de entender a organização da linguagem visual. Cohn e McCloud, por sua vez, desvendaram as complexidades da cognição visual e da linguagem única dos quadrinhos, e isso ficou evidente nas experiências com os alunos do 7º ano do CMB, em especial na atividade em que eles foram conduzidos a se expressar sobre uma imagem de uma tirinha em quadrinhos. McLuhan, como um profeta da era da mídia visual, antecipou os desafios que enfrentamos na aldeia global, onde a saturação de imagens demanda uma consciência crítica e isso foi possível identificar durante as trocas de informações nas aulas dialogadas com recursos audiovisuais.
Os desafios contemporâneos da mídia visual, como a sobrecarga de informações, a disseminação de desinformação e a necessidade de representação equitativa, ressaltam a urgência de uma alfabetização visual aprimorada. Não se trata apenas de reconhecer imagens, mas de compreender a gramática visual, decodificar a sintaxe da imagem e interpretar narrativas visuais complexas. É a capacidade de ir além da superfície das imagens, contextualizando-as, analisando-as criticamente e reconhecendo seu poder na construção de significados culturais e sociais.
A falta de alfabetização visual não é apenas uma lacuna individual, mas uma lacuna na participação plena na sociedade contemporânea. A habilidade de interpretar gráficos, compreender narrativas visuais, analisar imagens e reconhecer representações culturais é crucial para a cidadania informada e para a participação efetiva em um mundo saturado por mídia visual.
Portanto, a conclusão é clara: a alfabetização visual é uma necessidade urgente que transcende os limites das disciplinas específicas. É um chamado para educadores, formuladores de políticas públicas, profissionais da mídia e a sociedade em geral. É uma jornada que nos leva além das palavras escritas para desvendar as camadas invisíveis da comunicação visual, capacitando-nos a decifrar, interpretar e, por fim, fluir de maneira significativa nas águas da cultura visual contemporânea.
REFERÊNCIAS
ARNHEIM, R. (1954) Art and visual perception: a psychology of the creative eye. University of California Press.
BORDENAVE, J. E. D. (1982) O que é comunicação? Coleção Primeiros Passos. São Paulo: Editora Brasiliense.
CMB - Colégio Militar de Brasília (2023) Plano de Conferências e Palestras. In: Plano Geral de Ensino. Brasília: CMB, p. 12-13.
CMB - Colégio Militar de Brasília (2023) Plano Geral de Ensino - Colégio Militar de Brasília. Brasília: CMB, 64p.
CITELLI, A. (2005) Linguagem e Persuasão. 3ª impr - São Paulo: Editora Ática.
COHN, N. (2013). The Visual Language of Comics: introduction to the structure and cognition of sequential images. A&C Black.
DEPA - Diretoria de Educação Preparatória e Assistencial (2015) Projeto Pedagógico do Sistema Colégio Militar do Brasil. Disponível em: <https://www.depa.eb.mil.br/images/legislacao/projeto_pedagogico.pdf>. Acesso em: 28 nov. 2023.
DONDIS, D. A. (1974) A primer of visual literacy. Mit Press.
DONDIS, D. A. (2007) Sintaxe da Linguagem Visual. São Paulo: Martins Fontes.
GOMBRICH, E. H. (1995) A História da Arte. Rio de Janeiro: LTC Editora.
HERNÁNDEZ, F. (2007) Catadores da Cultura Visual. Proposta para uma nova narrativa educacional. Porto Alegre: Editora Mediação.
MCLOUD, S. (1993) Understanding Comics. Nova York: Kitchen Sink.
MCLUHAN, M. (1994) Understanding media: the extensions of man. MIT press.
_______________________________________________
1Professor de Artes (CMB), Bacharel e licenciado em Artes Plásticas (UnB). Email:

Biotecnologia, você sabe o que é?
Jéssica Carrijo de Souza1
RESUMO
A Biotecnologia é uma ciência interdisciplinar presente no nosso cotidiano que, ao longo dos anos, com o desenvolvimento de diversas ferramentas biotecnológicas, foi responsável por uma parte dos avanços obtidos na sociedade. Ainda com pouco destaque da sua real importância, talvez seja missão dos atuais estudantes tornar essas informações mais acessíveis à comunidade. No entanto, para se transmitir o conhecimento de forma correta, é necessário compreender a relevância e consolidar os conceitos biotecnológicos. Essa base pode ser construída durante o período do Ensino Médio, que é quando se estuda a sequência didática Biotecnologia. Com a discussão adequada dos temas, além de um completo esclarecimento, o aluno desenvolverá pensamento crítico. Este estudo objetivou diagnosticar a percepção que os alunos têm a respeito da Biotecnologia, de modo a destacar a importância de construir um alicerce forte, durante o Ensino Médio, para o surgimento de futuros cidadãos com pensamento crítico.
Palavras-chave: Ferramentas biotecnológicas. Desenvolvimento acadêmico. Sequência didática.
ABSTRACT
Biotechnology is an interdisciplinary science present in our daily lives that, over the years, with the development of different biotechnological tools, has been responsible for some of the advances in society. Even though its real importance is still underestimated, perhaps it is the mission of current students to make this information more accessible to the community. However, to transmit knowledge correctly, it is necessary to understand its relevance and consolidate biotechnological concepts. This concept can be built during high school, when the didactic sequence biotechnology is studied. With proper discussion of the issues and complete clarification, the student will develop critical thinking. The aim of this study was to diagnose students' perceptions of biotechnology in order to highlight the importance of building a strong foundation during high school for the emergence of future citizens with critical thinking.
Keywords: Biotechnological tools. Academic development. Didactic sequence.
INTRODUÇÃO
Você já pensou como seria o mundo em que vivemos sem as facilidades e os avanços que a Biotecnologia nos proporcionam há milhares de anos? Na maioria das vezes, vivemos sem perceber o quão relevante é essa área do conhecimento para nossa vida cotidiana e para o desenvolvimento das sociedades. A Biotecnologia é a ciência que utiliza sistemas biológicos, organismos vivos ou seus derivados para criar ou modificar artigos ou processos para um uso específico, resultando no desenvolvimento de produtos que possam melhorar o modo de vida da sociedade (por meio de conhecimentos acadêmicos, experimentação e constante inovação) (ONU, 1992).
Conhecer e compreender a importância das ferramentas biotecnológicas no desenvolvimento social e econômico pode favorecer positivamente a vida das futuras sociedades. O momento considerado conveniente para a consolidação desse conhecimento seria durante o período escolar, especificamente no Ensino Médio, quando os alunos podem ser instruídos sobre a relevância desses processos e quais melhorias do dia a dia foram influenciadas, a partir dos avanços dessa área. Podendo o aluno ser incentivado a desenvolver ideias e projetos, na chamada Iniciação Científica no âmbito da Educação Básica e, em consequência, ser impulsionado a seguir as diversas carreiras científicas.
Mesmo sem um conhecimento formal, a Biotecnologia vem sendo desenvolvida desde 6.000 a.C., no entanto, sua definição foi estabelecida apenas em 1919, pelo engenheiro-agrônomo húngaro Karl Ereky (Bentahar et al., 2023). A partir de então, os avanços nessa área refletiram diretamente no desenvolvimento e na qualidade de vida da espécie humana. Um exemplo disso é quando observamos os números da população mundial. Na última estimativa da Organização das Nações Unidas, alcançou-se a marca de 7,8 bilhões de habitantes (ONU, 2022). Sem as inovações científicas, entre elas o avanço em Biotecnologia, não haveria como alimentar uma população desse porte. O advento dos organismos geneticamente modificados (OGMs), ou simplesmente transgênicos, destacando o milho, o trigo e a soja, possibilitou a produção necessária para suprir as demandas alimentares mundiais, além de poupar áreas de florestas nativas (Avery, 2004).
Mesmo que existam opiniões divergentes quanto à presença de transgênicos na alimentação humana, o que deve ser reconhecido é o fato de que, sem essa “bio+tecnologia” haveria a necessidade do avanço contínuo das fronteiras agropecuárias visando ao abastecimento da população mundial. O acesso a alguns conceitos e informações sobre produtos biotecnológicos ainda são restritos, de modo que uma maior divulgação mediante o engajamento dos estudantes, desde o Ensino Médio, pode possibilitar melhor esclarecimento e/ou surgimento de novas aplicações científicas.
No Plano de Execução Didática (PED) do Colégio Militar de Brasília, instrumento utilizado pelos coordenadores de disciplina para direcionar o conteúdo ministrado durante o ano escolar, o tema Biotecnologia é tratado como uma sequência didática, abordada no último ano do Ensino Médio (Formação Geral Básica - FGB) (DEPA, 2022). No PED estão programadas dez aulas, dentro do segundo trimestre, para abordar e integrar os assuntos no cotidiano dos alunos (DEPA, 2022). Tendo como objeto do conhecimento os seguintes assuntos: DNA recombinante (Engenharia Genética), transgênicos, células-tronco, teste de DNA e clonagem reprodutiva e terapêutica. Esses assuntos podem ser considerados primordiais para a iniciação dos alunos no tema da Biotecnologia. Os descritores apresentam uma abordagem bem específica para que os alunos possam se conscientizar sobre cada assunto estudado. Dentre os descritores, são propostas discussões de textos jornalísticos e/ou científicos acerca de determinado assunto, comparações dos aspectos positivos e negativos de algum método científico (como o uso da transgenia e a discussão ética sobre clonagem terapêutica, etc).
O objetivo deste artigo é corroborar a importância do estudo da sequência didática Biotecnologia, durante o Ensino Médio, de modo que o aluno possa ser capaz de desenvolver o pensamento/olhar crítico e o interesse em projetos de Iniciação Científica, ainda na Educação Básica, além de concorrer para o despertar de futuros pesquisadores que sejam comprometidos, dedicados e interessados no tema.
MATERIAL E MÉTODOS
Com a finalidade de levantar como os alunos do Ensino Médio entendem o tema Biotecnologia, foi aplicado um questionário utilizando a plataforma google forms, encaminhado aos alunos dos 1°, 2° e 3° anos do Ensino Médio, do Colégio Militar de Brasília. A resposta ao questionário foi de forma voluntária.
Foram elaboradas 10 questões, sendo que, em determinada questão, se o aluno respondesse SIM ao questionamento, ele seria direcionado para um questionário (1), e se respondesse NÃO, era redirecionado para outro questionário (2) (Figura1). As questões formuladas foram objetivas, em sua maioria com as alternativas para respostas sendo, Sim, Não ou Talvez. Foi elaborada, também, uma questão aberta discursiva onde se pedia para exemplificar um produto biotecnológico ou um avanço resultante dos processos biotecnológicos. Aos alunos que responderam que já haviam estudado sobre o tema, havia uma questão extra solicitando que definissem, de forma sucinta, a Biotecnologia. Duas outras questões tinham a intenção de observar se os alunos: (1) sabiam citar um exemplo de produto biotecnológico de forma livre/aberta; e (2) identificavam alguns itens em alternativas. A Figura 1 expõe o organograma do questionário aplicado, apresentando as questões. Os detalhes sobre as alternativas serão apresentados posteriormente.

Figura 1. Organograma do questionário aplicado aos alunos, apresentando os questionários 1 e 2. As questões com contorno verde foram questões abertas discursivas, as demais apresentavam alternativas.
Após a aplicação do questionário e as respostas dos alunos, os dados foram tabulados e usados como forma de diagnóstico para melhor compreensão/discussão.
RESULTADOS
Os questionários foram respondidos virtualmente por meio da leitura de um QR code (Quick Response code - código de resposta rápida). Nessa amostragem, obtivemos respostas de 102 alunos dos três anos escolares pesquisados. Os dados possibilitaram a compreensão parcial do nível de conhecimento a respeito do tema. A Tabela 1 apresenta em números as respostas obtidas em algumas das questões. Não foram apresentados os dados de todas as questões, apenas daqueles considerados mais relevantes. Foi possível observar padrões semelhantes para alunos do mesmo ano escolar.
Tabela I. Apresentação dos dados tabulados para algumas questões do questionário.

No questionário, após perguntar o ano escolar do aluno, e se esse fazia parte de algum clube de estudos, a questão seguinte abordava se o aluno já havia estudado o tema Biotecnologia? Caso fosse marcada a alternativa NÃO, ele era direcionado ao questionário tipo dois, onde as questões eram mais “suposições” (o que o aluno entendia intuitivamente). Isso poderia resultar em respostas tipo “chute”. Enquanto os que respondiam SIM eram direcionados ao questionário tipo um (onde as questões eram mais diretas).
Os alunos do 1° e 2° ano ficaram divididos quando questionados se já haviam estudado essa sequência didática, visto que o tema Biotecnologia só é abordado no 3° ano. Aos que responderam SIM, mesmo não tendo estudado oficialmente esse tema, justificaram a aquisição do conhecimento principalmente nos meios de comunicação e alguns poucos justificaram ter aprendido no colégio, cursinho ou estudos independentes. Contudo, em uma visão geral, os alunos dos dois anos iniciais responderam de forma positiva aos questionamentos fundamentais quanto à importância dos avanços biotecnológicos, do crescimento populacional relacionado a esses avanços e da importância das plantas transgênicas. De forma controversa, alguns alunos do 3° ano responderam não ter estudado o tema (5), apesar do questionário ter sido aplicado ao final do ano letivo. Porém, todos os alunos foram unânimes nas questões-chave já elencadas acima.
A respeito do conhecimento sobre a Iniciação Científica dos alunos do 1° ano, apenas um participa de um projeto; dos demais, 11 disseram que não participam, mas gostariam de participar, 15 gostariam de conhecer mais, 19 dizem não saber o que é, e escolheram a alternativa “não sei”, em vez de “gostaria de saber”. No 2° ano, dos 32 alunos que responderam, nove admitiram não saber o que é Iniciação Científica, mas que gostariam de conhecer; outros nove alunos alegaram não participar, mas gostariam, e 10 marcaram a opção “não sei”. Três marcaram a opção que participam de um projeto de Iniciação Científica. Apesar da baixa adesão dos alunos do terceiro ano, 13 dos 24 alunos dizem não saber o que é Iniciação Científica, nove dizem não participar, mas gostariam, e somente um gostaria de saber mais sobre a Iniciação Científica.
Para a questão aberta que pedia a exemplificação de um produto ou avanço biotecnológico, os alunos apresentaram diversos exemplos, tendo como maior destaque: transgênicos, vacinas, remédios/antibióticos, insulina, agrotóxicos e queijo. No infográfico apresentado na Figura 2, estão os exemplos que foram citados no questionário durante a pesquisa.

Figura 2. Infográfico contendo nuvem de palavras, referente aos exemplos apresentados pelos alunos na questão: “Você poderia dar um exemplo de um produto biotecnológico ou algum avanço resultante da Biotecnologia?” O tamanho da palavra está relacionado à frequência com que a mesma apareceu na pesquisa.
Quando perguntado de forma direcional, por meio de alternativas, quais dos itens eram produtos de Biotecnologia, houve palpites assertivos para a maioria dos itens, como pode ser observado na Figura 3. Porém, houve algumas exceções com citações de carro, telefone, computadores e outros eletrônicos como sendo um produto biotecnológico.

Figura 3. Gráfico com as respostas dadas à questão “Dos itens a seguir, qual seria um exemplo de produto(s) biotecnológico(s)?”, em número de alunos e porcentagem. Em (A): respostas dos alunos que marcaram NÃO, para a questão se já haviam estudado o tema Biotecnologia. Em (B): respostas dos alunos que marcaram SIM, se já haviam estudado o tema Biotecnologia. A alternativa com reticências representa telefone, computadores e outros eletrônicos.
DISCUSSÃO
Imaginar o mundo sem os avanços da Biotecnologia seria considerar um mundo sem vacinas, medicamentos, como a insulina recombinante, biofármacos, OGMs, fertilizantes e pesticidas, ou itens mais simples, do nosso dia a dia, como queijo, cerveja, vinho, pão, ou combustível etanol. Todos esses exemplos fazem parte da gama de possibilidades que foram geradas pela aplicação da Biotecnologia, ao longo dos anos.
Após analisar os dados obtidos da aplicação do questionário, o que se pode supor, visto que foi amostrada apenas por uma parcela dos alunos do Ensino Médio, é que, em regras gerais, os conceitos que os alunos possuem são suficientes para formar uma visão positiva sobre quão importante é a Biotecnologia, independente do ano escolar. Mesmo que alguns tenham usado uma resposta tipo “chute”, eles optaram pela melhor alternativa. Esses indícios fortalecem a possibilidade de jovens mais preparados, porém ainda é necessário consolidar as bases, onde uma dedicação e incentivo serão o alicerce.
Quanto ao interesse pela Iniciação Científica, os dados mostram pouca participação em projetos e um nível moderado de interessados (54) em saber o que é ou em participar. Esse mesmo nível moderado (39) abarcou alunos que disseram não ter nenhum interesse sobre Iniciação Científica. O que mais surpreendeu foi o baixo interesse dos alunos do 3° ano do Ensino Médio. Como possíveis justificativas pode estar a baixa adesão dos alunos em responder ao questionário, o baixo esclarecimento sobre o tema ou, ainda, o interesse em carreiras militares específicas.
Poucos alunos do total geral fazem parte de algum clube de estudo, inclusive do Clube de Estudos Ambientais, atividade extraclasse relacionada às Ciências Naturais (Silva & Fraga, 2018). Estudos ressaltam que a participação do aluno em atividades extraclasses e em projetos de Iniciação Científica, durante o período escolar, resulta em maior comprometimento com a escola e com a comunidade, além desse período introdutório apresentar-se muito importante no despertar para futuras carreiras científicas (Carra & Teston, 2014; Lorenzoni & Salgado, 2019).
O enfoque proposto pelos descritores no PED visa trazer o aluno para a realidade na qual ele está inserido. Quando as discussões são conduzidas da forma correta, estimulam o aluno a desenvolver o pensamento crítico, prepará-los para os vestibulares, sobretudo esse conteúdo que é recorrente nos exames para ingresso no Ensino Superior. Ainda, se o colégio possuir suporte para fomentar projetos de Iniciação Científica, dessas vivências podem surgir projetos científicos, os primeiros passos para uma carreira científica.
Além de um potencial direcionamento para o mundo da pesquisa científica, esses estudos promovem a formação de cidadãos mais críticos, capazes de compreender e interpretar as situações à sua volta. Especialmente se houver uma complementação dos estudos, correlacionando com a situação social, ambiental, econômica e interpessoal, para o melhor desenvolvimento de projetos que estejam ligados às necessidades atuais da sociedade. Desse modo caberá aos atuais alunos, quem sabe futuros cientistas, identificar essas questões e desenvolver soluções adequadas.
CONSIDERAÇÕES FINAIS
Foi possível observar que os assuntos abordados são o passo inicial para criar uma boa percepção da importância da Biotecnologia no desenvolvimento da nossa sociedade, nos dias atuais e futuros. Os objetos de conhecimentos podem ser considerados o alicerce se apresentados da forma correta, contribuindo, também, para que os alunos/cidadãos sejam capazes de argumentar com fundamentação sobre uma determinada ideia, podendo, ainda, divulgar esses conhecimentos no meio em que vivem.
A sequência didática Biotecnologia está incluída na Base Nacional Comum Curricular (BNCC), de modo que, em regras gerais, esse conteúdo é ministrado em todos os colégios, sejam eles públicos ou particulares. Assim, o que fará o aluno ampliar o pensamento crítico e despertar para as carreiras científicas será como esse conteúdo vai ser trabalhado em sala de aula. Os avanços biotecnológicos foram decisivos para o sucesso da sociedade, do passado até os dias atuais. A Biotecnologia constitui uma ferramenta essencial para uma sociedade bem desenvolvida, capaz de conciliar o equilíbrio entre o progresso e a sustentabilidade.
REFERÊNCIAS
BENTAHAR, S.; ABADA, R.; NADIA, P. Y. (2023) Biotechnology: definitions, types and main applications. YMER Digital, v. 22, n. 1, p. 563-575.
BRASIL (2018) Ministério da Educação. Base Nacional Comum Curricular. Brasília. Disponível em: <http://basenacionalcomum.mec.gov.br/> Acesso em: 24 ago. 2023.
CARRA, A.; TESTON, R. (2014) A importância da Iniciação Científica na escola: a formação de jovens pesquisadores no município de Ibiaçá. Colóquio Internacional de Educação, v. 2, n. 1, p. 763-774. Disponível em: <https://periodicos.unoesc.edu.br/coloquiointernacional/article/view/5114> Acesso em: 29 nov. 2023.
DEPA - Diretoria de Educação Preparatória e Assistencial (2022) Plano de Sequência Didática, 3° Ano EM - Ciências da Natureza e suas Tecnologias. Boletim interno DEPA Nr 61, de 12 de agosto de 2022.
LORENZONI, B. B.; SALGADO, T. D. M. (2019) A iniciação científica: escuta, diálogo e contexto. Retratos Da Escola, v. 13, n. 26, p. 513-521. Disponível em: <https://doi.org/10.22420/rde.v13i26.904> Acesso em: 29 nov. 2023.
ONU - Organização das Nações Unidas (1992) Convenção de Biodiversidade, Art. 2. Disponível em: <https://www.gov.br/mma/pt-br/textoconvenoportugus.pdf> Acesso em: 24 ago. 2023.
ONU - Organização das Nações Unidas (2022) Departamento de Assuntos Econômicos e Sociais, Divisão de População. Disponível em: <https://population.un.org/wpp/Download/Standard/Population/> Acesso em: 24 ago. 2023.
SILVA, A. S.; FRAGA, L. P. (2018) A Educação Ambiental no Colégio Militar de Brasília: referenciais e práxis pedagógicos do Clube de Estudos Ambientais. O Saber, v. 11, p. 161-175.
VAN MONTAGU, M. (2020) The future of plant biotechnology in a globalized and environmentally endangered world. Genetics and Molecular Biology, 43p.
_______________________________________________
1Professora de Biologia (CMB), Doutora em Biologia Molecular (UnB). Email:

O Ensino híbrido e o uso das tecnologias digitais no ensino de Artes Visuais: impactos na formação de professores e alunos
Vanessa de Carvalho Sardinha Santana da Silva1
|
“O melhor é pensar em termos de sujeito-objeto-sujeito: duas subjetividades criando uma realidade intercomunicável. Sentidos são bens humanos e não fenômenos naturais” (Marcuschi, 2002, p. 60) |
RESUMO
Este artigo revisa o impacto do ensino híbrido e das tecnologias digitais no ensino das Artes Visuais, destacando sua relevância no processo formativo de professores e alunos. Ao combinar métodos presenciais e on-line, o ensino híbrido proporciona oportunidades expandidas de aprendizado, gerando práticas pedagógicas inovadoras e potencializando, assim, o processo de ensino e aprendizagem das Artes Visuais. O papel do professor se transforma em um mediador do conhecimento, incentivando a curiosidade e a análise crítica das produções artísticas. Para os professores, a formação inclui a integração eficaz das tecnologias digitais, tanto no domínio técnico quanto na reflexão sobre seu uso educacional. Essa junção entre o ensino híbrido e as tecnologias digitais potencializa a experiência artística dos alunos, promove a colaboração e enriquece o processo educativo.
Palavras-chave: Ensino híbrido. Tecnologias digitais. Artes Visuais. Formação de professores. Aprendizagem significativa.
ABSTRACT
This article reviews the impact of hybrid teaching and digital technologies in Visual Arts education, highlighting their relevance in the formative process of both teachers and students. By combining in-person and on-line methods, hybrid teaching provides expanded learning opportunities, generating innovative pedagogical practices and enhancing the teaching and learning process in Visual Arts. The role of the teacher is transformed into a knowledge mediator, encouraging curiosity and critical analysis of artistic productions. Teacher training deals with the effective integration of digital technologies, encompassing technical mastery and reflection on their educational use. The integration of hybrid teaching and digital technologies enhances students' artistic experience, fosters collaboration, and enriches the educational process.
Keywords: Blended learning. Digital technologies. Visual Arts. Teacher training. Meaningful learning.
INTRODUÇÃO
O panorama educacional contemporâneo testemunha transformações significativas, impulsionadas pela integração do ensino híbrido e das tecnologias digitais, particularmente no contexto do ensino das Artes Visuais. Esta abordagem inovadora não apenas redefine as dinâmicas de aprendizagem, mas também reajusta o papel do arte/educador e a experiência educativa dos alunos. O presente artigo propõe uma reflexão sobre os impactos do ensino híbrido e do uso das tecnologias digitais no ensino de Artes Visuais, destacando sua relevância no processo formativo de professores e alunos.
A combinação do ensino presencial e on-line, característica central do ensino híbrido, oferece um terreno fértil para a expansão das possibilidades pedagógicas no campo das Artes Visuais. Essa abordagem proporciona um ambiente fluido que rompe as fronteiras físicas da sala de aula, abrindo portas para a exploração criativa, o acesso a um vasto repertório artístico e a interação com tecnologias de ponta. Consequentemente, a prática educacional é desafiada a se reinventar, demandando uma reflexão aprofundada sobre o papel do professor e as estratégias de ensino mais eficazes nesse contexto.
A formação de professores torna-se um ponto central nesse cenário em evolução. A capacitação dos educadores para a integração efetiva das tecnologias digitais não se restringe apenas ao domínio técnico, mas abarca a compreensão do potencial transformador dessas ferramentas no contexto do ensino das Artes Visuais. Nesse sentido, o presente artigo visa explorar como a formação continuada pode capacitar os professores a incorporar de maneira significativa as tecnologias digitais em suas práticas pedagógicas, visando não apenas ao aprimoramento do processo de ensino e aprendizagem, mas também como essas práticas influem no desenvolvimento integral dos alunos.
Assim, este artigo busca refletir sobre os impactos causados pelo ensino híbrido e o uso das tecnologias digitais no ensino de Artes Visuais, destacando a formação de professores e o desenvolvimento educacional dos alunos neste contexto. Essa compreensão é essencial para o avanço no campo educacional, especialmente diante dos desafios e oportunidades da era digital, buscando aprimorar continuamente a qualidade do ensino oferecido nas disciplinas de Artes Visuais.
DESENVOLVIMENTO
O ensino híbrido no contexto das Artes Visuais
Por vivermos em uma era digital, em constantes transformações sociais e culturais, na qual os alunos, nativos digitais2 Prensky, 2001), estão inseridos, é preciso que o ensino e as práticas pedagógicas em Artes Visuais acompanhem essas transformações. Isso inclui a utilização de metodologias ativas, que podem ser usadas pelos professores, para melhorar o processo de ensino-aprendizagem tornando o aluno responsável e protagonista da sua própria aprendizagem. O desafio do educador, nos dias atuais, é mediar a interação, a apropriação, a construção e a elaboração dos conhecimentos dos alunos com as tecnologias em sala de aula, como facilitadoras do ensino.
No ensino de Artes é importante colocar o aluno em contato com diferentes maneiras de expressar suas ideias, em constante estado de atenção e reflexão, para que amplie suas capacidades comunicativas e descubra suas próprias formas de utilizar os recursos existentes. É no diálogo entre as linguagens que cada um poderá se aprofundar no funcionamento das dinâmicas de composição da imagem a partir de suas próprias necessidades expressivas. É essencial que professores e instituições educacionais busquem novos caminhos, a fim de que a construção de conhecimentos aconteça a partir da realidade em que vivemos. Segundo Barbosa (2005, p. 110) “para compreender e fruir a arte produzida pelos meios eletrônicos, o público necessita de uma nova escuta e de um novo olhar”.
Nesse sentido, o ensino híbrido tem sido uma prática inovadora para o docente sendo que as variadas formas desse ensino nos permite adaptações metodológicas no processo educativo, com recursos diversos e nos espaços, pois o virtual e presencial também têm denominações contextualizadas, uma vez que a sala de aula invertida, por exemplo, pode ser representada em contextos e ambientes diversos.
Sendo assim, o ensino híbrido pode ser estruturado via atividades síncronas, nas quais o professor e os estudantes trabalham juntos, em um horário predefinido, de maneira on-line ou presencial, ou assíncrona, quando o aluno pode estudar em seu próprio tempo e velocidade, sem necessidade de estar com a turma ou o educador. O ensino híbrido busca unir os aspectos positivos das duas metodologias, a fim de oferecer melhores condições de aprendizagem para os alunos.
Ainda sobre a compreensão do conceito de híbrido, para Moran:
|
Híbrido significa misturado, mesclado, blended. A educação sempre foi misturada, híbrida, sempre combinou vários espaços, tempos, atividades, metodologias, públicos. Esse processo, agora, com a mobilidade e a conectividade, é muito mais perceptível, amplo e profundo: é um ecossistema mais aberto e criativo. Podemos ensinar e aprender de inúmeras formas, em todos os momentos, em múltiplos espaços. Híbrido é um conceito rico, apropriado e complicado. Tudo pode ser misturado, combinado, e podemos, com os mesmos ingredientes, preparar diversos “pratos”, com sabores muito diferentes (Moran, 2015, p. 22). |
Moran (2015) também resume algumas contribuições possíveis sobre o ensino híbrido, uma delas é o fato de o aluno poder assumir o papel de aprendiz proativo e participante, sujeito de suas ações e protagonista do seu aprendizado. E o professor nesse processo possui o significativo papel de mediador e orientador. Por isso, é tão importante uma mudança de entendimento e atitudes.
Sendo assim, as tecnologias digitais possibilitam configurar espaços de aprendizagem, nos quais o conhecimento é construído conjuntamente, porque haverá interatividade. Não há como pensar em educação sem troca, sem cocriação, sem interatividade como aspecto central.
Impacto na formação de professores
A formação dos professores desempenha um papel fundamental na implementação bem-sucedida do ensino híbrido e na integração eficaz das tecnologias digitais no contexto do ensino de Artes Visuais. A necessidade de capacitação contínua para os educadores é evidente, exigindo uma abordagem holística que englobe não apenas a familiarização com as ferramentas digitais, mas também uma compreensão aprofundada de como essas tecnologias podem ser utilizadas de maneira pedagogicamente relevante e transformadora.
Primeiramente, a formação dos professores deve abordar o domínio técnico das tecnologias digitais, incluindo o conhecimento e a habilidade para utilizar recursos digitais pertinentes para as Artes Visuais. Professores capacitados tecnicamente são capazes de guiar os alunos de forma mais eficaz, oferecendo suporte na exploração e utilização dessas ferramentas em seus processos criativos.
No entanto, além do domínio técnico, a formação dos professores deve englobar uma reflexão crítica sobre o uso pedagógico das tecnologias digitais. Os educadores precisam compreender como integrar essas ferramentas de forma significativa em seus planos de aula, promovendo a aprendizagem ativa e estimulando a criatividade dos alunos. Isso implica repensar estratégias de ensino-aprendizagem e criar ambientes que incentivem a experimentação, a expressão individual e a colaboração por meio das tecnologias.
Para isso, é necessário também que os docentes tenham uma base sólida de conhecimentos. A história do ensino da arte oferece um contexto valioso, permitindo compreender a evolução das práticas pedagógicas, os métodos de ensino, as abordagens artísticas e as mudanças sociais ao longo do tempo. Esse conhecimento histórico serve como alicerce para a prática docente contemporânea, fornecendo insights sobre como a arte foi percebida, ensinada e valorizada em diferentes períodos culturais.
Ao compreender as diferentes abordagens educacionais utilizadas ao longo da história para ensinar arte, um professor adquire uma visão ampla de estratégias e metodologias. Isso permite a criação de um repertório diversificado de práticas pedagógicas, adaptando-se melhor às necessidades e estilos de aprendizagem dos alunos.
Conhecer as mudanças que ocorreram ao longo dos anos, seus aprimoramentos e influências no processo de ensino de Arte, as reflexões sobre realidades sociais e profissionais, bem como as concepções e metodologias que refletem na prática são destacados por Ana Mae Barbosa (2008) como conhecimentos de grande relevância para o processo de ensino aprendizagem.
|
A falta de conhecimentos sobre o passado está levando os arte-educadores brasileiros a valorizarem excessivamente o “novo”. Tudo o que é considerado novidade é adotado entusiasticamente. Objetivos, métodos e estratégias supostamente “novos” vêm sendo sucessivamente introduzidos nas aulas de arte sem que haja qualquer preocupação com sua inter-relação. Esta falta de estrutura interna no ensino da arte, ensino este que se pretende inovador, está levando a uma concepção de arte como nonsense, uma espécie de fazer sem intenção (Barbosa, 2008, p. 33). |
Para Ferraz e Fusari (2010, p. 51) “[...] No caso do professor de Arte, sua prática-teoria artística e estética deve estar conectada a uma concepção de arte, assim como as consistentes propostas pedagógicas. Em síntese, ele precisa saber arte e saber ser professor de arte”. Segundo as autoras:
|
É atuar através de uma pedagogia mais realista e mais progressista, que aproxime os estudantes do legado cultural e artístico da humanidade, permitindo, assim, que tenham conhecimento dos aspectos mais significativos de nossa cultura, em suas diversas manifestações. E, para que isso ocorra efetivamente, é preciso aprofundar estudos e evoluir no saber estético e artístico (Ferraz & Fusari, 2010, p. 51). |
Além disso, a familiaridade com os conteúdos específicos da disciplina de arte é essencial para transmitir conhecimentos de maneira eficaz. Um professor que possui um conhecimento aprofundado sobre técnicas artísticas, movimentos culturais, obras e artistas reconhecidos é capaz de oferecer uma educação mais rica e estimulante. Essa expertise também possibilita ao professor despertar nos alunos a capacidade de análise crítica, interpretação e apreciação da arte em suas diversas formas, contribuindo para o desenvolvimento de uma visão mais sensível e culturalmente enriquecedora.
Ademais, o conhecimento da história do ensino da arte oferece uma compreensão mais ampla das políticas educacionais e das tendências contemporâneas, permitindo ao professor contextualizar o papel da arte na sociedade atual e preparar os alunos para enfrentar os desafios do mundo moderno.
Uma formação continuada que aborde todos esses aspectos é essencial para capacitar os professores a enfrentarem os desafios e explorarem as potencialidades oferecidas pelo ensino híbrido e pelas tecnologias digitais no contexto das Artes Visuais. Essa formação não apenas influencia diretamente a prática docente, mas também tem um impacto significativo na qualidade da experiência educacional, contribuindo para a formação de indivíduos mais criativos, reflexivos e culturalmente conscientes.
É importante também uma mudança nos modelos educacionais, pois os modelos tradicionais de ensino, em que o professor é considerado figura central e único detentor do conhecimento, e os alunos apenas reprodutores dos saberes, não atende aos anseios de uma sociedade em constante transformação e evolução. No contexto atual, há uma busca por modernizar o ensino, porém as tentativas trazem a tecnologia pela tecnologia em si, mas não buscam inovar os métodos e melhorar a qualidade do processo de ensino e aprendizagem.
Por isso, é tão importante que o arte/educador faça uso de práticas inovadoras de ensino ou busque uma ressignificação delas, repensando o ensino da arte e apresentando aos alunos novas formas de interagir e dialogar sobre o fazer arte na atualidade.
Maximizando a aprendizagem dos alunos por meio do ensino híbrido e das tecnologias digitais em Artes Visuais
A integração entre o ensino híbrido e as tecnologias digitais tem se revelado como um divisor de águas no campo da educação, especialmente no ensino das Artes Visuais. Essa interação, ao ser explorada, traz vastos e significativos benefícios para a aprendizagem dos alunos, proporcionando um ambiente educacional enriquecido e uma experiência mais dinâmica e envolvente. Segundo Moran (2007), as tecnologias têm um papel fundamental no processo de aprendizagem no sentido de despertar nos alunos o interesse em aprender.
Uma das vantagens mais notáveis é a expansão do acesso a recursos e materiais educativos. As tecnologias digitais abrem portas para um amplo universo artístico, permitindo que os alunos explorem galerias virtuais, obras de arte renomadas e técnicas diversas a partir de qualquer lugar. Isso amplia seus horizontes culturais, enriquece seu repertório visual e promove uma compreensão mais profunda e abrangente das formas de expressão artística. De acordo com Bacich, Neto e Trevisani (2015, p. 41), o uso de tecnologias digitais, no contexto escolar, propicia amplas possibilidades de atividades educacionais mais significativas para os seus participantes. Segundo os autores, o ensino híbrido insere a tecnologia digital no contexto escolar, sem a necessidade de derrubar paredes, mas quebrando as velhas formas de enxergar o ensino.
A interatividade, outra característica proporcionada pelas tecnologias digitais, é um fator que estimula o engajamento dos alunos. A possibilidade de criar, experimentar e manipular visualmente por meio de softwares específicos oferece uma plataforma ideal para a expressão criativa. A natureza prática e interativa dessas ferramentas motiva os alunos, tornando o processo de aprendizagem mais imersivo e cativante.
Outro benefício importante é a personalização do aprendizado. O ensino híbrido permite que os alunos avancem em seu próprio ritmo, revisitando conceitos ou explorando áreas de interesse de maneira mais aprofundada. A flexibilidade proporcionada pelas tecnologias digitais permite que os alunos assumam um papel mais ativo em sua própria aprendizagem, adaptando o processo de acordo com suas necessidades individuais.
A colaboração é outra vantagem inegável dessas ferramentas no ensino das Artes Visuais. Os alunos podem colaborar em projetos coletivos, compartilhar ideias, oferecer feedback e trabalhar em equipe, mesmo a distância. Isso promove habilidades sociais essenciais, além de enriquecer o processo criativo ao expor os alunos a diferentes perspectivas e estilos.
A avaliação também é aprimorada por meio das tecnologias digitais. Ferramentas interativas permitem uma avaliação mais detalhada e contextualizada das produções dos alunos. Os professores podem fornecer feedback mais específico e construtivo, focando não apenas no produto final, mas também no processo de criação, estimulando o desenvolvimento contínuo dos alunos.
Em síntese, o ensino híbrido, aliado às tecnologias digitais, potencializa a aprendizagem em Artes Visuais ao oferecer acesso expandido a recursos, estimular a criatividade, promover a personalização do aprendizado, fomentar a colaboração e aprimorar os processos de avaliação. Essas ferramentas não apenas enriquecem a experiência educacional dos alunos, mas também preparam indivíduos mais adaptáveis, criativos e aptos a enfrentar os desafios do mundo contemporâneo.
Desafios do ensino híbrido e das tecnologias digitais na aprendizagem em Artes Visuais
Embora o ensino híbrido e as tecnologias digitais ofereçam uma gama impressionante de benefícios, sua implementação na aprendizagem de Artes Visuais não está isenta de desafios. Esses desafios, muitas vezes, representam obstáculos significativos que exigem reflexão, adaptação e estratégias específicas para garantir uma experiência educacional eficaz e enriquecedora para os alunos.
Um dos desafios centrais é a necessidade de infraestrutura e acesso equitativo às tecnologias. Nem todos os alunos têm acesso igualitário a dispositivos digitais ou à internet de qualidade, o que pode criar disparidades na participação e no engajamento. Essa falta de acesso pode limitar a capacidade de alguns alunos de aproveitar plenamente os recursos digitais oferecidos, prejudicando sua experiência educacional.
Além disso, é sabido o quanto pode ser desafiador o caminho que nos leva ao aprendizado de novos conhecimentos. Nem todos os estudantes estão igualmente familiarizados ou confortáveis com o uso de tecnologias digitais, o que pode criar uma barreira inicial para a compreensão e a aplicação eficaz dessas ferramentas no contexto das Artes Visuais. Da mesma forma, professores podem enfrentar desafios ao integrar essas tecnologias em suas práticas pedagógicas, exigindo tempo e esforço para adquirir habilidades técnicas e conceituais.
Outro desafio é a gestão do tempo e do engajamento dos alunos. O ensino híbrido requer uma maior autonomia e autorregulação dos estudantes, que devem equilibrar as demandas do ensino presencial com as atividades on-line. A falta de supervisão direta pode levar à procrastinação ou à falta de participação ativa em ambientes digitais, afetando negativamente a aprendizagem e a realização de tarefas.
Ainda, a qualidade da interação pode ser comprometida no ambiente digital. A comunicação presencial é frequentemente substituída por interações virtuais, o que pode afetar a dinâmica das discussões em sala de aula e a capacidade dos alunos de se engajarem profundamente nos debates e atividades colaborativas.
Da mesma forma, a questão da avaliação também é um desafio. Avaliar o aprendizado e as produções dos alunos mediadas por tecnologias digitais requer uma abordagem diferenciada e mais criteriosa. Os métodos tradicionais de avaliação podem não ser adequados para capturar completamente o processo criativo ou o uso das ferramentas digitais, exigindo novas estratégias avaliativas que considerem essas nuances.
Por fim, o uso do ensino híbrido e das tecnologias digitais no ensino das Artes Visuais traz consigo desafios significativos relacionados à equidade de acesso, capacitação docente, gestão do tempo e engajamento, qualidade da interação e avaliação. Enfrentar esses desafios requer um compromisso contínuo com a adaptação, a inclusão, o desenvolvimento de habilidades digitais e a busca por estratégias pedagógicas inovadoras que permitam maximizar os benefícios dessas ferramentas enquanto se superam os obstáculos associados ao seu uso.
CONSIDERAÇÕES FINAIS
O avanço do ensino híbrido e a crescente integração das tecnologias digitais no ensino das Artes Visuais são reflexos da constante evolução do ambiente educacional, cheio de oportunidades, desafios e amplas possibilidades. É inegável o impacto positivo que essas ferramentas exercem na experiência educativa dos alunos e na prática pedagógica dos professores.
Ao longo deste artigo, tornou-se evidente que a incorporação dessas ferramentas amplia o acesso a recursos artísticos, promove a criatividade e a expressão do aluno, além de estimular a colaboração e a personalização do aprendizado, tornando-o proativo e participante, sujeito de suas ações e protagonista do seu aprendizado. Contudo, não podemos ignorar os desafios apresentados, como as disparidades quanto ao acesso às tecnologias, a capacitação dos professores, a gestão do tempo e o envolvimento dos estudantes. Tais questões demandam atenção e estratégias específicas para mitigar seus efeitos negativos.
Em suma, o ensino híbrido e o uso das tecnologias digitais no ensino de Artes Visuais representam um caminho promissor para aprimorar a experiência educacional, capacitando alunos e professores a explorarem novos horizontes, estimularem a criatividade e se adaptarem às demandas de um mundo em constante evolução tecnológica. É através do equilíbrio entre os desafios e os benefícios que se constrói uma abordagem educacional mais dinâmica, inclusiva e eficaz para o ensino das Artes Visuais.
Por fim, rememoro as reflexões de Moran (2015) sobre os diversos “pratos” e “sabores” possibilitados através de uma escola aberta e integrada com o mundo vivo que o digital traz. Talvez essa seja a grande questão de que carece a educação nos dias de hoje: perceber um novo “sabor para o ato de ensinar e aprender”. Esse é o desafio de todos os envolvidos no contexto educacional.
REFERÊNCIAS
BACICH, L.; TANZI NETO, A.; TREVISANI, F. M. (2015) Ensino híbrido: personalização e tecnologia na educação. Porto Alegre: Penso, 41p.
BARBOSA, A. M. (2005) Dilemas da Arte/Educação como mediação cultural em namoro com as tecnologias contemporâneas. In: Ana Mae Barbosa (Org.). Arte/Educação contemporânea: consonâncias internacionais. São Paulo: Cortez, 110p.
BARBOSA, A. M. (2008) Ensino da Arte: memória e história. São Paulo: Perspectiva, 33p.
FERRAZ, M. H. C. T.; FUSARI, REZENDE, M. F. (2010) Arte na Educação Escolar. 4ª ed.- São Paulo: Cortez, 51p.
MORAN, J. M. (2007) A educação que desejamos: novos desafios e como chegar lá. Campinas: Papirus.
MORAN, J. M. (2015) Mudando a educação com metodologias ativas. In: Convergências Midiáticas, Educação e Cidadania: aproximações jovens. Coleção Mídias Contemporâneas, 22p.
PRENSKY, M. (2001) Digital Natives, Digital Immigrants. In: PRENSKY, Marc. On The Horizon, MCB University Press, v. 9, n 5. Disponível em: < https://www.marcprensky.com/writing/Prensky%20-%20Digital%20Natives%20Digital%20Immigrants%20-%20Part1.pdf> Acesso em: 29 Nov. 2024.
_______________________________________________
1Professora de Artes (CMB), Especialista em Docência para Educação Profissional e Tecnológica (IFG). Email:
2Termo usado por Marc Prensky, em 2001, para descrever a geração de pessoas que cresceram na era da tecnologia onipresente, incluindo computadores e a Internet. O oposto, os chamados “imigrantes digitais”, refere-se às pessoas que tiveram que se adaptar à nova linguagem da tecnologia. No entanto, recentemente abandonou-as, preferindo a de “homo sapien digital”, numa alusão ao que ele compreende como detentor de uma “sabedoria digital” (digital wisdom), aquele que usa sabiamente as tecnologias contemporâneas para resolver problemas do dia a dia (Prensky, 2001).

O Ensino de Astronomia no Ensino Médio: desafios, estratégias e perspectivas
Luis Sergio Lima Ribas1
RESUMO
Um currículo de Educação Básica deve incluir a Astronomia, pois ela toca nos conceitos de Física, Matemática, História e Cultura de forma equilibrada e integrada. Assim, este trabalho aborda a importância da Astronomia como uma ferramenta pedagógica, as dificuldades associadas à sua implementação, métodos inovadores de ensino da disciplina e a importância da formação contínua dos professores. Além disso, uma das discussões mais importantes é como a Astronomia auxilia na alfabetização científica e nas habilidades de pensamento crítico necessárias para preparar o aluno para um mundo onde o conhecimento científico é cada vez mais valorizado. Como conclusão, não há dúvida de que o ensino dessa disciplina vai além de melhorar o desempenho escolar dos alunos, mas também ajuda a formar cidadãos mais informados e responsáveis.
Palavras-chave: Alfabetização científica. Interdisciplinaridade. Observatório escolar.
ABSTRACT
A basic education curriculum should include astronomy, as it touches on concepts of physics, mathematics, history, and culture in a balanced and integrated manner. Thus, this paper addresses the importance of astronomy as a pedagogical tool, the difficulties associated with its implementation, innovative methods of teaching the subject, and the importance of ongoing teacher training. In addition, one of the most important discussions is how astronomy helps in scientific literacy and critical thinking skills, thus preparing students for a world where scientific knowledge is increasingly valued. In conclusion, there is no doubt that teaching this subject goes beyond improving students' school performance, but also helps to form more informed and responsible citizens.
Keywords: Scientific literacy. Interdisciplinarity. School observatory.
INTRODUÇÃO
A Astronomia, uma das ciências mais antigas e fascinantes da humanidade, tem o poder de despertar a curiosidade e o interesse dos estudantes pelos fenômenos naturais e pelo universo que nos cerca (Langhi & Nardi, 2012). Desde os primórdios da civilização, o céu noturno tem sido uma fonte de inspiração, orientação e reflexão, influenciando mitologias, culturas e o desenvolvimento científico ao longo da história. No contexto educacional, a Astronomia se destaca por sua abordagem interdisciplinar, integrando conceitos de Física, Matemática, Geografia, História e até mesmo Arte, proporcionando uma visão holística e contextualizada do conhecimento (Silva & Barros, 2015). Além disso, seu forte apelo cultural permite que os alunos explorem narrativas, tradições e saberes de diferentes civilizações, enriquecendo o aprendizado e promovendo o respeito à diversidade (Rosa & Perez, 2013).
No entanto, apesar de sua relevância e potencial transformador, o ensino de Astronomia enfrenta desafios significativos. A falta de recursos materiais, como telescópios e materiais didáticos, a formação inadequada dos professores e a necessidade de constante atualização diante dos avanços científicos são obstáculos que dificultam sua implementação efetiva nas escolas. Este artigo busca analisar esses desafios e propor estratégias pedagógicas inovadoras para superá-los, destacando o papel da Astronomia na promoção da alfabetização científica e no desenvolvimento de habilidades essenciais para o século XXI, como o pensamento crítico, a criatividade, além da capacidade de resolver problemas complexos. Ao abordar a relevância do ensino de Astronomia, este trabalho tem como objetivo não apenas destacar seu valor no currículo escolar, mas também motivar educadores, gestores e formuladores de políticas a adotarem práticas que transformem a sala de aula em um ambiente de descoberta e inspiração, onde os alunos possam contemplar as estrelas e, ao mesmo tempo, entender seu lugar no universo.
DESENVOLVIMENTO
A importância do ensino de Astronomia
O ensino de Astronomia desempenha um papel fundamental na formação dos estudantes, oferecendo uma abordagem interdisciplinar que integra conceitos essenciais de Física, Matemática, Química e outras ciências de maneira unificada e contextualizada. Ao explorar fenômenos como o movimento dos planetas, a formação das estrelas ou a expansão do universo, os alunos desenvolvem uma compreensão profunda e interconectada dos princípios científicos que regem o mundo natural (Pompea & Gek, 2002).
Além disso, a Astronomia possui um rico contexto cultural, permitindo que os estudantes conectem o conhecimento científico a mitologias, histórias e tradições de diferentes civilizações, ao longo da história. Essa abordagem vai além do aprendizado de conceitos teóricos; ela promove valores como o respeito, a empatia e a compreensão das diferenças culturais, ao mostrar como diversas sociedades interpretam e se relacionam com o cosmos. Ao estudar, por exemplo, como os povos indígenas observavam o céu para orientar suas práticas agrícolas ou como os gregos antigos desenvolveram os primeiros modelos do sistema solar, os alunos são incentivados a valorizar a diversidade de perspectivas e a reconhecer a ciência como uma construção coletiva e multicultural (Rosa & Perez, 2013).
Dessa forma, o ensino de Astronomia não apenas enriquece o currículo escolar, mas contribui ativamente para a formação de cidadãos mais conscientes, críticos e engajados com o mundo ao seu redor, preparando-os para enfrentar os desafios de uma sociedade globalizada e cada vez mais dependente do conhecimento científico.
Desafios no ensino de Astronomia: recursos e formação docente
Um dos principais desafios para a implementação eficaz do ensino de Astronomia é a falta de recursos materiais e didáticos adequados. Telescópios, modelos planetários, esferas celestes, kits para simulação de fenômenos astronômicos e outros materiais essenciais para observações práticas muitas vezes não estão disponíveis em várias escolas, especialmente em regiões com menor investimento em educação pública (Rosa & Perez, 2013).
Essa falta de recursos limita consideravelmente a capacidade dos educadores de oferecer experiências práticas, que são fundamentais para a compreensão de conceitos abstratos e complexos, como a escala do universo, a dinâmica orbital dos planetas ou os ciclos de vida das estrelas. A falta de infraestrutura adequada também afeta a motivação dos alunos, já que a Astronomia, por ser uma disciplina observacional e exploratória, depende muito de atividades práticas para estimular o interesse e a curiosidade. Sem acesso a equipamentos básicos, como telescópios ou até binóculos, os estudantes perdem a chance de vivenciar fenômenos celestes, como observar crateras lunares, os satélites de Júpiter ou as fases de Vênus, o que poderia tornar o aprendizado uma experiência memorável e significativa (Pompea & Gek, 2002).
Outro desafio importante é a falta de formação adequada dos professores (Langhi & Nardi, 2012). Muitos educadores não têm acesso a um treinamento específico em Astronomia durante sua formação inicial, seja em cursos de licenciatura em Física, Matemática ou Ciências Naturais. Essa deficiência na formação os torna incapazes de tratar o assunto de forma mais profunda e envolvente, frequentemente restringindo-se a conteúdos superficiais ou teóricos, que não se conectam com a realidade e a curiosidade dos alunos.
Além disso, a rápida evolução do conhecimento astronômico, impulsionada por descobertas recentes como exoplanetas, ondas gravitacionais e buracos negros, exige que os conteúdos e as práticas pedagógicas sejam constantemente atualizados. No entanto, muitos professores não têm acesso a programas de formação continuada ou a oportunidades de capacitação que os ajudem a acompanhar essas inovações. A falta de investimento em políticas públicas voltadas para a atualização docente e a escassez de parcerias entre instituições educacionais e centros de pesquisa agravam ainda mais essa situação, perpetuando um ciclo de despreparo e desmotivação.
Esses desafios, quando juntos, criam um ambiente pouco propício para o ensino de Astronomia, dificultando não apenas a transmissão de conhecimentos científicos, mas também a formação de uma geração de estudantes que consiga pensar criticamente sobre o universo e seu lugar nele. Para superar essas barreiras, é fundamental investir na aquisição de recursos didáticos, na formação inicial e continuada de professores e na criação de políticas públicas que reconheçam a Astronomia como um componente essencial do currículo escolar.
Estratégias pedagógicas inovadoras
- Uso de tecnologias educacionais: aplicativos de Astronomia – tipo softwares e jogos do espaço – mostram-se ótimos para entender coisas difíceis, como o tamanho do universo e dos planetas realizando seus movimentos celestes;
- Atividades práticas: explorar o céu noturno, construir modelos espaciais e participar de experiências científicas: assim proporcionamos um caráter exploratório ao aprendizado dos alunos;
- Abordagem interdisciplinar: a integração da Astronomia com outras disciplinas, como Física, Matemática, História e Geografia, promove uma compreensão mais holística e contextualizada dos diversos conteúdos; e
- Contextualização cultural: a inclusão de mitologias, histórias e conhecimentos tradicionais relacionados ao cosmos enriquece o ensino e valoriza a diversidade cultural dos alunos.

Figura 1. Alunos dos clubes de Astronomia e de Estudos Ambientais do Colégio Militar de Brasília realizando observação astronômica no Parque Ecológico das Sucupiras, Plano Piloto, Brasília. Foto: Cel QFE Leonardo Pereira Fraga.
Formação de professores: um pilar para o ensino de Astronomia
A formação dos educadores é crucial para o sucesso do ensino de Astronomia, pois o domínio do conteúdo e a familiaridade com práticas pedagógicas inovadoras são fundamentais para despertar o interesse dos alunos e garantir uma aprendizagem significativa. No entanto, a formação inicial dos professores, especialmente em cursos de licenciatura, muitas vezes ignora a Astronomia, oferecendo pouca ou nenhuma abordagem específica sobre o assunto. Essa lacuna deixa muitos educadores despreparados para ensinar conceitos astronômicos de forma clara, precisa e envolvente, frequentemente resultando em abordagens superficiais ou excessivamente teóricas.
Para superar essa deficiência, é essencial investir em programas de formação continuada que ofereçam aos professores oportunidades de atualização e aprofundamento em Astronomia. Workshops, cursos de extensão e oficinas práticas podem fornecer aos educadores as ferramentas e conhecimentos necessários para abordar temas complexos, como a mecânica celeste, a evolução estelar ou a cosmologia, de maneira acessível e inspiradora. Essas iniciativas devem incluir não apenas a transmissão de conteúdos teóricos, mas também a realização de atividades práticas, como observações do céu, construção de modelos e uso de tecnologias educacionais, que possam ser facilmente replicadas em sala de aula.
Além disso, parcerias com instituições de pesquisa, observatórios astronômicos e universidades podem enriquecer de forma significativa a formação dos professores. Colaborações com astrônomos profissionais e pesquisadores oferecem aos educadores acesso a informações atualizadas sobre descobertas recentes e novas metodologias de ensino. Visitas a planetários, observatórios e museus de ciência, por exemplo, podem proporcionar experiências imersivas que inspiram tanto os educadores quanto seus alunos.
Uma estratégia eficaz é a criação de comunidades de prática, onde os professores podem compartilhar experiências, recursos e metodologias de ensino. Essas redes de colaboração, que podem ser facilitadas por plataformas online ou encontros presenciais, promovem a troca de conhecimentos e o apoio mútuo, fortalecendo a confiança dos educadores e incentivando a adoção de abordagens criativas e interdisciplinares no ensino de Astronomia.
Além disso, é fundamental que as políticas públicas de educação reconheçam a importância da formação continuada em Astronomia e invistam em programas estruturados e acessíveis para todos os professores, independentemente de sua localização geográfica ou contexto socioeconômico. A capacitação docente deve ser encarada não como um custo, mas como um investimento estratégico para o desenvolvimento de uma educação científica de qualidade, capaz de formar cidadãos críticos, curiosos e preparados para os desafios do século XXI.
Em resumo, a formação de professores é essencial para o sucesso do ensino de Astronomia. Ao fornecer aos educadores conhecimentos atualizados, ferramentas pedagógicas inovadoras e oportunidades de colaboração, podemos tornar a Astronomia uma disciplina fascinante e inspiradora, capaz de instigar nos alunos o desejo de explorar o universo e entender seu lugar nele.
Promoção da alfabetização científica através da Astronomia
A Astronomia oferece uma oportunidade única para promover a alfabetização científica, permitindo que os alunos desenvolvam habilidades essenciais para o século XXI, como pensamento crítico, análise de dados e tomada de decisões informadas. Ao explorar temas como a origem do universo, a busca por vida extraterrestre ou os impactos de asteroides, os estudantes são incentivados a questionar, investigar e interpretar informações científicas de forma autônoma e reflexiva. Essa habilidade de avaliar criticamente o conhecimento científico é especialmente importante em uma era caracterizada pela rápida disseminação de informações, que nem sempre são precisas e confiáveis, como as notícias falsas e os mitos pseudocientíficos.
A Astronomia, por ser uma área interdisciplinar e ter um apelo universal, possibilita que os alunos relacionem conceitos científicos complexos a situações do dia a dia e a questões globais, como as mudanças climáticas, a exploração espacial e a preservação do planeta Terra. Por exemplo, ao analisar o efeito estufa em Vênus, os estudantes conseguem entender melhor os desafios ambientais que a Terra enfrenta, cultivando uma consciência crítica sobre a importância da sustentabilidade.
Além disso, a Astronomia desperta a curiosidade e a criatividade, que são essenciais para formar cidadãos engajados e prontos para contribuir com o progresso da sociedade. Ao investigar temas como a formação das galáxias, a evolução das estrelas ou a possibilidade de vida em outros planetas, os alunos são incentivados a pensar de maneira ampla e interconectada, ultrapassando as barreiras das disciplinas e desenvolvendo uma visão mais integrada do conhecimento.
A promoção da alfabetização científica através da Astronomia também prepara os estudantes para enfrentar os desafios de um mundo cada vez mais voltado para a ciência e a tecnologia. Ao aprender a analisar dados, interpretar gráficos e avaliar evidências, eles ganham ferramentas para tomar decisões informadas em várias áreas, desde saúde e meio ambiente até política e economia. Essa habilidade é fundamental para o exercício da cidadania em uma sociedade democrática, onde a capacidade de distinguir entre fatos e opiniões é vital para uma participação ativa e responsável.
Em resumo, a Astronomia não só enriquece o currículo escolar, mas é fundamental na formação de indivíduos críticos, curiosos e conscientes de seu papel no mundo. Ao incentivar a alfabetização científica, ela ajuda a construir uma sociedade mais informada, engajada e pronta para enfrentar os desafios do futuro. Portanto, investir no ensino de Astronomia é investir no desenvolvimento de mentes capazes de explorar o universo e, ao mesmo tempo, cuidar e valorizar o planeta que habitamos.
CONSIDERAÇÕES FINAIS
O ensino de Astronomia no ensino médio vai muito além de ser apenas uma disciplina curricular; é uma verdadeira jornada pelo conhecimento que pode despertar a curiosidade, a criatividade e o espírito explorador dos jovens. Ao preparar os alunos para entender os mistérios do universo, estamos formando não apenas futuros cientistas e astrônomos, mas também cidadãos críticos e conscientes, prontos para enfrentar um mundo cada vez mais complexo e interconectado.
O ensino de Astronomia no ensino médio vai muito além de ser apenas uma disciplina curricular; é uma verdadeira jornada pelo conhecimento que pode despertar a curiosidade, a criatividade e o espírito explorador dos jovens. Ao preparar os alunos para entender os mistérios do universo, estamos formando não apenas futuros cientistas e astrônomos, mas também cidadãos críticos e conscientes, prontos para enfrentar um mundo cada vez mais complexo e interconectado.
Investir no ensino de Astronomia vai além de simplesmente "colocar estrelas no teto" ou oferecer uma visão romântica do cosmos. É sobre cultivar mentes curiosas, capazes de questionar, analisar e imaginar um futuro onde ciência e tecnologia caminham lado a lado com a humanidade. Ao mesmo tempo, a Astronomia nos lembra da fragilidade e da singularidade do nosso planeta, despertando uma consciência global sobre a importância de proteger a Terra, nossa "nave-mãe" preciosa, diante dos desafios ambientais e sociais que enfrentamos.
No fim das contas, o ensino de Astronomia é um convite para que os jovens explorem não apenas o universo ao seu redor, mas ainda o potencial infinito que existe dentro deles. Ao investir nessa área, estamos plantando as sementes de um futuro onde o conhecimento científico se torna a bússola que orienta a humanidade, em direção a novas fronteiras tanto no espaço quanto na Terra.
REFERÊNCIAS
Carvalho, A. M. P.; Gil-Pérez, D. (2011) Formação de Professores de Ciências: Tendências e Inovações. Cortez Editora.
Langhi, R.; Nardi, R. (2012) Ensino de Astronomia: Erros Conceituais Mais Comuns entre Professores e Livros Didáticos. Revista Brasileira de Ensino de Física, v. 34, n. 1, p. 1-10.
Silva, J. A.; Barros, M. A. (2015) A Importância da Astronomia no Ensino Médio: Uma Abordagem Interdisciplinar. Ciência & Educação, v. 21, n. 3, p. 643-658.
Pompea, S. M.; Gek, T. K. (2002) Teaching Astronomy with Interactive Visualization Tools. Astronomy Education Review, v. 1, n. 1, p. 1-12.
Rosa, C. W.; Perez, C. A. S. (2013) Astronomia na Escola: Propostas para o Ensino Fundamental e Médio. Editora UFSC.
_______________________________________________
1Professor de Física (CMB), Orientador do Clube de Astronomia. Email:

Uso de telas e seus efeitos nas relações, no cérebro e na escola: um breve auxílio ao despertar
Caroline Demo1; Leonardo Pereira Fraga2
RESUMO
Vivemos em plena era digital. Estamos nos adaptando ao uso de telas e essas tecnologias digitais têm deixado marcas em toda a sociedade. Na população infantojuvenil o uso demasiado de telas reflete em comprometimento cognitivo e problemas de saúde física e mental, com declínio da atenção às aulas e do aprendizado. No ambiente domiciliar cresce a necessidade de regulação emocional e de cuidados parentais para evitar a dependência digital de crianças e adolescentes. Os objetivos deste trabalho foram problematizar o desenvolvimento infantojuvenil e discutir o papel da escola nessa nova era digital. Foi investigado o frequente uso de dispositivos eletrônicos em sala de aula, por alunos do 1º ano do Ensino Médio, no Colégio Militar de Brasília. Pesquisas recentes apontam que a restrição e o uso controlado dos dispositivos eletrônicos no ambiente escolar devem estar entre os objetivos de todas as escolas.
Palavras-chave: Escola. Uso de telas. Cérebro. Danos. Uso racional.
ABSTRACT
We live in a digital age. We are adapting to the use of digital screens and these technologies have left their mark on society as a whole. In children and adolescents, excessive use of screens results in cognitive impairment and physical and mental health problems, with a decline in attention to lessons and learning. In the home environment, there is a growing need for emotional regulation and parental care to prevent children and adolescents from becoming digitally dependent. The objectives of this study were to problematize child and adolescent development and discuss the role of schools in this new digital age. We investigated the frequent use of electronic devices in the classroom by 1st year high school students at the Military School of Brasília. Recent research indicates that restricting and controlling the use of electronic devices in the school environment should be among the objectives of all schools.
Keywords: School. Use of screens. Brain. Harm. Rational use.
INTRODUÇÃO
Agenda digital, anotações no celular, pesquisas rápidas e acessíveis, jogos gratuitos, tela infinita, redes sociais: é desta forma que os algoritmos vão traçando a vida cotidiana da maior parte das pessoas, em suas conexões digitais. A tecnologia veio para ficar e cada vez mais está disponível com valores acessíveis a toda a população. Cada vez mais cedo, as crianças estão recebendo o acesso à tecnologia permitido pelos adultos cuidadores.
A infância de gerações anteriores era permeada pela natureza, pelas vivências ao ar livre, pelas brincadeiras de rua, até chegar a hora de arrumar-se para ir para a escola. Era o contato saudável e estimulante dos cérebros em desenvolvimento com tantas experiências que as brincadeiras infantis proporcionavam. Entretanto, grandes mudanças ocorreram na sociedade como um todo: a violência aumentou, as famílias optaram por menor quantidade de filhos, os pais mais ativos profissionalmente diminuem os contatos com a natureza, os pais estão menos disponíveis, os amigos da rua, aos poucos, substituídos pelas tecnologias digitais.
A juventude com seu celular na mão, em casa e nas escolas, faz com que o cérebro atue por meio de estímulos diferentes e a plasticidade cerebral tão propagada nas crianças vai sendo diferentemente formada. O que antes era estimulado pela natureza e pelas vivências ao ar livre, refletindo em leveza e tranquilidade, está sendo substituído pelas recompensas hormonais do imediatismo, por comportamentos cada vez mais influenciados pelos algoritmos.
Recentemente, o professor e pesquisador Rafael Polakiewicz relatou significativo aumento dos casos de ansiedade infantil ocasionados por estímulos frequentes do sistema de recompensas do cérebro (Polakiewicz, 2022). Nobre e colaboradores (2021), apoiados em dados da American Academy of Pediatrics, relataram que “viver em um ambiente multitela, por exemplo, televisão, tablet, computadores, smartphones, pode incentivar o uso de telas precocemente na primeira infância”. A Unesco, em boletim recentemente divulgado, evidenciou as preocupações sobre o uso excessivo dos celulares no ambiente escolar e apontou possíveis ações de enfrentamento do problema (Unesco, 2023). O boletim corroborou estudos médicos sobre danos à saúde mental e física de crianças e adolescentes causados pelo uso excessivo de telas conduzidos por Rosa & Souza (2021). É chegada a hora do poder público e da sociedade atuar?
Este artigo é um convite à reflexão, um estímulo ao pensamento. Devemos considerar dois pontos relevantes: se, por um lado, os dispositivos eletrônicos representam um importante recurso lúdico e interdisciplinar no desenvolvimento da criança e do adolescente, por outro lado, trazem preocupações pelo uso excessivo, o que as pesquisas científicas chamam de ciberdependência. Oliveira (2017) afirma que a maturidade do sistema neuronal para tomadas de decisão, sem pensar somente nas recompensas imediatas (como em funcionamento nas redes sociais), ocorre somente na vida adulta. Essa constatação reforça o papel dos pais e cuidadores na formação socioemocional dos filhos.
Dentre os possíveis aspectos do uso de telas, apresento uma problematização focada no desenvolvimento de crianças e adolescentes, além de reflexões quanto ao necessário enfrentamento da dependência digital de alunos no ambiente escolar.
DESENVOLVIMENTO
O cérebro infantojuvenil, as telas e as tomadas de decisão
Segundo Lima (2020), estudos crescentes permitem compreender que o cérebro não interrompe seu desenvolvimento e que a formação de circuitos neurais e sinapses ocorrem por meio de estímulos do ambiente. Oliveira (2017) destacou, nesse sentido, a epigenética inter-relação entre genes e experiência – mencionando sobre os estímulos ambientais como um importante fator da expressão de alguns genes. A autora afirma que “bebês/crianças que passaram por situações de estresse intenso, abuso ou negligência (física, sexual e/ou emocional) podem desenvolver alterações epigenéticas”, ou seja, em seu desenvolvimento cerebral. Essas experiências geram adaptações boas ou ruins e podem resultar em sistemas neurais disfuncionais (Oliveira, 2017). Ferrari et al. (2001) e Guerra (2011) afirmam que a interação organismo-ambiente também diferencia e molda os circuitos neurais, os quais caracterizam a plasticidade e a individualidade neural do organismo.
Miranda & Silva (2012) descrevem as partes do nosso cérebro e suas atuações no sistema nervoso central adentrando na significação das emoções e dos acontecimentos ocorridos na vida de uma pessoa. Tendo seu início de desenvolvimento, ainda como bebês, formamos nosso caráter e nossas formas de expressar as emoções, por meio dos aprendizados contínuos. A região do cérebro que inicia esse processo é a amígdala cerebral, uma das mais importantes do sistema límbico, que tem sido apontada como fundamental na neurobiologia da emoção e da afetividade, uma vez que é responsável por atribuir significados às emoções e às decisões que vamos tomar na vida adulta (Miranda & Silva, 2012).
Ainda sobre o desenvolvimento cerebral e as tomadas de decisão, Oliveira (2017) dá ênfase à formação do sistema límbico de recompensa na infância. Segundo a autora, esse grupo de estruturas neurais, responsáveis pela aprendizagem associativa e pela validação positiva das emoções, particularmente as que possuem o prazer como seu componente central, é desenvolvido até a vida adulta. Essas estruturas neurais necessitam de corregulação dos familiares e cuidadores, para que o cérebro infantil se desenvolva adequadamente para as tomadas de decisão (Oliveira, 2017).
Mas, nesses casos, o que significa o termo corregulação? Para Cunha e colaboradores (2022) significa práticas parentais positivas relacionadas aos cuidados dos cuidadores. Trata-se de auxílio parental que propicie a capacidade de modular reações emocionais usando a moderação, inibição, intensificação ou manutenção das emoções (Cunha et al., 2022). Loevaas e colaboradores (2018) relatam que a regulação emocional é um fator de destaque no desenvolvimento das capacidades de tomadas de decisão desenvolvidas especialmente entre os 8 a 12 anos. Para os autores, essas capacidades somente são desenvolvidas de forma adequada e com pertencimento se existir intensa participação familiar, não extinguindo o meio social, mas este se apresentando menos controlável (Loevaas et al., 2018).
Então, possibilitar a plena capacidade de decisão, por meio do uso de telas, para um ser em desenvolvimento é algo prudente? Em entrevista recente para a National Geographic, a especialista Amber Howard argumentou que a adolescência é um momento regado a alterações físicas, emocionais e sociais e que este grupo é mais propenso a focar no lado positivo dos riscos (como a aceitação social) do que no lado negativo (como as consequências para a saúde). Assim, os adolescentes dão prioridade ao grupo social e têm dificuldades para compreender consequências de longo prazo (fator que torna os vídeos e shorts muito populares nas redes sociais). Esses conteúdos digitais incentivam comportamentos de risco e de imitação sem apresentar possíveis consequências.
Atualmente, inúmeros autores apresentam os impactos negativos do uso exagerado dos dispositivos eletrônicos, discutindo os efeitos da exposição prolongada às telas em aspectos como atenção, memória, sono, comportamento e desenvolvimento cognitivo. Alguns desses estudos enfatizam que os impactos negativos em crianças e adolescentes podem ser minimizados com o uso equilibrado, consciente e supervisionado de telas (Alves et al., 2009; Anderson & Subrahmanyam, 2017; Desmurget, 2019; Nobre et al. 2021; Monteiro et al., 2021). No Brasil, uma investigação recente realizada pelo Comitê Gestor da Internet revelou que 85% das crianças e adolescentes, com idades entre 9 e 17 anos, fazem uso diário da internet e permanecem online uma média de 3 horas por dia (Brasil, 2020). Monteiro et al. (2021) ressaltaram as consequências decorrentes da utilização excessiva de telas, durante a pandemia de COVID-19, e enfatizaram a necessidade de estabelecer limites bem definidos para os usos domiciliares.
O cérebro também necessita de descanso dessa hiperestimulação que as tecnologias digitais imprimem. O Instituto de Ciências Médicas Gerais dos Estados Unidos relatou que a luz dos dispositivos, durante a noite, pode confundir os relógios biológicos e acarretar distúrbios do sono, obesidade, diabetes e depressão (National Geographic, 2023). Rosa & Sousa (2021) discutem o desafio de crianças e adolescentes, diante da imaturidade de seus cérebros, no processo de tomada de decisão, que pode resultar em conflito entre o córtex pré-frontal (função executiva que avalia) e o sistema límbico (que sinaliza a sensação de prazer). Em cérebros cansados e viciados, a dependência relacionada à dificuldade de resistir aos impulsos de recompensa imediata se intensifica, a despeito de quaisquer consequências negativas.
Entendendo o ciclo de prazer nas telas
Bruna Garrossino, em seu curso “Filhos e telas: equilíbrio e respeito na Era Digital”, detalha o porquê das telas funcionarem como mecanismos viciantes e os fatores causados no cérebro para manter seus usuários ativos. Durante o uso de dispositivos eletrônicos, os impulsos neuroquímicos do cérebro são ativados. Ao rolarmos o dedo rapidamente, somos estimulados pela sucessão de vídeos e com imagens, as quais promovem circuitos de recompensa e sensações de prazer intimamente ligadas à dopamina (Rolnik & Sholl-Franco 2006; Garrosino, 2023). A dopamina é uma substância neuro-hormonal relacionada também com a motivação, o aprendizado e o humor. Os autores relatam que tendemos a sempre buscar mais sensações prazerosas, na relação com os dispositivos eletrônicos. O sistema límbico (sistema das emoções), assim como outras estruturas do cérebro (amígdala e o córtex pré-frontal), tendem a manter a mente ativada, em busca de mais dopamina (e em consequência mais prazer), num ciclo desenfreado de sensações hormonais viciantes (ver Figura 1).

Figura 1: Esquema do ciclo do prazer na utilização de telas relacionado à produção de neuroquímicos cerebrais ligados ao prazer e à dependência. Fonte: Bruna Garrossino – “Filhos e telas: equilíbrio e respeito na Era Digital” (curso online - 2023).
Cardial (2023) esclarece uma relação entre o uso abusivo de telas e a ansiedade, causada pelo aumento do cortisol (hormônio do estresse) que repercute e impacta a convivência social.
|
O uso excessivo das telas, seja num jogo, numa conversa, assistindo a vídeos ou navegando pelas redes sociais, causa sensação de bem-estar e prazer, por isso cria dependência. Deixa-se de conviver no coletivo, de ter interlocução e isola-se porque é mais prazeroso viver a experiência das telas (Cardial, 2023). |
Nesse sentido, Rosa & de Souza (2021) citam que o avanço das tecnologias está gerando crianças imersas na cibercultura e que a busca por prazeres imediatos está moldando a chamada “geração Z” (pessoas nascidas entre a segunda metade da década de 1990 até o início dos anos 2010), com base na extrema dependência digital. As formas de aprendizado dessa geração ocorrem dentro da perspectiva prática e, assim, descobrem e aprendem de forma rápida. Este é o motivo pelo qual os ambientes educacionais de tecnologias digitais estão profundamente interligados aos ciberespaços. Deixando claro que as tecnologias digitais podem proporcionar inúmeros benefícios quando mediadas de forma controlada e segura.
Uso excessivo da tecnologia e suas consequências na escola e na vida
A escola, que compreende muitas horas diárias na fase infantojuvenil, está sofrendo as consequências da utilização desregrada das tecnologias digitais e de suas facilidades. A Unesco sugere uma correlação negativa entre o uso excessivo das tecnologias digitais e o desempenho escolar:
Descobriu-se que a simples proximidade de um aparelho celular era capaz de distrair os estudantes e provocar um impacto negativo na aprendizagem em 14 países. O tempo prolongado de exposição à tela pode afetar de forma negativa o autocontrole e a estabilidade emocional, aumentando a ansiedade e a depressão (Unesco, 2023)
Cardial (2023) revela que 22,3 milhões de crianças e adolescentes, com idades entre nove e 17 anos, são usuários da internet no Brasil. Além dos problemas já apresentados, a superexposição aos eletrônicos pode causar déficit de atenção, aumento da impulsividade, tendência ao isolamento, depressão e agressividade (Cardial, 2023).
Abreu e colaboradores (2008) avaliam que, à medida que esses internautas se refugiam progressivamente no mundo virtual (e se aliviam das experiências concretas da vida) começam a exibir características cada vez mais intensas e peculiares. Esses internautas podem apresentar uma nova classificação psiquiátrica, a denominada “dependência de internet”, com sérias consequências e necessidade de tratamentos específicos visando ao resgate da vida real (Abreu et al., 2008).
Parte Experimental
Buscando avaliar a problemática da dependência digital dos alunos, no ambiente escolar do Colégio Militar de Brasília, realizei uma consulta aos registros de questões comportamentais de alunos, envolvendo a utilização indevida de aparelhos celulares e tablets, durante as aulas. Nesse levantamento de dados, utilizei o período de fevereiro a novembro de 2023 e o universo amostral de alunos do 1º ano do Ensino Médio.
Para quantificar os registros, computei as anotações de professores relatando alunos portando ou utilizando os dispositivos eletrônicos como recreação, durante as aulas, sem autorização do docente responsável.
RESULTADOS
No período pesquisado foram registrados aproximadamente 91 Fatos Observados (anotações realizadas pelos professores que indicam um comportamento/ação do aluno) relacionados ao uso sem autorização de dispositivos eletrônicos em sala de aula.
É possível inferir a subnotificação desses registros pela frequente opção dos professores em advertir verbalmente os alunos (visando não prejudicar a exposição da matéria), encontrados imersos na tela do celular na sala de aula.
DISCUSSÃO
Fazendo referência ao autocontrole, na obra “A fábrica de cretinos digitais: os perigos das telas para nossas crianças”, o autor afirma que o diálogo e o estabelecimento de regras restritivas clara, de forma consciente, reduzem o uso dos dispositivos digitais (Desmurget, 2021). Garrossino (2023) afirma que saem as telas e entram os adultos cuidadores para conversar e relembrar sobre a necessidade de diminuição do uso ou dos excessos momentâneos. A presença do adulto nas decisões deve existir, como forma de corregulação, algo que as crianças e os adolescentes necessitam para o amadurecimento cerebral saudável. Desmurget (2021) orienta uma reorganização familiar para que o suposto vazio digital possa ser preenchido por conversas, troca de ideias, práticas de esportes, sono adequado, canto e leitura. Não tem problema que sejam quadrinhos, ou as inúmeras leituras que o ócio pode proporcionar, devolvendo a criatividade diminuída pelas facilidades das tecnologias digitais.
Permeando a corregulação podemos realizar inferências à realidade de sala de aula, na disputa extenuante pela atenção dos alunos. Se os alunos estão utilizando os aparelhos celulares de forma excessiva, devemos nós, adultos, apresentar propostas de mudanças. Segundo Oliveira et al. (2016), citando um estudo de meta-análise visando verificar os efeitos de programas de intervenção na mudança do comportamento sedentário, sugerem que, além de reduzir o tempo de uso de TV, computadores e videogames, deve-se focar em ações no âmbito escolar. No ambiente escolar é necessário estímulo e promoção de ações de atividades físicas, de educação alimentar e nutricional, as quais estão entre as possíveis políticas públicas. A Unesco recomenda a implementação de leis que regulem o uso de dispositivos eletrônicos em sala de aula. Atualmente, os smartphones foram banidos total ou parcialmente no México, Portugal, Espanha, Itália, Suíça, Estados Unidos, Letônia, Escócia e em províncias do Canadá. Na França, apesar da proibição, os aparelhos podem ser usados por certos grupos de alunos com necessidades educacionais especiais ou para fins comprovadamente pedagógicos.
No Brasil, são poucos os dados em relação ao assunto, mas já observamos algumas iniciativas nas esferas federal e estadual. Em 2023, estava aberta uma consulta pública federal sobre o uso consciente de telas (Brasil, 2023). Em Minas Gerais, desde 2019, um projeto de lei prevê a proibição dos dispositivos eletrônicos no ambiente escolar (Minas Gerais, 2019). Recentemente, no Distrito Federal, o Colégio Marista João Paulo II implementou restrições para alunos dos 6º e 7º anos. Já a Prefeitura do Rio de Janeiro publicou decreto proibindo o uso de celulares e outros dispositivos eletrônicos nas escolas (Rio de Janeiro, 2024).
CONSIDERAÇÕES FINAIS
E será que conseguimos apresentar soluções? A maioria dos autores citados trazem pensamentos e sugestões de atitudes racionais de utilização racional de telas. Os estudos, em geral, não advogam a proibição completa, mas uma efetiva educação digital baseada nas realidades familiar e escolar. Um ponto interessante é o chamado “Minimalismo Digital”, nomeado em vários estudos como forma de melhorar a qualidade de vida, utilizando nosso tempo em atividades mais proveitosas (Martins, 2021; Bonilla & Solís, 2022; e-Cicle, 2023).
Como conclusão geral, as pesquisas indicam que a participação da escola com medidas restritivas e, principalmente, o incentivo da família, a dedicar mais tempo na vida das crianças e adolescentes, vão possibilitar o retorno das rotinas de convivência familiar. Cardial (2023) ressalta que recuperar a conexão com a vida real é muito difícil e demanda muito dos participantes do processo. Afirma, ainda, que a escola é responsável por zelar pela integridade dos estudantes, enquanto estiverem em suas dependências, incluindo, nesse sentido, a fiscalização quanto à utilização excessiva das tecnologias digitais.
REFERÊNCIAS
ABREU, C. N.; KARAM, R. G.; GOES, D. S.; SPRITZER, D. T. (2008) Dependência de Internet e de Jogos Eletrônicos: uma revisão. Revista Brasileira de Psiquiatria, v. 30, n. 2, p. 156-67.
ALVES L.; CARVALHO, A. M.; SILVEIRA, J. C. C.; BELIZÁRIO FILHO, J. F.; FORTINI, M. S.; COSTA, D. S. F. et al. (2019) Videogame: suas implicações para aprendizagem, atenção e saúde de crianças e adolescentes. Revista Médica de Minas Gerais, v. 19, n. 1, p. 19-25.
ANDERSON, D. R.; SUBRAHMANYAM, K. (2017) Digital screen media and cognitive development. Pediatrics, 140 (Supplement 2), S57–S61.
BONILLA, E.; SOLÍS, V. S. (2022) Minimalismo digital: estrategias para mejorar la productividad y bienestar docente durante y después de la pandemia. Voces de la educación, v. 7, n. 13, p. 80-96.
BRASIL (2023) Secretaria de Comunicação Social da Presidência da República. Disponível em: <https://www.gov.br/secom/pt-br/assuntos/noticias/2023/10/lancamento-de-consulta-publica-sobre-uso-consciente-de-telas-e-dispositivos-digitais-por-criancas-e-adolescentes> Acesso em: 25 nov. 2023.
CARDIAL, K. (2023) Conectados às telas e desconexos de si. Revista Educação (digital), v. 296. Disponível em: <https://revistaeducacao.com.br/2023/08/24/conectados-excesso-de-telas/> Acesso em: 27 out. 2023.
CUNHA, A. C. B; MAFFAZIOLLI, A. N.; ALBUQUERQUE, K. A. (2022) Relações entre regulação emocional parental e desenvolvimento dos filhos. Revista Saúde e Desenvolvimento Humano, v. 10, n. 3, p. 1-14.
DESMURGET, M. (2021) A fábrica de cretinos digitais. São Paulo: Vestígio.
e-CICLE (2023) Minimalismo Digital. Disponível em: <https://www.ecycle.com.br/minimalismo-digital/> Acesso em: 25 ago. 2023.
FERRARI, E. A.; TOYODA, M. S. S.; FALEIROS, L.; CERUTTI, S. M. (2001) Plasticidade Neural: relações com o comportamento e abordagens experimentais. Psicologia: teoria e pesquisa, v. 17 n. 2, p. 187-194.
GARROSINO, B. (2023) Filhos e telas: equilíbrio e respeito na Era Digital. Curso online. Disponível em: < https://hotmart.com/pt-br/marketplace/produtos/filhos-e-telas-equilibrio-e-respeito-na-era-digital/> Acesso em: 2 out. 2023.
GUERRA, L. B. (2011) O diálogo entre a neurociência e a educação: da euforia aos desafios e possibilidades. Revista Interlocução, v. 4, p. 3-12.
LIMA, M. C. G. S. (2020) Plasticidade Neural, Neurociência e Educação: As bases do Aprendizado. Arquivos do Mudi, v. 24, n. 2, p. 30-41.
LOEVAAS, M.; SUND, A. M.; PATRAS, J.; MARTINSEN, K.; HJEMDAL, O.; NEUMER, S. P., et. al. (2018) Emotion regulation and its relation to symptoms of anxiety and depression in children aged 8-12 years: does parental gender play a differentiating role? BMC Psychology, v. 6, n. 1, p. 42.
MARTINS, Y. A. (2021) Adoção do minimalismo digital por profissionais de comunicação: alternativas para minimizar os impactos na saúde mental. Trabalho de Conclusão de Curso (Graduação em Comunicação Social/Publicidade e Propaganda) - Universidade Federal do Ceará. Fortaleza, 50f.
MINAS GERAIS (2019) Assembleia Legislativa de Minas Gerais. Projeto de Lei nº 1.136/2019. Disponível em: <https://www.almg.gov.br/atividade-parlamentar/projetos-de-lei/texto/?tipo=PL&num=1136&ano=2019> Acesso em: 27 nov. 23.
MIRANDA, G. V. & SILVA, L. K. (2012) O papel das experiências precoces na modulação da expressão emocional e desenvolvimento do caráter. Revista Brasileira de Desenvolvimento Infantil, v. 10, n. 2, p. 45-58.
MONTEIRO, R.; ROCHA, N. B.; FERNANDES, S. (2021) Are Emotional and behavioral problems of infants and children aged younger than 7 years Related to screen time exposure during the Coronavirus Disease 2019 confinement? An exploratory study in Portugal. Frontiers in Psychology, v. 12, 590279
NATIONAL GEOGRAPHIC (2023) Como o uso de telas afeta o cérebro. Disponível em: <https://www.nationalgeographicbrasil.com/ciencia/2023/02/como-o-uso-excessivo-das-telas-afeta-o-cerebro> Acesso em: 25 ago. 2023.
NOBRE, J. N. P.; SANTOS, J. N.; SANTOS, L. R.; GUEDES, S. D. C.; PEREIRA, L.; COSTA, J. M.; MORAIS, R. L. D. S. (2021) Fatores determinantes no tempo de tela de crianças na primeira infância. Ciência & Saúde Coletiva, v. 26, p. 1127-1136.
OLIVEIRA, J. S.; BARUFALDI, L. A.; ABREU, G. D. A.; LEAL, V. S.; BRUNKEN, G. S.; VASCONCELOS, S. M. L.; ... BLOCH, K. V. (2016) ERICA: use of screens and consumption of meals and snacks by Brazilian adolescents. Revista de Saúde Pública, v. 50, p. 7s.
OLIVEIRA, M. P. M. T. (2017) Prevenção começa em casa: contribuição da neurociência. Revista da Sociedade Brasileira de Psicologia Analítica, v. 35, p. 21-31.
POLAKIEWICZ, R. (2022) O adoecimento psíquico de crianças por uso de telas. Disponível em: <https://pebmed.com.br/o-adoecimento-psiquico-de-criancas-por-uso-de-telas> Acesso em: 25 ago. 2023.
RIO DE JANEIRO (2024) Secretaria Municipal de Educação da Prefeitura do Rio de Janeiro. Proibição do uso de celulares e outros dispositivos eletrônicos nas escolas. Disponível em: <https://educacao.prefeitura.rio/celulares/> Acesso em: 27 nov. 2024.
ROLNIK, A. L.; SHOLL-FRANCO, A. (2006). As profundezas do vício: “Quando eu quiser, eu paro! ”. Ciências & Cognição, v. 9.
ROSA, P. M. F.; SOUZA, C. H. M. (2021) Ciberdependência e infância: as influências das tecnologias digitais no desenvolvimento da criança. Brazilian Journal of Development, v. 7, n. 3, p. 23311-23321.
UNESCO - Organização das Nações Unidas para a Educação, Ciência e Cultura (2023) Unesco faz alerta sobre utilização do celular em sala de aula. Disponível em: <https://unesdoc.unesco.org/ark:/48223/pf0000386147> Acesso em: 28 jul. 2023.
_______________________________________________
1Professora de Biologia (CMB), Doutora em Biologia Animal (UnB). Email:
2Professor de Biologia (CMB), Mestre em Ecologia (UnB), Especialista em Sociobiodiversidade (UnB).

Desenvolvimento da capacidade de concentração de estudantes do Ensino Médio, a partir do ensino da Sociologia: uma experiência didática
Bruner Titonelli Nunes 1 , Paulo Victor Rodrigues Mascarenhas 2
RESUMO
Este artigo analisa uma experiência didática desenvolvida no Colégio Militar de Brasília (2022-2023) que estimulou a capacidade de concentração dos estudantes do Ensino Médio, nas aulas de Sociologia. Diante das dificuldades de aprendizagem, agravadas pelo uso excessivo de tecnologias digitais - que privilegiam a contextualização multimídia em detrimento do pensamento linear -, implementou-se uma estratégia de anotações ativas com reforço positivo (pontos bônus) para registros do conteúdo exposto. Os resultados mostraram maior engajamento dos alunos, com melhora na compreensão dos conteúdos e na internalização de conceitos sociológicos. Além disso, observou-se que a prática de anotações favoreceu a interação aluno-professor. Como estratégia de motivação, destacou-se a aplicabilidade dos conhecimentos sociológicos para além da disciplina, ilustrada pelo caso de um aluno que obteve nota máxima em repertório na redação do ENEM 2022. Os resultados indicam que a metodologia não apenas melhorou o desempenho em Sociologia, mas também desenvolveu habilidades transversais (concentração e organização do pensamento), contribuindo para a formação integral e sucesso em processos seletivos. A experiência sugere a viabilidade de estratégias pedagógicas que combinem exigência progressiva e incentivos concretos para o desenvolvimento cognitivo, num contexto marcado por distrações digitais.
Palavras-chave: Ensino da Sociologia. Concentração. Anotações ativas. Pensamento linear.
RESUMO
Este artigo examina uma experiência de ensino conduzida no Colégio Militar de Brasília (2022-2023) que incentivou a capacidade de concentração de alunos do Ensino Médio nas aulas de sociologia. Diante das dificuldades de aprendizagem agravadas pelo uso excessivo de tecnologias digitais — que priorizam a contextualização multimídia em detrimento do pensamento linear —, implementou-se uma estratégia de anotações ativas com reforço positivo (pontos bônus) para registrar o conteúdo apresentado em sala de aula. Os resultados demonstraram aumento do engajamento dos alunos, com melhor compreensão do conteúdo e melhor internalização de conceitos sociológicos. Além disso, a prática de anotações potencializou a interação aluno-professor. Como estratégia motivacional, o estudo destacou a aplicabilidade do conhecimento sociológico para além da disciplina, exemplificada por um aluno que obteve nota máxima no critério "repertório" da redação do ENEM de 2022. Os resultados indicam que a metodologia não apenas melhorou o desempenho em sociologia, mas também desenvolveu habilidades transversais (concentração e organização do pensamento), contribuindo para a formação integral e o sucesso em processos seletivos. A experiência sugere a viabilidade de estratégias pedagógicas que combinem demandas progressivas e incentivos concretos para o desenvolvimento cognitivo em contextos de distração digital.
Palavras-chave: Ensino de sociologia. Habilidades de concentração. Anotações ativas. Pensamento linear.
INTRODUÇÃO
A disseminação do uso do ciberespaço, de forma tão íntima, reordenou e aumentou o modo como o virtual foi incorporado ao nosso cotidiano. A pandemia de COVID-19 trouxe enormes impactos para a humanidade e apressou mudanças que já estavam em curso na sociedade. Pierre Levy (2010) levantou uma série de questões sobre as potencialidades do ciberespaço. O autor nos lembra que a noção do virtual já existia como conceito. Por outro lado, a disseminação do uso do ciberespaço, de forma intimamente conectada à vida humana, acelerou o universo de possibilidades que a vida virtual pode proporcionar (Pierre Levy, 2010).
A partir dessas potencialidades já em uso pela humanidade, é possível refletirmos sobre as inevitáveis mudanças cognitivas do processo. Da mesma forma que a alfabetização representa um processo de mudança cognitiva, em relação às pessoas não letradas (ONG, 1998), ao introjetar a internet e as redes sociais no cotidiano, a humanidade passou a desenvolver habilidades de contextualização multimídia. A escrita proporciona uma forma de organização do pensamento linear (como aquela que usamos na leitura de um livro). Quando se lê um livro estamos utilizando uma concentração unidirecional. Isso é muito diferente de olharmos no celular e, ao mesmo tempo, realizarmos multitarefas (ver um vídeo no “YouTube”, conversar com alguém presencialmente na mesma sala). Nesse último caso, temos o exercício da cognição fragmentada.
Uma conversa entre usuários de uma rede social, em que um usuário escreve um “textão” e o outro responde como um “meme”, é um exemplo de debate, a partir de lógicas de pensamento diferentes. O texto apresenta uma lógica linear do pensamento, onde frases se sucedem na construção de uma ideia. Já o “meme” representa uma interação entre uma imagem e um pequeno texto de contextualização. A imagem abre espaço para a transmissão de sensações e ideias que tendem a ampliar as possibilidades interpretativas. Nesse contexto, é esperado uma certa dificuldade no encadeamento de ideias apresentadas, a partir da lógica de pensamento linear.
Estamos tratando de capacidades de contextualização de ideias diferentes, as quais acessam capacidades cognitivas diferentes. O fato da atual geração de estudantes, na maior parte do tempo, exercitar contextualizações nas formas de imagens e de pequenos textos - a partir do uso das tecnologias digitais - torna imprescindível uma escola que regate as habilidades de concentração e de pensamento linear. Essa necessidade parte da constatação que vivemos um momento histórico de profundas mudanças nas relações entre indivíduos, mundo sensível e mundo digital.
O objetivo deste artigo é descrever uma experiência didática ocorrida nos anos de 2022 e 2023, na disciplina de Sociologia no Colégio Militar de Brasília (CMB). O ponto de partida dessa experiência didática foi a percepção de que o incremento da capacidade de concentração dos alunos teria o potencial de melhorar a absorção dos conteúdos de Sociologia3. Ainda, com uma expectativa mais ampla especulou-se que o desenvolvimento dessa habilidade poderia trazer impactos positivos na totalidade da formação escolar dos alunos.
DESENVOLVIMENTO
Apresentação do trabalho
A partir da constatação da dificuldade de um conjunto significativo de alunos em acompanhar adequadamente o conteúdo ministrado, o professor elaborou e aplicou uma experiência didática com o objetivo de incentivar o desenvolvimento de habilidades de concentração e de pensamento linear.
O presente trabalho desenvolve sua argumentação em quatro eixos principais: 1) identifica os desafios da concentração na era digital, contrastando o pensamento linear com a cognição fragmentada das mídias sociais; 2) detalha a metodologia aplicada, com um sistema progressivo de anotações ativas e de reforços positivos que evolui de registros simples da escrita para registros elaborados dos conteúdos orais; 3) além da preocupação metodológica, demonstra também preocupação com o engajamento dos alunos demonstrando sua utilização concreta em provas de concurso. Assim, uma redação do ENEM escrita por um aluno do CMB é apresentada como constatação da eficácia do método; 4) finalmente, o texto relaciona as teorias de Weber, Bourdieu e Freud, as quais fundamentam a abordagem pedagógica, com reflexões dos resultados observados, após um ciclo completo dessa experiência didática.
Experiência didática para a concentração: bonificação e desafios progressivos
O desenho dessa experiência didática começou ainda no ano de 2022, no primeiro ano do Ensino Médio. O fato de trabalhar com um grande contingente de alunos foi positivo para a negociação e implementação da proposta, uma vez que os alunos já estavam habituados à dinâmica das aulas do professor. Assim, no último trimestre de 2022, foi concedido um ponto bônus para os alunos que apresentassem suas anotações sistematizadas no caderno4 (incluindo aquelas que o professor escrevia no quadro durante as aulas).
Isso representou um reforço positivo para a execução de uma tarefa básica, compreendida como “obrigação dos alunos”, mas que não era exercida por grande parte do contingente. O ato de copiar as anotações do quadro foi entendido como um primeiro passo para maior aproximação dos alunos com a disciplina, como adaptado de Oliveira (1996). No contexto do trabalho antropológico, ao se observar etnograficamente uma sociedade analisada, o antropólogo escreve um diário de campo com sua experiência (Oliveira, 1996). Essa escrita é, em si, uma construção cognitiva. Isso significa que, ao escrever suas vivências, o pesquisador consegue compreender melhor algumas das situações observadas.
No ano de 2023, o contingente de alunos chegou ao segundo ano do Ensino Médio. O professor expôs aos alunos uma rotina contínua, voltada à consolidação da proposta, para as aulas de 40 minutos. Após a apresentação da turma, o professor passa a escrever o conteúdo no quadro. Entre 10 e 15 minutos de aula (a depender da quantidade de informação no quadro), o professor começa a ministrar o conteúdo. Nesse momento, os alunos devem estar com o quadro copiado e, dessa forma, será possível tomar notas das explicações do professor. Os 5 minutos finais da aula são reservados para conceder um carimbo no caderno dos alunos, o qual atesta a correta sistematização das anotações. Dessa forma, a efetiva explicação do professor tem a duração de 20 a 25 minutos. Esse é o tempo de plena atenção exigido dos alunos a cada aula5.
Os alunos que conseguiam todos os carimbos eram bonificados, com até um ponto na nota da primeira avaliação de cada trimestre. Na implementação dessa experiência didática, o nível de exigência do professor apresentou um aumento progressivo, ao longo do ano letivo. O primeiro trimestre representa uma fase de adaptação, onde os alunos ganham o carimbo anotando as escritas do quadro, aquelas realizadas no começo da aula e, ainda, aquelas realizadas durante a explicação. A meta seguinte é que os alunos comecem a tomar notas sistematizadas das explicações do professor. É esperado que o volume das anotações comece menor e aumente com a prática e com a concentração dos alunos. Ao final da aula, durante a conferência das anotações (abonamento com o carimbo), o professor avalia como está o desempenho individual dos alunos. Sem escrever durante a aula, os alunos erroneamente têm a impressão de que conseguiram fixar plenamente o conteúdo. Entretanto, como explicado acima, o processo de escrita não é somente de fixação das ideias. É sobretudo um processo de internalização do conteúdo aprendido.
Em busca de engajamento: ferramentas sociológicas numa redação do ENEM
Essa experiência didática sobre o aumento da capacidade de concentração esteve atrelada à disciplina de Sociologia. Portanto, ela é um caminho estabelecido pelo professor que, nesse primeiro contexto, apresenta resultados internos da própria disciplina. Um primeiro cenário de desafio a ser contornado está no fato de que um número relevante de alunos possui pré-noções negativas sobre a disciplina. Em busca de um engajamento maior da atenção dos alunos, uma das estratégias foi evidenciar ganhos instrumentais passíveis de materialização no desempenho escolar, para além da Sociologia. A ênfase na relação entre o bom uso das ferramentas sociológicas e uma melhora no repertório geral, habilidade fundamental para Redação, por exemplo, foi um dos incentivos para maior engajamento dos alunos.
Essa escolha também foi adotada com a análise de uma avaliação de concurso. O aluno Paulo Victor Rodrigues Mascarenhas prestou o Exame Nacional do Ensino Médio (ENEM) como treineiro6, ao final de 2022 (momento em que cursava o primeiro ano). O tema da redação do ENEM de 2022 foi: "Os desafios para a valorização de comunidades e povos tradicionais no Brasil". Toda sua argumentação foi baseada nos conteúdos sociológicos, especificamente no tópico sobre o nascimento da Antropologia. O aluno Mascarenhas atingiu a nota 960 na redação, alcançando a nota máxima em repertório. Dessa forma, essa redação tornou-se um ótimo exemplo para demonstrar como um aluno que prestou atenção nas aulas e seguiu adequadamente a experiência didática de tomar notas conseguiu esses excelentes resultados
Como vários alunos demonstraram dificuldades na compreensão desse processo de transformar um conteúdo sociológico em um texto dissertativo, tal qual cobrado no ENEM, esta seção do artigo é dedicada justamente a sua descrição. Quando discutimos o assunto em sala de aula, foi apresentado aos alunos o pensamento de Raymundo Nina Rodrigues. Como médico, escritor, antropólogo e etnólogo brasileiro, Nina Rodrigues possuía uma perspectiva baseada na antropometria. Os pesquisadores dessa linha de trabalho mediam os corpos e trabalhavam conceitos de “superioridade” e de “inferioridade” entre grupos humanos, utilizando características físicas (em especial a cor da pele). Essas práticas pseudocientíficas ficaram conhecidas como racismo científico.
Em seguida, falamos dos teóricos culturalistas. Primeiro Franz Uri Boas e depois de Gilberto de Mello Freyre. Gilberto Freyre tirou o sinal negativo da miscigenação no Brasil e destacou seus pontos positivos. Seus estudos representaram um verdadeiro alívio para a busca de imagens positivas do país. Entretanto, os estudos de Florestan Fernandes e de outros sociólogos paulistas mostraram que a ideia de uma suposta democracia racial era uma falácia7. Não se sustentava, a partir de relatos qualitativos e estatísticos sobre a situação dos negros no Brasil. Efetivamente, o racismo no Brasil foi percebido de maneira ambígua e geralmente do ponto de vista de pessoas brancas, mas não de pessoas negras.
E por que será que essa versão sobre democracia racial ainda é repetida por algumas pessoas, mesmo hoje em dia? O aluno Mascarenhas, em sua redação do ENEM (ver Apêndice), iniciou sua introdução falando de Franz Boas e do reconhecimento de que relações harmônicas entre diferentes culturas é extremamente positivo. Entretanto, não é isso que observamos na prática. Assim, em muitos países e inclusive no Brasil, são propostas reparações históricas. Mascarenhas introduziu a ideia de relativismo, ao fazer essas afirmações. No segundo parágrafo, o aluno citou Gilberto Freyre e seu extenso trabalho sobre a miscigenação no Brasil. O trabalho de Freyre facilitou a valorização das experiências dos povos tradicionais. Entretanto, e esse ponto está presente no terceiro parágrafo, somente com Florestan Fernandes ficou evidente o “tratamento de minoria” destinado historicamente aos povos tradicionais, no Brasil. Esse ponto acaba por contrapor o “mito da democracia racial” teoricamente presente no país. No parágrafo final, Mascarenhas faz a proposição de uma campanha de conscientização e da inclusão na Base Nacional Comum Curricular de conteúdos sobre a importância e valorização dos costumes e conhecimentos dos povos tradicionais. Dessa forma, segundo Mascarenhas, seria possível um maior intercâmbio de conhecimentos e a formação de um “país mais plural”.
Visando a estimular o senso crítico e o engajamento na resolução de problemas sociais, o ENEM opta por selecionar, como temas de suas redações, questões que envolvem os desafios atuais da sociedade brasileira. Uma vez que são as questões sociais o grande objeto das redações do ENEM, muitas das propostas de redação passam diretamente por áreas de estudo da Sociologia. Assim, o estudo dos autores clássicos da Sociologia é o estudo das bases fundadoras da disciplina. As teorias que se sucederam após Durkheim, Marx e Weber valeram-se, de forma mais ou menos evidente, das ferramentas de análise sociológica criadas por esses autores (Silva et al., 2017). Logo, o conhecimento de suas obras proporciona a habilidade de compreender as situações analisadas para que seja possível apontar suas possíveis causas, além de identificar e propor soluções.
A discussão de soluções é justamente a proposta de intervenção em consonância com os direitos humanos, exigida na conclusão das redações do ENEM, competência 5 da sua grade de correção, cujo valor quantitativo são 200/1000 pontos. Uma adequada proposta de intervenção exige mais do que um repertório sociocultural. Resolver um problema demanda não apenas seu real entendimento, mas também a compreensão do meio (ou seja, da sociedade) em que está presente. Embora a finalidade da intervenção possa ser clara, não é possível apontar um agente, uma ação e uma forma de executá-la sem que haja o conhecimento prévio das instituições sociais envolvidas, dos motivos históricos e das maneiras com que a questão é vivenciada individualmente. Atesta-se, por isso, as ferramentas sociológicas como peças essenciais na elaboração de uma boa redação.
Ademais, os conteúdos estudados na Sociologia podem ser diretamente utilizados para a construção da argumentação necessária a uma dissertação argumentativa. A exemplo da redação do aluno Mascarenhas, a escola culturalista é um excelente ponto de partida para temas que envolvam contato entre diferentes culturas. Paralelamente, a perspectiva de Florestan Fernandes, cuja outra vertente de pensamento permite uma contraposição de ideias positivas para o estudo do assunto, ajuda a situar as populações tradicionais como minorias, sendo possível compreender, portanto, um contexto de preconceito sobre seus hábitos de vida.
Ainda em relação ao tema da redação do ENEM aqui discutido (“Desafios para a valorização de comunidades e povos tradicionais no Brasil”), os conceitos de relativismo cultural (enriquecimento de discussões pelo contato de diferentes pensamentos e as condições para que fossem possíveis) fornece um caminho não só para argumentos, mas também para o embasamento de repertórios. Desde que se conheça contexto, conceito e autor, é possível reconhecer a situação em que se aplica uma teoria, relacioná-la a outras, utilizá-la como argumento e fundamentá-la na obra proposta pelo autor. Assim, satisfaz-se as competências 2 e 3 do ENEM: “Compreender o tema e não fugir do que é proposto” e “Selecionar, relacionar, organizar e interpretar informações, fatos, opiniões e argumentos em defesa de um ponto de vista”. Essas competências valem mais 400 pontos na nota dos candidatos.
Weber, Bourdieu e Freud: trilhas teóricas de uma experiência prática
A excelente nota da redação do aluno Mascarenhas resultou de competências e habilidades previamente constituídas. É importante frisar que essa performance não foi alcançada “por mágica”. Foi um processo facilitado por um contexto muito favorável. A habilidade de concentração é fundamental em nosso mundo competitivo. Weber tratou da ética ascética protestante, voltada ao trabalho, e relacionou-a ao incentivo para o desenvolvimento inicial do capitalismo (Silva et al., 2017). Ao fazer isso, Weber tratou de hábitos culturais que se alinhavam com práticas e uma perspectiva de mundo que proporcionaram aos protestantes maiores chances de sucesso no nascente mundo do capitalismo.
Isso quer dizer que, na média, os protestantes possuíam um incentivo cultural que lhes proporcionava um significativo impulso para o sucesso profissional. O ponto é: alguns contextos culturais e familiares incentivam os processos de desenvolvimento de habilidades, os quais auxiliam e facilitam o sucesso dentro da sociedade atual. Ou seja, alguns alunos conseguem desenvolver, dentro do ambiente familiar, uma elevada capacidade de concentração, além de outras habilidades e conhecimentos úteis para o sucesso profissional.
É importante reconhecer essa diferença quanto ao ponto de partida dos alunos. Como apontado por Bourdieu (2003), a escola é justamente o espaço em que essas habilidades podem ser trabalhadas, incentivadas e aumentadas. Segundo o autor, ignorar que os alunos chegam à escola com diferentes níveis de aquisição cultural e habilidades desenvolvidas é uma postura definitiva para o papel de reprodução das desigualdades já instituídas anteriormente (Bourdieu, 2003). Nesse sentido, nossa experiência didática visa possibilitar o desenvolvimento e o amadurecimento de alunos (mesmo em um cenário de desvantagem) e, ao mesmo tempo, incentivar o crescimento daqueles que já possuem vantagens comparativas. Isso se deve ao fato de que cada aluno é individualizado no seu processo de desenvolvimento, tendo a si mesmos como parâmetros de comparação.
É possível pensar sobre o processo de amadurecimento, a partir de dois conceitos de Freud (Psicanálise Clínica, 2017). São eles: o princípio da realidade e o princípio do prazer. O processo de amadurecimento acontece em meio às escolhas entre prazer e dor. Quando nascemos, desejamos só prazer. No processo de amadurecimento escolhemos abrir mão do prazer, em alguns momentos, para usufruir de um ganho futuro. Estudar e prestar atenção nas aulas exige esforço. Dormir mais cedo para não ter sono nas aulas exige esforço. Sentar para ver um vídeo no ambiente virtual disponibilizado pelo colégio exige esforço. Fazer e refazer exercícios das disciplinas exige esforço. Tudo isso faz parte da escolha dos alunos para uma carreira de sucesso no futuro.
Efetivamente, é normal e esperado que adolescentes desenvolvam habilidades diferentemente uns dos outros. Todos os alunos do Ensino Médio executam atividades nas quais conseguem se concentrar enormemente. A dificuldade é justamente conseguir se concentrar naquelas atividades que não desejam. Claro, gostar da área deixa tudo mais fácil. É mais difícil para alguns do que para outros conseguir se concentrar em algo que não é do seu interesse. E a escola é o lugar em que essas habilidades podem ser trabalhadas. Nesse experimento didático, o professor solicitou de 20 a 25 minutos de atenção plena na aula. Sabe-se que é um tempo curto, mas talvez seja um ponto de partida para a atual geração de estudantes.
Vivemos um processo contemporâneo em que muitas profissões estão desaparecendo, enquanto outras surgem. As habilidades para cada uma delas serão diferentes, mas podemos nos planejar, a partir da realidade atual. As escolhas feitas neste momento terão impactos em qualquer dos caminhos profissionais a serem seguidos pelos alunos. Obviamente, não são escolhas definitivas, mas que auxiliam e facilitam o alcance de metas desejadas.
Na perspectiva dos próprios alunos, houve relatos de melhora da compreensão dos conteúdos ministrados, além de percepções de que o esforço em anotar as explicações do professor aumentou a internalização do conteúdo. Isso ocorre uma vez que é necessário submeter as falas do professor a uma interpretação pessoal, a fim de adequadamente transformá-las num conjunto de anotações pessoais. Nesse sentido, foram especialmente interessantes as avaliações de que a nova maneira de se engajar na aula expandiu a noção de qual era a função do professor e o valor de racionalizar o conteúdo presencialmente.
Simultaneamente, o reforço do canal de comunicação oral gera mais intimidade entre discentes e docente do que a mera anotação do quadro, de forma a tornar a transmissão do conhecimento menos mecânica e mais efetiva. Dessa maneira, conceitos abstratos são melhor veiculados e apreendidos, dada a necessidade que os alunos têm de submeter essa informação a um crivo pessoal para decidir como anotá-la, ao invés de meramente copiar a ideia por extenso no papel. Essa conclusão é amparada nas considerações dos alunos que afirmaram compreender melhor a própria pessoa do professor e, assim, entenderam e se adequaram ao seu modo de lecionar.
Ademais, o esforço ativo de estar anotando uma informação coletada dinamicamente, ou seja, em uma aula sem possibilidade de repetição ou pausa, como no ambiente virtual, se mostra uma capacidade de grande importância para o desenvolvimento pessoal dos alunos, dado o contexto em que estão inseridos. Esse formato de aprendizado permite que dúvidas sejam tiradas de imediato e que o processo de aprendizagem seja menos solitário.
Até o final de 2023, observou-se um aumento significativo na capacidade de anotação dos alunos, incluindo aqueles que inicialmente afirmavam: “Professor, eu só consigo prestar atenção se eu não escrever”. Alguns alunos, inclusive, afirmavam que esse era um exercício que funcionaria somente para os alunos que já obtinham boas notas. Entretanto, como o professor avaliava e incentivava os alunos individualmente, cada um deles tinha a si mesmo como parâmetro de comparação. Dessa forma, foi possível verificar um incremento nas anotações, ao mesmo tempo em que havia um aumento progressivo da dificuldade - enquanto no início os ganhos eram por anotações diretas do quadro, no trimestre final exigia-se o registro elaborado das ideias apresentadas. Cerca de metade dos alunos de cada turma atingiu os critérios avançados nos segundo e terceiro trimestres.
CONSIDERAÇÕES FINAIS
Após a conclusão de um ciclo completo foi possível perceber resultados muito positivos dessa experiência didática. A proposta de aumento da concentração dos alunos, baseada nas anotações ativas com reforço positivo e progressão das dificuldades, ganhou mais alunos adeptos, ao longo do ano escolar. A metodologia mostrou-se especialmente relevante no contexto atual de tecnologias digitais. A transição gradual de anotações do quadro para conteúdos orais transformou a aprendizagem em um processo mais reflexivo, conforme atestado pelos alunos.
Assim, a experiência mostrou-se promissora para o amadurecimento estudantil não apenas na disciplina de Sociologia. Portanto, espera-se que a ampliação dos mecanismos fixadores de aprendizado pelos alunos melhore o rendimento nos estudos e nas avaliações.
Por fim, a experiência reforça o papel da escola como espaço fundamental para o desenvolvimento de habilidades cognitivas essenciais. A abordagem baseada em princípios sociológicos e psicológicos demonstrou potencial para utilização em outras disciplinas curriculares. A combinação de exigência progressiva, incentivos e acompanhamento individual demonstrou ser um método capaz de preparar os estudantes para desafios futuros.
AGRADECIMENTOS
Os autores são gratos aos professores Leidiane da Silva Carvalho de Souza, Carlos Eduardo Rocha Laureti e Matheus Batista Firmato de Almeida pelas inspirações pedagógicas que tornaram possíveis o presente trabalho.
REFERÊNCIAS
BOURDIEU, P. (2003) A escola conservadora: as desigualdades frente à escola e à cultura. In : Escritos de Educação . Petrópolis: Vozes, p. 41-64.
GEERTZ, C. (1978) O impacto do conceito de cultura sobre o conceito de homem. In : A interpretação das culturas . Rio de Janeiro: Zahar.
LEVY, P. (2010) Cibercultura. Rio de Janeiro: Editora 34.
MAIO, M. C. (1999) O projeto UNESCO e a agenda de ciências sociais no Brasil nos anos 40 e 50. Revista Brasileira de Ciências Sociais, v. 14, p. 141-158.
NOGUEIRA, O. (2007) Preconceito racial de marca e preconceito racial de origem: sugestão de um quadro de referência para a interpretação do material sobre relações raciais no Brasil. Tempo Social, v. 19, n. 1, p. 287-308.
OLIVEIRA, R. C. (1996) O trabalho do antropólogo: olhar, ouvir, escrever. Revista de Antropologia, v. 39, n. 1, p. 13-37.
ONG, W. (1998) Oralidade e cultura escrita. Campinas, SP: Papirus.
PSICANÁLISE CLÍNICA (2017) Princípio do Prazer e da Realidade para Freud. Disponível em: <https://www.psicanaliseclinica.com/principio-do-prazer-realidade/> Acesso em: 13 jun. 2023.
SILVA, A.; LOUREIRO, B.; MIRANDA, C.; et al. (2017) Sociologia em movimento. São Paulo: Editora Moderna.
_______________________________________________
1Professor de Sociologia (CMB), Doutor em Antropologia Social (UnB). Email:
2Aluno do Colégio Militar de Brasília (CMB)
3Como uma referência de contexto histórico a longo prazo, é importante lembrar que a paciência e a concentração são características fundamentais da espécie humana em termos evolutivos. Geertz (1978) nos lembra que o desenvolvimento do sistema nervoso central foi crucial para a nossa sobrevivência como espécie. Em tempos recentes, é simples apontar que o trabalho científico necessita do exercício contínuo da paciência e do foco, uma vez que os resultados das pesquisas podem levar muitos anos. Nesse sentido, todo o trabalho científico é baseado na paciência e na concentração dos muitos pesquisadores que se sucederam, ao longo da história.
4Essa prática docente foi inspirada em experiências já implementadas nas disciplinas de História e de Geografia, no mesmo ano letivo.
5O quadro é um recurso didático utilizado há séculos. A disponibilização do conteúdo no quadro com o uso de diferentes cores - para as anotações do começo da aula e para aquelas advindas das explicações do professor - mostrou-se bastante eficiente na implementação da experiência didática.
6Um treineiro é um candidato que realiza o ENEM, antes de concluir o Ensino Médio.
7Na Segunda Guerra mundial aconteceu um genocídio com os judeus. O conceito de genocídio foi criado justamente nesse contexto. Uma das medidas da UNESCO foi incentivar a disseminação de conceitos como o relativismo cultural, o qual representa uma forma de enxergar culturas diferentes de forma não preconceituosa e, consequentemente, minimizar os riscos de comportamentos intolerantes (como os que acabavam de ocorrer com os judeus). Um primeiro olhar estrangeiro tinha a esperança de encontrar, no Brasil, um país exemplo de relações raciais saudáveis. Entretanto, pesquisas da década de 1950 comprovaram a existência de racismo no Brasil. Um dos grandes achados foi que, no Brasil, o racismo se manifesta de forma diferente em relação a outros países. Nogueira (2007) utilizou os conceitos “preconceito de marca” e “preconceito de origem” para diferenciar Brasil e Estados Unidos da América, nesse aspecto. Sobre o projeto da UNESCO ver Maio (1999).
APÊNDICE:
Redação ENEM 2022
Candidato: Paulo Victor Rodrigues Mascarenhas.
Tema: “Desafios para a valorização de comunidades e povos tradicionais no Brasil”.
Desde a consolidação, no século passado, da escola culturalista de sociologia, fundada pelo francês (sic) Franz Boas, é amplamente reconhecido na comunidade científica que o contato harmonioso entre duas culturas é positivo para os integrantes de ambas. Contudo, esse consenso não se reflete nas políticas governamentais, as quais suprimem minorias tradicionais no Brasil e desprezam chances de dialogar sobre temas de preocupação global, como o desmatamento, com aqueles que deles são mais próximos. Urge, então, a análise do que é perdido e das causas da situação, com a finalidade de repará-la.
Primeiramente, conforme o sociólogo brasileiro de destaque internacional Gilberto Freyre, culturalista, a miscigenação de etnias fornece um ambiente mais fértil para o desenvolvimento de soluções inclusivas e eficazes de problemas, os quais são vivenciados de formas distintas por diferentes povos. No Brasil, em especial em aquilo que tange ao meio ambiente, os grupos tradicionais oferecem experiências singulares e indispensáveis para a superação dos obstáculos. Entretanto, essa plataforma de diálogo depende de condições só notadas por um sucessor de Freyre.
Em segundo lugar, é essencial para que a simbiose cultural ocorra a representação igual de todos os envolvidos. Isso foi apontado por Florestan Fernandes, pesquisador do racismo no país, quem (sic) derrubou o mito da “democracia racial” brasileira proposto por Gilberto. Florestan mostrou que a formação histórica da nação situou populações, a exemplo dos povos tradicionais, como minorias. Assim, a maioria governante oprime-as e elas não têm voz para sequer serem conhecidas pelo restante da população. Esse processo culmina, finalmente, em suas extinções e na consequente perda de sabedoria ancestral. Portanto, é urgente que haja intervenção nele.
À luz do acima exposto, torna-se imperiosa a ação do Governo federal, na figura do Ministério da Educação, de conscientizar os jovens, base formadora da sociedade, sobre a existência, os costumes e a importância das comunidades e povos tradicionais no Brasil. Isso deve ser feito por meio do aumento na Base Nacional Curricular Comum (sic) da previsão de ensino sobre os grupos tradicionais, a fim de prevenir a perda de seus conhecimentos e potencializar o intercâmbio desses. Então, criar-se-á um país mais plural, com maior identidade nacional e capaz de resolver as questões ambientais que não só lhe são, mas também são ao mundo, tão relevantes.


